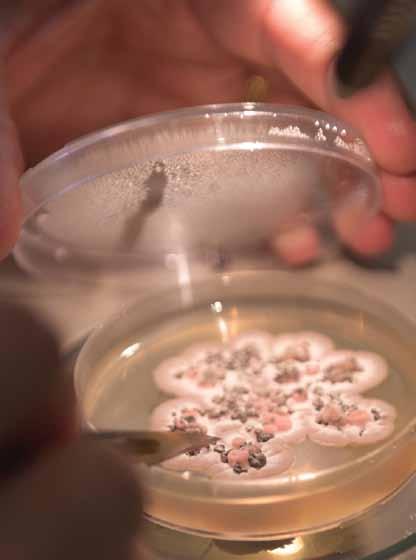
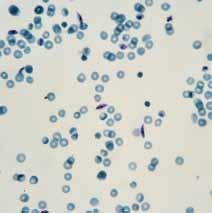

2015
Academic Achievers’ Awards
Toekennings vir Akademiese Presteerders
Difoka tša Thuto tša Bao ba Atlegilego






The University of Pretoria congratulates all our academics who have shown exceptional academic achievement in 2014.




Contents | Inhoud | Diteng
Individual winner | Individuele wenner | Mofenyi yo motee
Professor Tania Hanekom
Bou-omgewing en Inligtingtegnologie | Lefapha la Boentšenere, Tikologokago le
Team
| Spanwenners | Bafenyi ba sehlopha
Ms Thea Corbett | Ms Christine Kraamwinkel
Contents | Inhoud | Diteng
Community Engagement Award | Toekenning vir Gemeenskapsbetrokkenheid | Sefoka sa Tlemagano
2015 NRF-rated Researchers | 2015 NNS-gegradeerde Navorsers | Banyakišiši ba 2015 bao ba lekaneditšwego ke Motheo wa Dinyakišišo wa Setšhaba
New 2015 A-rated Researchers | Nuwe 2015 A-gegradeerde Navorsers | Banyakišiši ba baswa ba 2015 bao ba lekaneditšwego maemong a A
Other 2015 NRF ratings | Ander 2015 NNS-graderings | Ditekanetšo tše dingwe tša 2015 tša Motheo wa

Contents | Inhoud | Diteng
Professor
Professor
Professor




Contents | Inhoud | Diteng

Welcome | Verwelkoming | Kamogelo

Professor Cheryl de la Rey
Vice-Chancellor and Principal, University of Pretoria
Visekanselier en Rektor, Universiteit van Pretoria Motlatšamokhanseliri le Hlogo, Yunibesithi ya Pretoria
April has become a month dedicated to the celebration of achievement at the University of Pretoria. In the month of April each year the University convenes more than 20 graduation ceremonies with all our nine faculties taking pride in the achievements of their students. It is heartening to know that by the end of April this year we will have held 23 ceremonies where we will have graduated close to 10 000 new graduates, each of whom will be going out into the world to make their mark. In recent years we have seen it fitting to add to the April celebrations a special gala occasion to pay tribute to our academics who have shown exceptional achievement in the preceding year. Since we began this tradition a few years ago, the annual Academic Achievers Awards have become one of the highlights of the University of Pretoria’s academic year.
In acknowledgement of the multi-faceted nature of academic careers, two new award categories have been added this year, the Vice-Chancellor’s Book Award and an award to recognise innovative community engagement. The Chancellor’s Awards and the Exceptional Academic Achievers Awards are intended for those who are already at the highest level of the academic hierarchy whereas the Exceptional Young Researcher Awards are for colleagues who have been identified as “rising stars”. Achievement in the specific areas of teaching and learning and research are recognised via the Education Innovation Laureate Awards and the National Research Foundation’s (NRF) rating system respectively.
On behalf of the University I wish to congratulate each academic featured in this publication. Your achievements contribute significantly to widespread national and international recognition that the University of Pretoria is an institution of excellence. Collectively you reflect the breadth and depth of scholarly work at the University across nine faculties and our business school GIBS. You are a source of great pride to the University of Pretoria. We salute your achievements! May you remain inspired to continue contributing to the generation of new knowledge and the development of future generations of professionals and leaders.
By die Universiteit van Pretoria wy ons die maand April aan die viering van verskeie prestasies . Elke jaar in April bied die Universiteit meer as 20 gradeplegtighede aan waar al nege ons fakulteite met trots die prestasies van hul studente erken. Dit is verblydend om te weet dat daar teen die einde van April vanjaar reeds by 23 sulke plegtighede grade en diplomas toegeken sal wees aan bykans 10 000 nuwe graduandi wat almal hul stempel in die wêreld daar buite gaan afdruk. Die afgelope paar jaar het ons dit ook goed gedink om die bestaande April-vieringe uit te brei deur ’n spesiale gala-geleentheid te hou om ons akademici wat in die voorafgaande jaar uitsonderlik presteer het, te vereer. Sedert ons ’n paar jaar gelede met hierdie tradisie begin het, het die jaarlikse Toekennings vir Akademiese Presteerders een van die hoogtepunte van die Universiteit van Pretoria se akademiese jaar geword.
Om erkenning te verleen aan die feit dat ʼn akademiese loopbaan vele fasette behels, is daar vanjaar twee nuwe kategorieë toekennings ingestel, naamlik die Visekanseliersboektoekenning en ’n toekenning ter erkenning van innoverende gemeenskapsbetrokkenheid. Die bestaande Kanselierstoekennings en die Toekennings vir Uitnemende Akademiese Presteerders is bedoel vir diegene wat reeds die hoogste vlak van die akademiese hiërargie bereik het, terwyl die Toekennings vir Uitnemende Jong Navorsers gaan aan kollegas wat as ontluikende uitblinkers (“rising stars”) geïdentifiseer is. Prestasie op die spesifieke gebiede van onderrig en leer en navorsing word onderskeidelik deur die Laureaattoekennings vir Onderwysinnovasie en die Nasionale Navorsingstigting (NNS) se graderingstelsel erken.
Namens die Universiteit wens ek elke akademikus geluk wat in hierdie publikasie vermeld word. U prestasies lewer ’n beduidende bydrae tot wye nasionale en internasionale erkenning dat die Universiteit van Pretoria ’n instelling van uitnemendheid is. Gesamentlik weerspieël u werk die omvang en grondige fokus van die akademiese aktiwiteite van die Universiteit in sy nege fakulteite en ons sakeskool, GIBS. Die Universiteit van Pretoria is baie trots op u en huldig graag u besondere prestasies! Ons vertrou dat u steeds besiel sal bly om verder tot die skep van nuwe kennis en die ontwikkeling van toekomstige geslagte beroepslui en leiers by te dra.
Mo kgweding ya Moranang ngwaga wo mongwe le wo mongwe Yunibesithi e swara meletlo ya dialoga ya go feta ye 20 mo mafapheng a rena ka moka a senyane ao a ikgantšhago ka dikatlego tša baithuti ba wona. Go a thabiša go tseba gore mafelelong a Moranang ngwageng wo re tla ba re swere meletlo ye 23 moo re tla bego re alošitše dialoga tša go batemela 10 000 tše diswa, wo mongwe le wo mongwe wa bona o tla ba a tšwela ka ntle lefaseng go dira seka. Mo mengwageng ya bjale re bone go swanela go oketša mo meketekong ya Moranang tiragalo ya go ikgetha ya gala go hlompha dirutegi tša rena tšeo di bontšhitšego dikatlego tše dikgolo kudu mo mengwageng ya go feta. Ka ge re thomile setšo se mengwaga ye mmalwa ya go feta, Difoka tša ngwaga le ngwaga tša Bašomedi bao ba Atlagilego di bile tše dingwe tša dintlhakgolo tša ngwaga wa dithuto wa Yunibesithi ya Pretoria.
Go amogela mehuta yeo e fapanego ya mešomo ya thuto, ngwaga wo go okeditšwe ka magoro a mabedi a difoka a maswa, Difoka tša Dipuku tša Motlatšamokhanseliri le sefoka sa go lemoga tšweletšopele ya go tšea karolo setšhabeng. Difoka tša Mokhanseliri le Difoka tša Bašomedi bao ba Atlegilego kudu di lebeletše bao ba šetšego ba le legatong la godimo la manamelelo a thuto, mola Difoka tša Banyakišiši ba Baswa bao ba Atlegilego kudu di eya go badirišane ba go ruta bao ba hlaotšwego bjalo ka “dinaletšana tšeo di golago”. Dikatlego dikarolong tšeo di itšego tša go ruta le go ithuta le dinyakišišo di lemogwa mmogo ka tsela ya Difoka tša Tšweletšopele ya Thuto tša Laureate le tekanyetšo ya Motheo wa Dinyakišišo wa Setšhaba.
Legatong la Yunibesithi Ke rata go lebogiša serutegi se sengwe le se sengwe seo se akareditšwego kgatišong ye. Dikatlego tša lena di kgatha tema ye kgolo ka bophara go lemogweng maemong a setšhaba le a ditšhabatšhaba gore Yunibesithi ya Pretoria ke institušene ya bokgoni. Mmogo le tšweletša mošomo wa thuto ka bophara le botebo mo Yunibesithi mo mafapheng a senyane le sekolong sa yona sa kgwebo GIBS. Le mothopo wa boikgantšho bjo bogolo go Yunibesithi ya Pretoria. Re hlompha dikatlego tša lena! Le kgopelwa go tšwela pele go tšweletša tsebo ye mpsha gomme le godiše tšweletšopele ya moloko wa ka moso wa dirutegi le baetapele.
Chancellor’s Award: Research Kanseliersmedalje: Navorsing
Medale
wa Mokhanseliri: Dinyakišišo
The Chancellor’s Award is made in recognition of exceptional achievement in the field of research aimed at the advancement of science and the associated promotion of the interests of the University of Pretoria.
Die Kanselierstoekenning word gemaak vir uitnemende prestasie op navorsingsgebied ter bevordering van die wetenskap en sodoende ook die belange van die Universiteit van Pretoria.
Sefoka sa Mokhanseliri se diretšwe go leboga phihlelelo ya go tšwelela ka magetla mosomong wa bonyakišiši woo maikemišetšo a wona e lego go hlabolla le go godiša dikgahlego tša Yunibesithi ya Pretoria.

Professor Cowan is the Director of both the Genomics Research Institute and the Centre for Microbial Ecology and Genomics. He conducts research on microbial ecology, microbial genomics and applied microbiology, and he and his team use genomic and metagenomic methods to gain an understanding of the diversity and function of microorganisms in different environments. Much of his research focuses on the microbiology of extreme environments, including hot (Namib) and cold (Antarctic) desert soils. He collaborates with many other research laboratories in South Africa and across the world, including Namibia, Kenya, Zambia, Spain, Argentina, Australia, New Zealand, the UK, Germany and the USA. He has supervised research on the rhizospheric zones of economic crop plant species, peat-bogs in southern Argentina and endophytes of the enigmatic Welwitschia and other endemic south-west African plant species.
Professor Cowan has published more than 275 research papers, review articles and chapters in books, and serves on the editorial boards of 12 international journals. He has an h-index of 35 (ISI Web of Science) and is listed among the top 1% of international researchers in Thompson’s ISI Essential Science Indicator.
In the course of his career he has successfully supervised 28 PhD and 38 MSc students. He currently supervises a research team consisting of four research fellows, 11 postdoctoral researchers, nine PhD and five MSc students. Professor Cowan holds the post of adjunct professor at the University of Waikato (NZ), was elected as a fellow of the Royal Society of South Africa in 2007, as a member of the Academy of Sciences of South Africa in 2008, and as an honorary fellow of the Royal Society of New Zealand in 2009. He was awarded the University of the Western Cape (UWC) Vice-Rector’s Award for Research Excellence in 2008, the South African Society for Microbiology Medal for Research Excellence in 2009 and the National Science and Technology Forum’s Capacity Development award in 2014. He is the immediate past president of the Royal Society of South Africa. Professor Cowan received an A rating from the NRF in 2013.
Professor Cowan is die Direkteur van sowel die Genomikanavorsingsinstituut as die Sentrum vir Mikrobiese Ekologie en Genomika. Hy doen navorsing oor mikrobiese ekologie, mikrobiese genomika en toegepaste mikrobiologie, en hy en sy span gebruik genomiese en metagenomiese metodes om ʼn begrip van die diversiteit en funksie van mikro-organismes in verskillende omgewings te verkry. Baie van sy navorsing fokus op die mikrobiologie van ekstreme omgewings, soos warm (Namib) en koue (Antarktika) woestyngrond. Hy werk saam met baie ander navorsingslaboratoriums in Suid-Afrika en dwarsoor die wêreld, insluitende Namibië, Kenia, Zambië, Spanje, Argentinië, Australië, Nieu-Seeland, die VK, Duitsland en die VSA. Hy staan aan die hoof van navorsing oor die risosferiese sones van ekonomiese gewasplantspesies, veenmoerasse in die suide van Argentinië en endofiete van die enigmatiese Welwitschia en ander endemiese plantspesies in die suidweste van Afrika.
Professor Cowan het reeds meer as 275 navorsingsreferate, oorsigartikels en hoofstukke in boeke gepubliseer, en dien in die redaksiekomitees van 12 internasionale joernale. Hy het ‘n h-indeks van 35 (ISI Web of Science) en tel onder die top 1% van internasionale navorsers soos gelys in Thompson se ISI Essential Science Indicator.
In sy loopbaan het hy reeds suksesvol as studieleier vir 28 PhD- en 38 MSc-studente opgetree. Hy is tans studieleier vir ‘n navorsingspan bestaande uit vier navorsingsgenote, 11 nadoktorale navorsers, en nege PhD- en vyf MSc-studente. Professor Cowan beklee die pos van adjunkprofessor aan die Universiteit van Waikato in Nieu-Seeland, is in 2007 gekies as genoot van die Royal Society of South Africa, in 2008 as lid van die Academy of Sciences of South Africa, en in 2009 as ‘n eregenoot van die Royal Society of New Zealand. In 2008 is die Universiteit van die Wes-Kaap se Viserektorstoekenning vir Navorsingsuitnemendheid aan hom toegeken, in 2009 die SuidAfrikaanse Vereniging vir Mikrobiologie se Medalje vir Navorsingsuitnemendheid, en in 2014 die Nasionale Wetenskap- en Tegnologieforum se toekenning vir Kapasiteitontwikkeling. Hy is die vorige president van die Royal Society of South Africa. Professor Cowan het in 2013 ‘n A-gradering van die NNS ontvang.
Profesa Cowan ke Molaodimogolo wa bobedi Institute ya Dinyakišišo ya Ditšenomiki le Senthara ya Ekolotši ya Maekropaele le Ditšenomiki.
O dira dinyakišišo ka makaleng a ekolotši ya maekropaele, ditšenomiki tša maekropaele le maekropayolotši ya tirišo, gomme yena le sehlopha sa gagwe ba šomiša mekgwa ya ditšenomiki le metatšenomiki kwešiša phapano le mošomo wa diphedinyana tše nnyane ditikologong tša go fapana. Bogolo bja dinyakišišo tša gagwe bo nepiša maekropayolotši ya ditikologo tše di lego kotsi, go akaretšwa mabu a leganata la go fiša (Namib) le go tonya (Anthakthiki). O šomišana le dilaporatori tše dingwe tše ntši tša dinyakišišo ka Afrika Borwa le dinaga tše dingwe go kgabaganya lefase, go akaretšwa Namibia, Kenya, Zambia, Spain, Argentina, Australia, New Zealand, UK, Germany le USA. O hlahlile dinyakišišo ka ga mafelo a rizosferiki a mehuta ya dimela tša puno ya ekonomi, mafelo a dimela tše di bolago ka borwa bja Argentina le endofaetse ya Welwitschia ye e sa tsebjego le mehuta ye mengwe yeo e tsebegago ya mehuta ya dimela tša borwa-bodikela bja Afrika.
Profesa Cowan o phatlaladitše dipampiri tša dinyakišišo tša go feta 260, diathekele tša tshekatsheko le dikgaolo ka dipukung, gape o šoma dibotong tša borulaganyi tša dijenale tša ditšhabatšhaba tše 12. O na le tšhupane ya h ya 34 (Wepo ya ISI ya Saense) gape o lenaneong la ba magareng a 1% la diketapele tša banyakišiši ka ISI Essential Science Indicator ya Thompson. Kgabagareng ya mošomo wa gagwe o hlahlile ka katlego baithuti ba 28 ba PhD le ba 36 ba MSc. Ka se sebaka o lekola sehlopha sa dinyakišišo sa go bopša ke badirišane ba dinyakišišo ba bane, banyakišiši ba 11 ba morago ga tikrii ya bongaka, le ba senyane ba PhD le ba bahlano ba MSc.
Profesa Cowan o swere maemo a Mothuša-Profesa Yunibesithing ya Waikato (NZ), o kgethilwe bjalo ka Modirišane wa Mokgatlo wa Bogoši wa Afrika Borwa ka 2007, bjalo ka Leloko la Akademi ya Disaense ya Afrika Borwa ka 2008, le Modirišane wa tlhompho wa Mokgatlo wa Bogoši wa New Zealand ka 2009. O abetšwe Sefoka sa Yunibesithi ya Western Cape (UWC) sa Motlatša-Morektoro sa Bokgoni bja Dinyakišišo ka 2008, Mokgatlo wa Afrika Borwa wa Metale wa Maekropayolotši wa Bokgoni go Dinyakišišo ka 2009 le sefoka sa Tlhabollo ya Bokgoni sa Foramo ya Bosetšhaba ya Saense le Theknolotši ka 2014. Ke Mopresidente wa bjale wa Mokgatlo wa Bogoši wa Afrika Borwa. Profesa Cowan o abetšwe maemo a A go tšwa NRF ka 2013.
Professor Don Cowan

Vice-Chancellor’s Book Awards 2014 Visiekanselier se Boektoekennings 2014
Difoka tša Puku tša Motlatšamokhanseliri
The University of Pretoria introduced the Vice-Chancellor’s Book Awards to recognise and reward authors of scholarly books, monographs and collections. The prizes are awarded once a year in two categories, namely humanities and social sciences (broadly defined) and natural and applied sciences. Two awards are made each year, provided that books of sufficient merit have been nominated. A book is considered to be scholarly if it presents the findings of an original, systematic investigation undertaken to gain new knowledge and insight, advances knowledge in a particular discipline and brings credit to the University. Scholarly books may be written in any of South Africa’s official languages and translations of major works originally published in other languages are also considered. In order to qualify for nomination, books should bring credit to the University on account of their contribution to the advancement of the humanities, the social sciences or the natural and applied sciences.
Die Universiteit van Pretoria het die Visekanselier se Boektoekennings ingestel om skrywers van akademiese boeke, monografieë en versamelings te erken en te beloon. Die pryse word een keer per jaar in twee kategorieë toegeken, naamlik geesteswetenskappe en sosiale wetenskappe (breed gedefinieer) en natuur- en toegepaste wetenskappe. Twee toekennings word elke jaar gemaak, mits boeke van voldoende verdienstelikheid benoem is. ’n Boek word as akademies beskou as dit die bevindings van ’n oorspronklike, stelselmatige ondersoek voorhou wat gedoen is om nuwe kennis en insig te verkry, kennis op ’n bepaalde vakgebied uitbrei en die Universiteit eer aandoen. Akademiese boeke kan in enige van Suid-Afrika se amptelike tale geskryf wees en vertalings van omvangryke werke wat oorspronklik in ander tale uitgegee is, word ook oorweeg. Om vir benoeming in aanmerking te kom, moet boeke die Universiteit eer aandoen op grond van hul bydrae tot die vooruitgang van die geesteswetenskappe, die sosiale wetenskappe of die natuur- en toegepaste wetenskappe.
Yunibesithi ya Pretoria e tsebagaditše Difoka tša Dipuku tša Motlatšamokhanseliri go lemoga le go leboga bangwadi ba dipuku tša thuto, ditaodišo le dikgoboketšo. Difoka di abja gatee mo ngwageng ka magoro a mabedi, e lego, la bomotho le disaense tša leago (e hlalošwago ka bophara) le disaense tša tlhago le tirišo. Difoka tše pedi di dirwa ngwaga wo mongwe le wo mongwe, ge fela dipuku tša bokgoni di kgethilwe. Puku e tšewa goba ya thuto ge e tšweletša dikutollo tša mathomong, dinyakišišo tša peakanyo di dirilwe go hwetša tsebo ye mpsha le kwešišo, tsebo ye e tšweletšego mo karolong ye e itšego gomme ya tumiša Yunibesithi. Dipuku tša thuto di ka ngwalwa ka dipolelo tša semmušo tša Afrika Borwa gomme diphetolelo tša mošomo wo mogolo woo mathomong o phatlaladitšwego ka dipolelo tše dingwe le tšona di a lebedišišwa. Gore o be le maswanedi a go kgethwa, dipuku di swanetše go tumiša Yunibesithi mo go tšeeng karolo ga yona go tšweletšopele ya bomotho, disaense tša leago goba disaense tša tlhago le tirišo.


Gross Domestic Problem
This book, which deals with a central issue of the day, and possibly of the 21st century, provides a critical analysis of the discourse and history of a concept that is vital to economics and how we think about the global society and its wellbeing. Gross domestic problem is a timely publication and while it reveals deep scholarly strength, it is also accessible and shows bothhumour and passion.
About the author
Professor Lorenzo Fioramonti is a professor of Political Economy in the Department of Political Sciences in the Faculty of Humanities and Director of the Centre for the Study of Governance Innovation (GovInn). He is also a senior fellow at the University of Heidelberg, the Hertie School of Governance and the United Nations University (UNU). Professor Fioramonti, who is the president of the European Union Studies Association of Sub-Saharan Africa, is the incumbent of the first and only Jean Monnet Chair in Africa and also holds a UNESCO-UNU Chair in Regional Integration, Migration and Free Movement of People. In 2012, he received a University of Pretoria (UP) Exceptional Young Achiever Award. His most recent books are How numbers rule the world: the use and abuse of statistics in global politics (Zed Books, 2014) and Gross domestic problem: the politics behind the world’s most powerful number (Zed Books, 2013), which have sold over 10 000 copies. His opinion pieces have been published by, among others, The New York Times, Foreign Policy and Harvard Business Review. He writes has a regular column in Business Day
Gross Domestic Problem
Hierdie boek, wat oor ’n sentrale kwessie van vandag, en moontlik van die 21ste eeu, handel, bied ’n kritiese ontleding van die diskoers en geskiedenis van ’n konsep wat van groot belang is vir ekonomie en hoe ons oor die wêreldsamelewing en die welstand van daardie samelewing dink. Gross domestic problem is ’n tydige publikasie, en terwyl dit diep akademiese sterkte openbaar, is dit ook toeganklik en toon dit sowel humor as passie.
Oor die skrywer
Professor Lorenzo Fioramonti is ’n professor in Politieke Ekonomie in die Departement Politieke Wetenskappe in die Fakulteit Geesteswetenskappe en die Direkteur van die Sentrum vir die Studie van Bestuur-en-beheerinnovasie (GovInn). Hy is ’n senior genoot by die Universiteit van Heidelberg, die Hertie-bestuurskool en die Verenigde Nasies-universiteit UNU). Professor Fioramonti, wat die president van die Europese Unie se Studievereniging (European Union Studies Association) van Afrika Suid van die Sahara is, is die bekleër van die eerste en enigste Jean Monnet-leerstoel in Afrika, en van ʼn UNESCO-UNU-leerstoel in Streekintegrasie, Migrasie en die Vrye Beweging van Mense. In 2012 het hy ’n Uitnemende Jong Presteerder-toekenning van die Universiteit van Pretoria (UP) ontvang. Sy mees onlangse boeke is How numbers rule the world: the use and abuse of statistics in global politics (Zed Books, 2014) en Gross domestic problem: the politics behind the world’s most powerful number (Zed Books, 2013), waarvan meer as 10 000 kopieë verkoop is. Sy rubrieke is al in onder andere The New York Times, Foreign Policy en Harvard Business Review gepubliseer. Hy is die skrywer van ’n gereelde rubriek in Business Day.
Gross Domestic Problem
Puku ye, yeo e šoganago le taba ya gare ya letšatši, gape le kgonagalo ya kgolo ya bo 21, e fa tshekatsheko ye e tseneletšego ya polelo le histori ya kgopolo yeo e lego bohlokwa mo diekonoming le ka moo re naganago ka setšhaba sa lefase le go phela gabotse ga sona. Gross domestic problem ke phatlalatšo ya maleba gomme e utolla bokgoni bjo bo tseneletšego bja thuto, gape e a fihlelelwa gomme e bontšha tshegišo le phišego.
Ka ga mongwadi
Moprofesa Lorenzo Fioramonti ke moprofesa wa Ekonomi ya Sepolotiki ka gare ga Kgoro ya Disaense tša Sepolotiki ka Lefapheng la Bomotho ebile ke Molaodimogolo wa Senthara ya Dithuto tša Taolo ya Tšweletšopele. Gape ke mogweramoleloko yo mogolo Yunibesithing ya Heidelberg, Sekolo sa Pušo sa Hertie le Yunibesithing ya United Nations (UNU). Moprofesa Fioramonti, yoo e lego mopresidente wa Mokgatlo wa Dithuto wa Kopano ya Yuropa wa Borwa bja Afrika, e bile ke mohlankedi a le tee wa Setulo sa Jean Monnet ka Afrika gape o tsokame Setulo sa UNESCO-UNU ka Kopantšho ya Selete, Khudugo le Mosepelo wa Tokologo wa Batho. Ka 2012, o amogetše Sefoka sa Mokgoni yo Mokaone yo Monnyane sa Yunibesithi ya Pretoria. Dipuku tša gagwe tša kgauswinyana mo ke How numbers rule the world: the use and abuse of statistics in global politics (Zed Books, 2014) le Gross domestic problem: the politics behind the world’s most powerful number (Zed Books, 2013), tšeo di rekišitšego dikhopi tša go feta tše 10 000. Dingwalwakgopolo tša gagwe di gatišitšwe ke, magareng ga ba bangwe, The New York Times, Foreign Policy le Harvard Business Review. O ngwala dikholomo kgafetša ka gare ga Business Day
Professor Lorenzo Fioramonti | Humanities and Social Sciences | Geesteswetenskappe en Sosiale Wetenskappe | Disaense tša Bomotho le Leago


The Chemistry of Matter Waves
This is the latest and most recently updated in a series of books and publications in which Professor Boeyens presents the case for a new approach to the quantum description of chemistry. It offers an in-depth, scholarly study of the relevant literature and reveals that many famous scientists have been misquoted in textbooks and have even been misinterpreted by other scientists. To describe this book as revolutionary will certainly not be an exaggeration.
About the author
Professor Jan Boeyens retired from the University of the Witwatersrand after serving 20 years as an ad hominem professor of Theoretical Chemistry and one term as Dean of Science. He was re-appointed by the University of Pretoria as a professor and Head of the Department of Chemistry and, more recently, as an extraordinary professor and senior research fellow in the Centre for the Advancement of Scholarship.
Before his retirement he was actively involved in research in chemical crystallography and the theory of molecular structure, which failed to produce the fundamental answer that he was seeking. Since his retirement he has been spending what he refers to as his ‘second childhood’ making a more determined effort to understand the nature of space-time and matter. He has reached the point where he has recognised the traditional formulation of quantum mechanics as the major stumbling block. His progress is documented in six monographs, of which the most recent has earned him this award.
The Chemistry of Matter Waves
Dit is die jongste en mees onlangs bygewerkte in ’n reeks boeke en publikasies waarin professor Boeyens die saak stel vir ’n nuwe benadering tot die kwantumbeskrywing van chemie. Dit bied ’n diepgaande akademiese studie van die tersaaklike literatuur en onthul dat talle beroemde wetenskaplikes verkeerd aangehaal is in handboeke en selfs verkeerd vertolk is deur ander wetenskaplikes. Om hierdie boek as revolusionêr te bestempel, sal beslis nie ’n oordrywing wees nie.
Oor die skrywer
Professor Jan Boeyens het na 20 jaar diens as ’n ad hominem-professor in Teoretiese Chemie en een termyn as Dekaan van Wetenskap by die Universiteit van die Witwatersrand die tuig neergelê. Daarna is hy weer deur die Universiteit van Pretoria aangestel – eers as ’n professor en Hoof van die Departement Chemie en meer onlangs as ’n buitengewone professor en senior navorsingsgenoot in die Sentrum vir die Bevordering van Vakgeleerdheid.
Voor sy aftrede was hy aktief betrokke by navorsing oor chemiese kristallografie en die teorie van molekulêre struktuur, maar dié navorsing het nie die fundamentele antwoord opgelewer waarna hy op soek was nie. Sedert sy aftrede bestee hy wat hy as sy ‘tweede kinderjare’ beskryf aan ’n meer vasberade poging om die aard van ruimte-tyd en materie te verstaan. Hy het ’n punt bereik waar hy besef dat die tradisionele formulering van kwantummeganika die grootste struikelblok is. Sy vordering is in ses monografieë gedokumenteer. Hierdie toekenning word op grond van die mees onlangse monografie aan hom gemaak.
The Chemistry of Matter Waves
Ye ke ya morago gape ye e mpshafaditšwego mo mohlwaeleng wa dipuku le diphatlalatšo tšeo Prof Boeyens a abago lebaka la mokgwa wo moswa wa tlhalošo ye bohlokwa ya khemistri. O fa dithuto ka botlalo tša thuto ya dingwalo ya maleba gomme e utolla gore boramahlale ba bantši ba go tuma ga se ba tsopolwa gabotse ka dipukung tša kgakollo gape ga se ba hlathollwa gabotse ke boramahlale ba bangwe. E ka se be pheteletšo go hlaloša puku ye bjalo ka yeo e ferekanyago.
Ka ga mongwadi
Moprofesa Jan Boeyens o rotše modiro Yunibesithing ya Witwatersrand morago ga go e šomela mengwaga ye 20 bjalo ka moprofesa wa ad hominem wa Khemistri ya Teori le paka ye tee bjalo ka Hlogo ya Saense. O thwetšwegape ke Yunibesithi ya Pretoria bjalo ka moprofesa le Hlogo ya Kgoro ya Khemistri, gomme kgauswinyana mo, o thwetšwe bjalo ka moprofesa wa go ikgetha le mogweramoleloko yo mogolo wa dinyakišišo ka Senthareng ya Thekgo ya Ditšhelete tša Thuto ya Tšweletšopele.
Pele ga go rola modiro ga gagwe o be a kgatha tema ka mafolofolo ka dinyakišišong tša kristalokrafi ya khemikale le teori ya sebopego sa molekhula, tšeo di paletšwego ke go tšweletša karabo ya motheo yeo a bego a e nyaka. Go tloga mola a rolago modiro o feditše seo a se bitšago ‘bongwana bja bobedi’ bja gagwe a dira ka gohlegohle go kwešiša tlhago ya sekgoba-nako le dilo. O fihlile ntlheng yeo a amogelago popo ya tlwaelo ya mekhanikse wa dilwana bjalo ka lepheko le legolo. Kgatelopele ya gagwe e ngwadilwe ka gare ga dimonokrafo tše tshela, tšeo tša kgauswinyana tša tšona di mo thopišitšego sefoka se.
Professor Jan Boeyens | Natural and Applied Sciences | Natuur- en Toegepaste Wetenskappe | Disaense tša Tlhago le Tirišo

Exceptional Academic Achievers
Uitnemende
Akademiese Presteerders
Bašomedi bao ba Atlegilego Kudu: Diakatemiki
This award is made annually to senior academics who have already achieved the status of professor, are regarded highly by their peers and have consistently excelled in the areas of under- and postgraduate teaching and learning, research, community service and administration over a period of time. Any academic who has been awarded an A-rating by the NRF in the year under consideration automatically qualifies as an Exceptional Achiever for as long as he or she remains an A-rated researcher.
Dié toekenning word jaarliks aan senior akademici gemaak wat reeds professorale status verwerf het, besonder hoë statuur onder hulle eweknieë geniet en oor ‘n geruime tydperk volgehoue uitnemende prestasies op die gebied van voor-en nagraadse onderrig en leer, navorsing, gemeenskapsdiens en administrasie behaal het. Enige akademikus wat deur die NNS as ‘n A-gegradeerde navorser geëvalueer is, in die jaar onder oorweging, word outomaties ‘n Uitnemende Presteerder vir so lank as wat hy of sy die status van ‘n A-gegradeerde navorser behou.
Sefoka se se abelwa bafahloši bao ba lego maemong a godimo a seakatemiki ebile ba šetše ba fihleletše maemo a boprofesa gomme ba hlompšha ke ba mephato ya bona gape ba tšwelapele go šoma ka bothakga ka magorong a go ruta le go ithuta go baithuti ba maphoskratšuweiti le go bao e sego maphoskratšuweiti, dinyakišišong, tirelong ya setšhaba le tshepedišong godimo ga nako ya go bonala. Mofahloši o mongwe le o mongwe yo a fihleletšego maemo a NRF a (A) o kgotsofatša dinyakwa tša go tsenela legoro la Moatlegi wa go Tšwelela ka Magetla ka dinako ka moka ge a ntše a le monyakišiši wa maemo a (A).

Professor Wlady, as he is known among his students, has been the incumbent of the Kumba-Exxaro Chair in the Department of Geology since 2009. Prior to his appointment in this position he was professor at Ludwig Maximillian University of Munich, in Germany and an honorary professor at Shandong University of Technology in Tsing Dao, China. He has taught in many countries, including France, India, the USA and Australia, where he won a research scholarship at the University of New South Wales, Sydney in 2013.
Professor Altermann has served on several international science evaluation panels and as treasurer and council member of the Geological Society of Africa. He is the current vice-president of the society, chairs the South African Committee for Stratigraphy (SACS), and is a member of various international editorial boards. He served as an associate editor of the Journal of African Earth Sciences and edited four books and seven special issues of international journals. To date, his publications, of which there are more than 200, have been cited 2 350 times. Professor Altermann teaches in the field of geology and has successfully supervised four PhD, one MSc and 20 honours students since joining UP. Currently he supervises ten MSc and two PhD students at UP and has gathered around him the largest Carbon Storage Working Group in South Africa, which cooperates closely with the South African Centre for Carbon Capture and Storage, the Council for Geoscience, and with international institutions. Students belonging to this working group have received several international stipends and are currently visiting universities and laboratories in Germany and the USA. A cooperation agreement signed with Norway in 2015 will enable students and lecturers to take part in an academic exchange programme.
In 2014 Professor Altermann drafted a new vision for the Department of Geology, which takes into account the changes in the South African mining and energy sectors and aims to develop a new research focus on geological carbon storage and the geology of conventional and unconventional energy resources. Professor Altermann is also interested in and drives research projects on Precambrian geology, biogeology and the evolution of life, and sedimentary ore and coal deposits. In 2014 he received an NRF National Equipment Programme (NEP)/National Nanotechnology Equipment Programme (NNEP) grant, together with Dr Roger Dixon of the Department of Geology and Professor Andrie Garbers-Craig of the Department of Materials Science and Metallurgical Engineering, to establish the first SELFRAG high-voltage-pulse rock-fracturing and mineral-separation laboratory in Africa, and one of only a few such laboratories worldwide. This is the second time that the University acknowledges him as an Exceptional Academic Achiever. Professor Altermann received a B1 rating from the NRF.
Professor Wlady, soos hy onder sy studente bekend staan, beklee sedert 2009 die Kumba-Exxaro-leerstoel in die Departement Geologie. Voor sy aanstelling in hierdie pos was hy ‘n professor aan Ludwig Maximilian-universiteit in München, Duitsland en ‘n ereprofessor aan Shandong-universiteit van Tegnologie in Tsing Dao, China. Hy was al dosent in baie lande, waaronder Frankryk, Indië, die VSA en Australië, waar hy in 2013 ‘n navorsingsbeurs aan die Universiteit van Nieu-Suid-Wallis, Sydney gekry het. Professor Altermann het reeds in verskeie internasionale evaluasiepanele gedien, en was tesourier en raadslid van die Geologiese Vereniging van Afrika. Tans is hy visepresident van die vereniging, voorsitter van die Suid-Afrikaanse Komitee vir Stratigrafie (SAKS) en lid van verskeie internasionale redaksionele rade. Hy was ‘n mederedakteur van die Journal of African Earth Sciences en redakteur van vier boeke en ses spesiale uitgawes van internasionale joernale. Sy publikasies, waarvan daar meer as 200 is, is reeds 2 350 keer aangehaal.
Professor Altermann doseer op die gebied van geologie en was sedert 2009 by UP studieleier van vier suksesvolle Phd-, een MSc- en 20 honneursstudente. Tans is hy studieleier van tien MSc- en twee PhD-studente. Hy het die grootste Koolstofbergingswerkgroep in SuidAfrika byeengebring, wat nou saamwerk met die Suid-Afrikaanse Sentrum vir Koolstofvaslegging en –berging, die Raad vir Geowetenskap en met internasionale instellings. Studente wat aan hierdie werkgroep behoort, het reeds verskeie internasionale studiebeurse ontvang en is tans op besoek aan universiteite en laboratoriums in Duitsland en die VSA. ‘n Samewerkingsooreenkoms wat in 2015 met Noorweë onderteken is, sal dit vir studente en dosente moontlik maak om aan ‘n akademiese uitruilprogram deel te neem.
In 2014 het professor Altermann ‘n nuwe visie vir die Departement Geologie opgestel, wat die veranderinge in die Suid-Afrikaanse mynbou- en energiesektore in ag neem en gemik is op die ontwikkeling van ‘n nuwe navorsingsfokus, te wete geologiese koolstofberging en die geologie van konvensionele en onkonvensionele energiehulpbronne. Professor Altermann stel ook belang in en dryf navorsingsprojekte oor Prekambriese geologie, biogeologie en die evolusie van lewe, en sedimentêre erts- en steenkoolafsettings. In 2014 het hy, tesame met dr Roger Dixon van die Departement Geologie en professor Andrie Garbers-Craig van die Departement Materiaalwetenskap en Metallurgiese Ingenieurswese, ‘n NNS Nasionale Toerustingprogram (NTP) / Nasionale Nanotegnologie-toerustingprogram (NNTP)-toekenning ontvang om die eerste SELFRAG-laboratorium vir hoëspanningpuls-rotskraak- en mineraalskeiding in Afrika – en een van net enkeles ter wêreld – in te rig. Dit is die tweede keer dat die Universiteit hom as ‘n Uitnemende Akademiese Presteerder vereer. Professor Altermann het ‘n B1-gradering van die NNS ontvang.
Profesa Wlady, bjalo ka ge a tsebja ke a baithuti ba gagwe, e bile mohlankedi wa Setulo sa Kumba-Exxaro ka Kgorong ya Geologi go tloga ka 2009. Pele a thwalwa maemong a e be e le profesa Yunibesithing ya Ludwig-Maximillian ka Munich go la Germany gape e le profesa wa tlhompho Yunibesithing ya Theknolotši ya Shandong go la Tsing Dao, China. O rutile dinageng tše ntši, go akaretšwa France, India, USA le Australia, mo a thopilego thekgo ya ditšhelete tša dinyakišišo Yunibesithing ya New South Wales, Sydney ka 2013.
Profesa Altermann o šomile dihlopheng tša tekolo ya disaense tša ditšhabatšhaba gape e bile moswaramatlotlo le leloko la khansele ya ya Lekotla la Geologi la Afrika. Gape ke modulasetulo wa Komiti ya Afrika Borwa ya Stratikrafi. Ka se sebaka ke motlatšamopresidente wa lekgotla wo ebile ke moleloko wa diboto tša borulaganyi tša ditšhabatšhaba tša go fapana. O šomile bjalo ka mothušamorulaganyi wa Journal of African Earth Sciences gomme o rulagantše dipuku tše nne le dikgatišo tša go ikgetha tša dijenale tša ditšhabatšhaba. Ga bjale, dikgatišo tša gagwe, tšeo di lego ka godimo ga 200, di tsopotšwe makga a 2 350. Profesa Altermann o ruta ka lekaleng la geologi ebile o hlahlile baithuti ba bane ba PhD, yo motee wa MSc le ba 20 ba honase ka katlego go tloga ka 2010. Ka se sebaka o hlahla baithuti ba lesome ba MSc le ba babedi ba PhD. O bopile Sehlophatšhomo sa Polokelo ya Khapone ka Afrika Borwa, seo se šomišanago ka tshwanelo e sego fela le Senthara ya Afrika Borwa ya Kgoboketšo le Polokelo ya Khapone le Lekgotla la Geosaense, eupša le diinstitušene tša ditšhabatšhaba. Baithuti ba e lego karolo ya sehlophatšhomo se ba amogetše meputso ye mentši ya ditšhabatšhaba gomme ka se sebaka ba etetše diyunibesithi le dilaporatori go la Germany le USA. Kwano ya tšhomišano ye e saennwego le Norway ka 2015 e tla kgontšha baithuti le bafahloši go tšea karolo ka gare ga lenaneoneeletšano la thuto.
Ka 2014 Profesa Altermann o ngwaletše Kgoro ya Geologi pono ye mpsha, yeo e tlogo akaretša diphetogo ka makaleng a enetši le meepo ka Afrika Borwa gape maikemišetšo a yona ke go tšweletša nepišo ye mpsha ya dinyakišišo ka ga polokelo ya khapone ya geologi le geologi ya methopo ya tlwaelo le ye e sego ya tlwaelo ya enetši . Profesa Altermann gape o na le kgahlego ebile o etapele diprotšeke tša dinyakišišo ka ga geologi ya pele ga lebaka la Cambria, payogeologi le phetogo ya bophelo, le borale bja sedimentari le disedimentari tša malahla. Ka 2014 o amogetše thušo ya tšhelete ya NRF ya Lenaneo la Setšhaba la Didirišwa (NEP)/Lenaneo la Bosetšhaba la Didirišwa tša Nanotheknolotši (NNEP), yena le Ngaka Roger Dixon wa Kgoro ya Geologi le Profesa Andrie GarbersCraig wa Kgoro ya Saense ya Dimateriale le Boentšenere bja Metaletšikhale, go hloma laporatori ya go pšatla maswika ya lebelo la bolothetše ya godimo le kgaoganyo ya diminerale ya SELFRAG ka Afrika, e bile e le ye nngwe ya tše mmalwa fela lefaseng ka bophara. Le ke lekga la bobedi leo Yunibesithi e mo lebogago bjalo ka Mokgoni wa Thuto wa go Ikgetha. Profesa Altermann o abetšwe maemo a B1 go tšwa go NRF.
Professor Wlady Altermann

Professor Focke is a professor in the Department of Chemical Engineering and Director of the Institute of Applied Materials. He teaches Materials Science and Engineering, and Phase Equilibrium Thermodynamics at undergraduate level, as well as Polymer Processing and Polymer Additive Technology at postgraduate level. His research focuses on chemical product design, with the emphasis on carbon materials, polymer additive technology, pyrotechnics and prophylactic malaria control. Various thermal analysis techniques are employed to characterise and control oxidative processes in pyrotechnics, biodiesel and materials such as polymers and graphite.
Professor Focke has received considerable funding support for his research aimed at finding safer ways to control malaria vector mosquitoes. Sasol, for example, funded the development of a long-life polypropylene mosquito net. One of his research aims is to prolong the activity of insecticides approved by the World Health Organisation (WHO) as replacements for the controversial DDT currently used for indoor residual spraying (IRS). Research in this regard and the development of an insecticidal paint for IRS were supported by the Bill and Melinda Gates Foundation. Professor Focke’s research group also received a Mozambique-South Africa research grant that enabled them to explore the use of local clays as controlled release devices for IRS insecticides. Current efforts are focused on the use of natural products and durable wall linings. Professor Focke is a registered professional engineer and a member of the American Chemical Society, the Polymer Processing Society, the International Pyrotechnics Society and the South African Institute of Chemical Engineers. The Institute of Applied Materials is an interdisciplinary materials research group that has been housing the SARChI Chair in Carbon Technology and Materials since 2006. Professor Focke actively collaborates with Professor Brian Rand, a world leader in the field of carbon materials research. He also collaborates with the Leibniz Institute of Polymer Research in Dresden and the University of Halle-Wittenberg, (both in Germany), on polymers, and with the Eduardo Mondlane University in Maputo, Mozambique on clays.
He is an editorial board member of the Journal of Vinyl and Additive Technology, the International Journal of Adhesion & Adhesives and International Polymer Processing. Professor Focke has published more than 120 papers in international peer-reviewed journals. His current Scopus h-index is 15 and his publications listed in Scopus have been cited 1 619 times. Google Scholar indicates a total of 1 846 citations with an h-index of 17 and an i10-index of 34.
Professor Focke is ʼn professor in die Departement Chemiese Ingenieurswese en Direkteur van die Instituut vir Toegepaste Materiale. Hy doseer Materiaalkunde en Materiaalingenieurswese asook Fase-ewewig-termodinamika op voorgraadse vlak en Polimeerprosessering en Polimeerbymiddeltegnologie op nagraadse vlak. Sy navorsing is toegespits op chemiese produkontwerp met die klem op koolstofmateriale, polimeerbymiddels, pirotegnieke en profilaktiese malariabeheer. Verskeie termiese karakteriseringstegnieke word gebruik om oksidasieprosesse in pirotegnieke, biodiesel en materiale soos polimere en grafiet te karakteriseer en te beheer.
Professor Focke het heelwat befondsing ontvang vir sy navorsing oor veiliger metodes vir die beheer van malariavektormuskiete. So het Sasol byvoorbeeld die ontwikkeling van ’n duursame polipropileenmuskietnet ondersteun. ’n Belangrike navorsingsoogmerk is om die aktiewe leeftyd van insekdoders wat deur die Wêreld¬gesondheids¬organisasie (WGO) goedgekeur is, te verbeter om hulle geskik te maak as alternatiewe vir die kontroversiële DDT wat tans vir interne residuele sproei (IRS) gebruik word. Die Bill en Melinda Gates-stigting het navorsing befonds vir die ontwikkeling van ’n insekdodende verf vir IRS. Professor Focke se navorsingsgroep het gesamentlike befondsing van Mosambiek en Suid-Afrika ontvang om ondersoek in te stel na die gebruik van plaaslike kleisoorte as ’n middel vir die beheerde vrystelling van IRS-insekdoders. Huidige pogings fokus op die gebruik van natuurlike produkte en duursame insekdodende muurbedekkings. Professor Focke is ’n geregistreerde professionele ingenieur en lid van die American Chemical Society, die Polymer Processing Society, die International Pyrotechnics Society en die Suid-Afrikaanse Instituut van Chemiese Ingenieurs. Die Instituut vir Toegepaste Materiale is ’n interdissiplinêre materiaalnavorsingsgroep wat ook sedert 2006 die SARChI-leerstoel in Koolstoftegnologie en -materiale huisves. Professor Focke werk aktief saam met professor Brian Rand, ’n wêreldleier op die gebied van koolstof¬materiaal¬navorsing. Hy werk ook saam met die Leibniz-instituut vir Polimeernavorsing in Dresden en die Universiteit van Halle-Wittenberg (beide in Duitsland) op die gebied van polimere, en met die Eduardo Mondlane-universiteit in Maputo, Mosambiek, op kleisoorte.
Hy is redaksielid van die Journal of Vinyl and Additive Technology, die International Journal of Adhesion & Adhesives en International Polymer Processing. Professor Focke het reeds meer as 120 referate in internasionale portuurbeoordeelde vaktydskrifte gepubliseer. Sy huidige Scopus h-indeks is 15 en sy publikasies wat in Scopus gelys word, is reeds 1 619 keer aangehaal. Google Scholar toon 1 846 aanhalings met ʼn h-indeks van 17 en ’n i10-indeks van 34.
Profesa Focke ke profesa ka Kgorong ya Boentšenere bja Dikhemikhale le Molaodimogolo wa Institute ya Dimateriale tša Tirišo. O ruta Disaense tša Dimateriale le Boentšenere, gammogo le Dithemotaenamiki tša Ekhwilibriamo mo legatong la baithutelatikrii, Tshepetšo ya Pholima le Theknolotši ya Senoki sa Pholima mo legatong la dialogadigolwane. Dinyakišišo tša gagwe di nepiša moakanyetšo wa setšweletšwa sa khemikhale, go gatelelwa dimateriale tša khapone, theknolotši ya senoki sa pholima, diphaerothekniki le taolo ya malaria wa profalekthiki. Dithekniki tše di fapanego tša tshekatsheko ya themale di a dirišwa go farologantšha le go laola ditshepedišo tša oksitetifi ka diphaerothekniki, payotisele le dimateriale tša go swana le pholima le krafaete.
Profesa Focke o amogetše thekgo ya ditšhelete ya dinyakišišo tša gagwe ka maikemišetšo a go thekga mekgwa yeo e bolokegilego ya go laola menang yeo e hlolago malaria. Sasol, mohlala, e thekgile tšweletšopele ya lelokwa la bophelo bjo botelele bja pholipropalini. Ye nngwe ya nyakišišo ya gagwe maikemišetšo a yona ke go ditela mešongwana ya moupakhukhu woo o dumeletšwego ke Mokgatlo wa Maphelo wa Lefase bjalo ka dipeobakeng tša ngangišano ya DDT yeo gabjale e šomišwago ka dintlong go fothela nako ye telele. Nyakišišo ka tsela ye le tšweletšopele ya pente ya moupakhukhu wa go fothela ka dintlong nako ye telele e thekgilwe ke Motheo wa Bill le Melinda Gates Sehlopha sa dinyakišišo sa Profesa Focke se hweditše gape thekgo ya ditšhelete ya Mozambique-Afrika Borwa yeo e ba kgontšhitšego go utolla tšhomišo ya matsopa a mo gae bjalo ka sedirišwa seo se lokolotšwego sa go laolwa sa moupakhukhu wa go fothela ka dintlong nako ye telele. Maitapišo a bjale a nepiša mo tšhomišong ya ditšweletšwa tša tlhago le difuru tše bothata tša mabotong. Profesa Focke ke moentšenere wa profešene yoo a ngwadišitšwego le leloko la Mokgatlo wa Dikhemikhale wa Amerika, Mokgatlo wa Tshepetšo ya Pholima, Mokgatlo wa Ditšhabatšhaba wa Phaerothekniki le Institute ya Afrika Borwa ya Boentšenere bja Dikhemikhale. Institute ya Dimateriale tša Tirišo ke sehlopha sa dinyakišišo sa dimateriale tša dithuto tša go tsenelana seo se bego se swara Setulo sa SARCHi sa Theknolotši ya Khapone le Dimateriale go tloga ka 2006. Profesa Brian Rand, moetapele wa lefase mo lefapheng la dinyakišišo tša dimateriale tša khapone, ke moswari wa motšwaoswere wa Setulo se. Profesa Focke o swaragane le mešongwana ya tirišano ya nyakišišo ya tiro yeo e amanago le dimateriale tša khapone mmogo le Profesa Rand. O dirišana gape le Institute ya Leibniz ya Dinyakišišo tša Pholima kua Dresden le Yunibesithi ya Halle-Wittenberg, ka moka di Germany, ka dipholima, le Yunibesithi ya Eduardo Mondlane kua Maputo, Mozambique ka matsopa.
Ke leloko la lekgotla la barulaganyi la Journal of Vinyl and Additive Technology, International Journal of Adhesion & Adhesives and International Polymer Processing. Profesa Focke o phatlaladitše dipampiri tša go feta 115 mo ditšenaleng tšeo di lekotšwego ke badirišane tša ditšhabatšhaba. Tšhupane ya gagwe ya Scopus ya bjale ke 13 gomme diphatlalatšo tša gagwe tšeo di lego lenaneong la Scopus di tsopotšwe makga a 1 485. Baithuti ba Google ba laetša palomoka ya ditsopolwa tše 1 600 le Tšhupane ya 15 le Tšhupane ya i10 ya 34.
Professor Walter Focke

Professor Hassan has been the Director of the Centre for Environmental Economics and Policy in Africa (CEEPA) in the Faculty of Natural and Agricultural Sciences since 1997. He was awarded an MSc and a PhD degree by Iowa State University (USA). Prior to his appointment in his current post he was a programme director at the CSIR (1995−1997), a regional economist at the International Maize and Wheat Improvement Center (commonly referred to by its Spanish acronym, CIMMYT, 1992−1995) and a Postdoctoral Rockefeller Fellow (1990−1992). Before 1990, he was attached to the universities of Khartoum and Juba.
Professor Hassan is a Senior Fellow of the University of Bonn Centre for Development Research (ZEF, 2012−2016) and has served as a member of many national and international advisory boards and committees, including the Science Advisory Council (SAC) of the Stockholm Environment Institute (2014); the Board of the International Society for Ecological Economics; the Consortium of International Agricultural Research Centers (CGIAR) Science Council – Independent Science and Partnership Council (ISPC); the CGIAR Climate Change Challenge Program (CCCP); the Academic Advisory Panel for The World Development Report on Climate Change; the Stockholm Resilience Centre Board; the Global Environment Facility (GEF) Science and Technical Advisory Panel-STAP IV; the Science Panel of the Millennium ecosystem assessment; and the Human Sciences Research Council (HSRC) of South Africa. He is a member of the Academy of Sciences of South Africa (since 2005), an Elected Fellow of the Academy of Sciences for the Developing World-TWAS, and a Senior Fellow of the Africa Association of Agricultural Economists (AAAE).
He serves on the editorial boards of many international journals and was the founding chief editor of the African Journal of Agricultural and Resource Economics (2006–2010). Professor Hassan is the author of more than 160 refereed publications, including 12 books. He was awarded the University of Pretoria Chancellor’s Medal (Research) in 2011. This is the fourth time he is recognised as an Exceptional Academic Achiever by the University of Pretoria.
Professor Hassan is sedert 1997 die Direkteur van die Sentrum vir Omgewingsekonomie en -beleid in Afrika (CEEPA) in die Fakulteit Natuur- en Landbouwetenskappe. Hy het ‘n MSc- en ‘n PhD-graad van die Iowa-staatsuniversiteit (VSA) ontvang. Voor sy aanstelling in sy huidige pos was hy ‘n programdirekteur by die WNNR (1995−1997), ‘n streekekonoom by die Internasionale Mielie- en Koringverbeteringsentrum (algemeen bekend onder sy Spaanse akroniem, CIMMYT, 1992−1995) en ‘n nadoktorale Rockefeller-genoot (1990−1992). Voor 1990 was hy aan die universiteite van Kartoem en Juba verbonde.
Professor Hassan is ‘n Senior Genoot van die Universiteit van Bonn se Sentrum vir Ontwikkelingsnavorsing (ZEF, 2012−2016) en het al op talle nasionale en internasionale adviesrade en komitees gedien, insluitende die Wetenskapadviesraad van die Stockholmomgewingsinstituut (2014); die Raad van die Internasionale Vereniging vir Ekologiese Ekonomie; die Konsortium van Internasionale Landbounavorsingsentrums (CGIAR) se Wetenskapraad – Onafhanklike Wetenskap- en Vennootskapsraad (ISPC); die CGIAR Klimaatveranderingprobleemprogram (CCCP); die Akademiese Adviespaneel vir The World Development Report on Climate Change; die Stockholm Veerkragsentrumraad; die Global Environmental Facility (GEF) se Wetenskap- en Tegniese Adviespaneel-STAP IV; die Wetenskappaneel van die Millennium ecosystem assessment, en die Raad vir Geesteswetenskaplike Navorsing (RGN) van Suid-Afrika. Hy is lid van die Suid-Afrikaanse Akademie van Wetenskappe (sedert 2005), ‘n Gekose Genoot van die Akademie van Wetenskappe vir die Ontwikkelende Wêreld-TWAS, en ‘n Senior Genoot van die Afrikagenootskap van Landbou-ekonome (AAAE).
Hy dien in die redaksionele rade van baie internasionale joernale en was die stigtershoofredakteur van die African Journal of Agricultural and Resource Economics (2006–2010). Professor Hassan is die skrywer van meer as 160 beoordeelde publikasies, wat 12 boeke insluit. Hy het in 2011 die Universiteit van Pretoria se Kanseliersmedalje (Navorsing) ontvang. Dit is die vierde keer dat hy deur die Universiteit van Pretoria as ‘n Uitsonderlike Akademiese Presteerder erken word.
Profesa Hassan e bile Molaodimogolo wa Senthara ya Diekonomi tša Tikologo le Dipholisi mo Afrika ka Lefapheng la Disaense tša Tlhago le Temo go tloga ka 1997. O amogeditšwe ditikrii tša MSc le PhD ke Yunibesithi ya Mmušo ya Iowa (USA). Pele ga go thwalwa ga gagwe mo mošomong wa bjalo e be e le moaladimogolo wa mananeo CSIR (1995-1997), raekonomi wa selete mo Senthareng ya Ditšhabatšhaba ya Kaonafatšo ya Korong le Mafela (yeo e tsebegago ka khutsofatšo ya yona ya Spanish, CIMMYT, 1992−1995), le Modirišane wa Rockefeller wa ka Morago ga Bongaka (1990 – 1992). Pele ga 1990 o be a šomela diyunibesithi tša Khartoum le Juba.
Profesa Hassan ke Modirišanemogolo wa Senthara ya Tšweletšopele ya Dinyakišišo ya Yunibesithi ya Bonn (ZEF, 2012−2016) gomme e bile leloko la makgotla a dikeletšo le dikomiti tše dintši tša gae le tša ditšhabatšhaba, go akaretša le Khansele ya Dikeletšo tša Saense ya Institute ya Tikologo ya Stockholm (2014); Boto ya Mokgatlo wa Ditšhabatšhaba wa Diekonomi tša Ekholotši; Khonsotiamo ya Dinyakišišo tša Disenthara tša Temo tša Ditšhabatšhaba tša Khansele ya Disaense – Disaense tšeo di Ikemetšego le Dikhansele tša Tirišano; Lenaneo la Tlhotlo ya Phetogo ya Klaemete la Khonsotiamo ya Dinyakišišo tša Disenthara tša Temo tša Ditšhabatšhaba; Panele ya Dikeletšo tša Thuto ya The World Development Report on Climate Change; Boto ya Senthara ya Maatla ya Stockholm; Panele ya Dikeletšo ya Disaense le Dithekniki ya bo IV ya Dinolofatši tša Tikologo tša Lefase; Panele ya Disaense tša Millennium Ecosystem Assessment; le Khansele ya Disaense tša Dinyakišišo tša Setho ya Afrika Borwa. Ke leloko la Akademi ya Disaense ya Afrika Borwa (go tloga ka 2005), Modiršane yo a Kgethilwego wa Akademi ya Disaense ya Lefase le le sa Golago-TWAS, le Modirišanemogolo wa Mokgatlo wa Afrika Diekonomi tša Temo.
O thuša mo dibotong tša barulaganyi tša ditšenale tša ditšhabatšhaba tše dintši gomme e be e le mothei morulaganyimogolo wa African Journal of Agricultural and Resource Economics (2006–2010). Professor Hassan ke mongwadi wa dikgatišo tše di lekotšwego tša go feta 160, go akaretšwa dipuku tše 12. O abetšwe Metale wa Mokhanseliri wa Yunibesithi ya Pretoria ka 2011. Le ke lekga la bone a lemogwa bjalo ka Mokgoni wa Thuto wa go Ikgetha ke Yunibesithi ya Pretoria.
Professor Rashid Hassan

Professor Meyer works in the Department of Plant Science (of which he was head from 2001 until 2013) in the Faculty of Natural and Agricultural Sciences. His research focuses on phytochemistry in general, and more specifically on the metabolomics of the secondary compounds of medicinal plants, which plants produce to defend themselves against pathogens and herbivores. His research team isolated many novel secondary compounds that showed in vitro activity against tuberculosis, erectile dysfunction, malaria, HIV, herpes viruses and other pathogens. Four patents have resulted from this work and more than 100 papers were published in ISI journals. Professor Meyer also did research at the University of Durham, England and Ludwig Maximilian University of Munich, Germany during sabbaticals lasting approximately three years.
Professor Meyer plays an active role in the professional societies in his field of research. He is a past president of the South African Association of Botanists and is now a council member of the association. The main achievement during his term as president was the internationalisation the association’s journal, South African Journal of Botany, by negotiating a publishing contract with Elsevier. Since then, the impact factor of the journal has more than quadrupled. He is on the editorial board of three ISI journals and referees approximately 30 papers per year for these and other international journals. He recently received the South African Association of Botanists’ silver medal for his research achievements and his contribution to plant sciences in general. The Thomson Reuters Essential Science Indicators (ESI) currently rank Professor Meyer in the top 1% of scientists in the field of pharmacology and toxicology. He has 17,5 citations per paper in this field and 11,9 citations per paper in other fields.
Professor Meyer werk in die Departement Plantkunde (waarvan hy van 2001 tot 2013 die hoof was) in die Fakulteit Natuur- en Landbouwetenskappe. Sy navorsing fokus op fitochemie in die algemeen en meer spesifiek op die metabolomika van die sekondêre verbindings van medisinale plante, dit wil sê die verbindings wat plante vervaardig om hulself teen patogene en herbivore te beskerm. Sy navorsingspan het talle nuwe sekondêre verbindings geïsoleer wat in vitro-aktiwiteit teen tuberkulose, erektiele disfunksie, malaria, MIV, herpes-virusse en ander patogene getoon het. Sy werk het tot vier patente gelei, en meer as 100 artikels is in ISI-joernale gepubliseer. Tydens sabbatsverlof van nagenoeg drie jaar het professor Meyer navorsing aan die Universiteit van Durham in Engeland en Ludwig Maximilian-universiteit in München, Duitsland gedoen.
Professor Meyer speel ‘n aktiewe rol in die professionele liggame op sy navorsingsgebied. Hy is ‘n gewese president van die SuidAfrikaanse Genootskap van Plantkundiges en is nou ‘n raadslid van die vereniging. Die grootste prestasie gedurende sy termyn as president was die internasionalisering van die vereniging se joernaal, South African Journal of Botany, deur die bedinging van ʼn publikasiekontrak met Elsevier. Sedertdien het die impak van die joernaal meer as vervierdubbel. Hy dien in die redaksie van drie ISI-joernale en beoordeel ongeveer 30 artikels per jaar vir hierdie en ander internasionale joernale. Hy het onlangs die Suid-Afrikaanse Genootskap van Plantkundiges se silwermedalje ontvang vir sy navorsingsprestasies en sy bydrae tot plantwetenskappe oor die algemeen. Die Thomson Reuters Essential Science Indicators (ESI) plaas professor Meyer tans in die top 1% wetenskaplikes op die gebied van farmakologie en toksikologie. Hy het 17,5 sitasies per artikel op hierdie gebied en 11,9 sitasies per artikel op ander gebiede.
Profesa Meyer o šoma ka Kgorong ya Saense ya Dimela ka Lefapheng la Disaense tša Tlhago le Temo, yeo e bego e le hlogo ya yona go tloga ka 2001 go fihla ka 2013. Nyakišišo ya gagwe e nepiša go faethokhemistri ka kakaretšo, mme gagolo go dimetapolomiki tša ditlhakantšhetšo tša sekontari tša dimela tša go alafa, yeo dimela di e tšweletšago go itšhireletša kgahlanong le dipatotšene le diphoofolo tša go phela ka go ja dimela. Sehlopha sa gagwe sa dinyakišišo se utullotše ditlhakantšhetšo tše mpsha tše ntši go tšwa dimeleng ka mošongwana wa in vitro kgahlanong le bolwetši bja mafahla, go se tsogelwe ga setho sa bonna, malaria, HIV, baerase ya mohlohlono le dipatotšene tše dingwe. Dipheitente tše nne di tšweleditšwe ke mošomo wo le dipampiri tša go feta tše 100 di phatlaladitšwe ka gare ga dijenale tša ISI. Gape Profesa Meyer o dirile dinyakišišoYunibesithing ya Durham, England le Yunibesithing ya Ludwig Maximilian ya Munich, Germany nakong ya maikhutšo a dinyakišišo tša gagwe tše a di tšerego mengwaga ya go balelwa go ye meraro.
Profesa Meyer o raloka karolo ye bohlokwa ka makgotleng a seprofešenale ka lekaleng la gagwe la dinyakišišo. Ke presidente ya maloba ya Mokgatlo wa Afrika Borwa wa Boradimela gomme ga bjale ke leloko la khansele la mokgatlo. Phihlelelo ye kgolo nakong ya lebaka la gagwe bjalo ka presidente e bile go bea jenale, South African Journal of Botany, ya mokgatlo maemong a ditšhabatšhaba ka go boledišana le Elsevier ka tumelelano ya kgatišo. Go tloga moo, lebaka la khuetšo ya jenale le menagane go feta gane. O mo botong ya borulaganyi ya dijenale tše tharo tša ISI ebile ke molekodi wa dipampiri tša go balelwa go tše 30 ka ngwaga wa dijenale tše le wa tše dingwe tša ditšhabatšhaba. Kgauswinyane o amogetše metale wa silibere wa Mokgatlo wa Afrika Borwa wa Boradimela wa diphihlelelo tša gagwe tša dinyakišišo le seabe sa gagwe go disaense tša dimela ka kakaretšo. Ditšhupo tša Saense tše Bohlokwa tša Thomson Reuters ka se sebaka di bea Profesa Meyer ka gare ga 1% ya godimo ya borasaese ba famakholotši le thoksikholotši. O na le ditsopolwa tše 17,5 go pampiri ye nngwe le ye nngwe ka lekaleng le le ditsopolwa tše 11,9 go pampiri ye nngwe le ye nngwe ka makaleng a mangwe.
Professor Marion Meyer

Professor Pepper is a professor in the Department of Immunology and the Director of the Institute for Cellular and Molecular Medicine, Faculty of Health Sciences. He is also an associate professor in the Department of Genetic Medicine and Development in the Faculty of Medicine at the University of Geneva, Switzerland. He completed his MBChB degree in the Faculty of Medicine at the University of Cape Town in 1982. In 1986 he moved to Geneva, where he was awarded a PhD in 1990 and an MD in 1992. In 1997 he obtained his Habilitation and the title Privat Docent was conferred on him. He returned to South Africa in July 2004. Professor Pepper has worked extensively in the field of clinically oriented (translational) molecular cell biology and, while in Geneva, made seminal contributions to understanding the mechanisms of angiogenesis and lymphangiogenesis. Since his return to South Africa, he has refocused his interests to the fields of stem cells and the human genome.
With regard to stem cell research, Professor Pepper’s group works on both adult and pluripotent stem cells. In the case of the former, the group has been guided by South Africa’s high burden of disease, in particular HIV (a communicable disease) and obesity (a noncommunicable disease). With regard to HIV, the group – in collaboration with colleagues in Geneva and Zurich – is developing a gene therapy aimed at rendering the immune system resistant to HIV. In their research on obesity, the group is studying the genetics of obesity and has also developed a model of adipogenesis that lends itself to high throughput screening for novel inhibitors. Professor Pepper is co-responsible for the Southern African Human Genome Programme, which was launched in January 2011. He has been coordinating the revision of chapter 8 of the National Health Act 61 of 2003 and its regulations since mid-2009. He developed a five-day continuing education course in bio-entrepreneurship, which was subsequently presented in four provinces in South Africa and is now in its seventh year. Until recently he was a member of the National Advisory Committee on Innovation (project leader: Bio-economy Policies and Strategies), which advises the Minister of Science and Technology, and was chairperson of the National Biotech Advisory Committee.
Professor Pepper has won several local and international awards for his research and has received prestigious funding awards, including the South African Medical Research Council’s (SAMRC) University Flagship award, an SAMRC Extramural Unit (for both stem cell research and therapy), and two back-to-back NRF equipment grants for a sterile cell sorter and a single-cell genomics/ transcriptomics platform.
Professor Pepper is ‘n professor in die Departement Immunologie en die Direkteur van die Instituut vir Sellulêre en Molekulêre Geneeskunde in die Fakulteit Gesondheidswetenskappe. Hy is ook ‘n medeprofessor in die Departement Genetiese Geneeskunde en Ontwikkeling in die Fakulteit Geneeskunde aan die Universiteit van Genève, Switserland. In 1982 het hy die graad MBChB in die Fakulteit Geneeskunde aan die Universiteit van Kaapstad behaal. In 1986 het hy na Genève verskuif, waar hy in 1990 ‘n PhD en in 1992 ‘n MD behaal het. In 1997 het hy sy Habilitation verwerf en is die titel Privat Docent aan hom toegeken. Hy het in Julie 2004 na SuidAfrika teruggekeer.
Professor Pepper het uitgebreide navorsing in kliniesgerigte (verplasings-) molekulêre selbiologie gedoen, en in Genève het hy belangrike bydraes gelewer om die meganismes van angiogenese en limfanfiogenese te verstaan. Sedert sy terugkeer na Suid-Afrika fokus hy weer op navorsing oor stamselle en die mensgenoom. Wat stamselnavorsing betref, werk professor Pepper se groep aan sowel volwasse as pluripotente stamselle. In die geval van eersgenoemde word die groep gelei deur Suid-Afrika se swaar siektelas, in die besonder MIV (‘n oordraagbare siekte) en vetsug (‘n nie-oordraagbare siekte). Met betrekking tot MIV ontwikkel die groep – in samewerking met kollegas in Genève en Zürich – ‘n geenterapie wat daarop gemik is om die immuunstelsel weerstandbiedend teen MIV te maak. In hulle navorsing oor vetsug bestudeer die groep die genetika van vetsug en het hulle ook ‘n model van adipogenese ontwikkel wat hom leen tot hoëdeursetsifting vir nuwe inhibeerders. Professor Pepper is medeverantwoordelik vir die SuiderAfrikaanse Mensgenoomprogram, wat in Januarie 2011 van stapel gestuur is. Sedert die middel van 2009 koördineer hy die hersiening van hoofstuk 8 van die Nasionale Gesondheidswet 61 van 2003, en die regulasies wat daarkragtens uitgevaardig is. Hy het ‘n voortgesette opvoedingskursus van vyf dae in bio-entrepreneurskap ontwikkel. Die kursus, wat nou in sy sesde jaar is, is reeds in vier provinsies van Suid-Afrika. Hy was tot onlangs lid van die Nasionale Advieskomitee oor Innovasie (projekleier: Bio-ekonomiese Beleide en Strategieë), wat die Minister van Wetenskap en Tegnologie adviseer, en voorsitter van die Nasionale Biotegniese Advieskomitee.
Professor Pepper het al verskeie plaaslike en internasionale toekennings vir sy navorsing ontvang en ook gesogte befondsingstoekennings ontvang, insluitende die Suid-Afrikaanse Mediese Navorsingsraad (SAMNR) se Universiteitsvlagskiptoekenning, ‘n Buitemuurse Eenheid (vir sowel stamselnavorsing as terapie), en twee opeenvolgende NNS-toerustingtoekennings vir ‘n steriele selsorteerder en ‘n enkelsel-genomika/transkriptomika-platform.
Profesa Pepper ke profesa ka Kgorong ya Iminolotši ka Lefapheng la Disaense tša Maphelo le Molaodimogolo wa Institute ya Kalafo ya Selula le Molekhula, yeo e theilwego ka motheo wa morero wa dinyakišišo wa leina la go swana la Lefapha la Disaense tša Maphelo. Ke mothuša profesa ka Kgorong ya Kalafo ya Leabela le Tšweletšopele ka Lefapheng la Kalafo Yunibesithing ya Geneva, Switzerland. O phethile tikrii ya gagwe ya MBChB ka Lefapheng la Kalafo la Yunibesithi ya Cape Town ka 1982. Ka 1986 a ya Geneva, moo a abetšwego PhD ka 1990 le MD ka 1992. Ka 1997 o hweditše Dithuto tša Godimo go fihla Magomong gomme a fiwa thaetlele ya Moithaopi wa Praebete. O boile Afrika Borwa ka Mosegamanye 2004.
Profesa Pepper o šomile kudu ka lefapheng leo le nepišago kalafo (nyakišišo ya dikarolo tše pedi) ya payolotši ya disele tša molekhula gomme, ge a le Geneva, o kgathile tema ye bohlokwa go kwešiša mekgwa ya antšiotšenesisi le limphankiotšenesisi. Go tloga mola a boang Afrika Borwa, o fetošeditše nepišo ya kgahlego ya gagwe lefapheng la disele tša dikutu le ditšenome tša batho. Malebana le dinyakišišo tša disele tša dikutu, sehlopha sa Profesa Pepper se šoma ka disele tša dikutu tša kgale le tša bothata tše dintši. Go ya pele, sehlopha se hlahlwa ka malwetši a go hlobaetša a godimo a Afrika Borwa, kudu HIV (bolwetši bjo bo fetelago) le mmele wo montši (bolwetši bja go se fetele). Malebana le HIV, sehlopha- ka tirišano le badirišane ba Geneva le Zurich – se tšweletša terapi ya leabela yeo maikemišetšo a yona e lego go emela mokgwa wa go gana kotsi ya HIV. Mo dinyakišišong tša bona tša mmele wo montši, sehlopha se ithuta ka maabela a mmele wo montši gomme se tšweleditše adipotšenesise yeo e bontšhago bontši bja godimo bja dithibedi tša go se tlwaelege.
Profesa Pepper o na le maikarabelommogo go Lenaneo la Maabela la Batho mo Borwa bja Afrika, leo le thakgotšwego ka Pherekgong 2011. O be a beakanya tshekamollo ya kgaolo ya 8 ya Molao wa Maphelo a Setšhaba wa 61 wa 2003 le melawana ya wona go tloga gare ga 2009. O tšweleditše thutwana ya thuto ya matšatši a mahlano a go latelana ka bophelo bja botsebakgwebo, yeo e abilwego diprofenseng tše nne mo Afrika Borwa gomme ga bjale e mo ngwageng wa botshela. Go fihla ga bjale e be e le leloko la Komiti ya Dikeletšo ya Setšhaba ka ga Kaonafatšo (moetapele wa protšeke: Dipholisi le Mekgwa ya Payoekonomi), yeo e eletšago Tona ya Saense le Theknolotši, le modulasetulo wa Komiti ya Dikeletšo ya Payotheknolotši ya Setšhaba.
Profesa Pepper o thopile difoka tše mmalwa tša gae le tša ditšhabatšhaba tša dinyakišišo tša gagwe gomme o amogetše difoka tša bokgoni tša thekgo ya ditšhelete, go akaretša le sefoka sa Ketapele sa Yunibesithi sa Khansele ya Dinyakišišo tša Kalafo ya Afrika Borwa, Lekala la Tlaleletšo (la dinyakišišo tša disele tša dikutu le terapi), le thekgo ya ditšhelele tša didirišwa tša dithuto tša go se emiše tša sehlopha sa disele tša go hlweka le sefala sa ditšenomiki tša sele ye tee/ditranskriptonomiki.
Professor Michael Pepper

Professor Scholtz, a professor of Entomology in the Department of Zoology and Entomology, has been a recipient of the Outstanding Achiever’s award since its inception at UP. He was also awarded the Chancellor’s award for research twice, and the NRF President’s award for internationally recognised research.
Professor Scholtz’s main research interest is the evolutionary biology and conservation of dung beetles and their relatives. This research is supported by a group of about ten postgraduate students and field and laboratory staff who comprise the Scarab Research Group (SRG). Some of their current projects include the use of dung beetles as indicators of pasture conditions on farms in the Northern Cape and, closer to home, the effect of dung beetles on soil improvement in the rehabilitation of mine dumps in Mpumalanga.
The SRG maintains strong links with international collaborators and their students. Recently three Welsh students spent three months on Matroosberg, the highest peak in the Western Cape, studying the ecology of a unique and endangered stag beetle, members of the only insect group in Africa listed by the Convention on the Trade in Endangered Species (CITES). The species is threatened by, inter alia, the erection of various towers, such as cell phone towers, in its habitat.
Professor Scholtz, ‘n professor in Entomologie in die Departement Dierkunde en Entomologie, is ‘n ontvanger van die Uitstaande Presteerder-toekenning sedert dit aan UP ingestel is. Hy het ook twee keer die Kanselierstoekenning vir navorsing ontvang, en die NNS se Presidentstoekenning vir internasionaal erkende navorsing.
Professor Scholtz se vernaamste navorsingsbelangstelling is die evolusionêre biologie en bewaring van miskruiers en verwante spesies. Hierdie navorsing word gesteun deur ‘n groep van ongeveer tien nagraadse studente en veld- en laboratoriumpersoneel wat die Miskruiernavorsing Groep (MNG) vorm. Hulle huidige navorsingsprojekte sluit in die gebruik van miskruiers as aanwysers van weidingstoestande op plase in die Noord-Kaap en, nader tuis, die uitwerking van miskruiers op grondverbetering in die rehabilitasie van mynhope in Mpumalanga.
Die MNG handhaaf sterk bande met internasionale medewerkers en hulle studente. Drie Walliese studente het onlangs drie maande op Matroosberg, die hoogste piek in die Wes-Kaap, deurgebring, waar hulle die ekologie van ‘n unieke en bedreigde grootkaakkewer bestudeer het. Die kewers is lid van die enigste insekgroep in Afrika wat deur die Konvensie oor die Handel in Bedreigde Spesies (CITES) gelys word. Die spesie word deur onder meer die oprigting van verskeie torings, soos selfoontorings, in sy habitat bedreig.
Profesa Scholtz, profesa wa Entomolotši ka Kgorong ya Thutadiphedi le Entomolotši, e bile moamogedi wa sefoka sa Mokgoni wa go Ikgetha gantši mo UP. Gape o abetšwe Sefoka sa Mokhanseliri sa dinyakišišo gabedi, le Sefoka sa Presidente sa NRF sa dinyakišišo tše di amogelwago maemong a ditšhabatšhaba.
Kgahlego ye kgolo ya dinyakišišo ya Profesa Scholtz ke payolotši ya phetogo le pabalelo ya boloko bja dikhunkhwane le meloko ya tšona. Nyakišišo ye e thekgwa ke sehlopha sa baithuti ba dialogadigolwane le bašomi ba lekala le laporatori bao ba bopago Sehlopha sa Nyakišišo sa Skarabo ( SRG). Tše dingwe tša diprotšeke tša bona tša bjale di akaretša tšhomišo ya maloko a dikhunkhwane bjalo ka ditšhupo tša maemo a phulo dipolaseng go la Kapa Leboa gomme, kgauswi le gae, khuetšo ya boloko bja dikhunkhwane godimo ga kaonafatšo ya mabu ka ga go tsošološa dithotobolo tša meepo go la Mpumalanga.
SRG e na le dikamano tše maatla le bašomišani ba ditšhabatšhaba le baithuti ba bona. Malobanyana baithuti ba bararo ba Welsh, maloko a sehlopha se le noši sa dikhunkhwane ka Afrika se se ngwadišitšwego ke Kopano ka ga Kgwebišano ka Mehuta ye e lego Kotsing, se feditše dikgwedi tše tharo godimo ga Matroosberg, ntlhora ye telelele ya thaba go la Kapa Bodikela, se ithuta ekholotši ya moswananoši le khunkhwane ya dinaka ye e lego kotsing. Mohuta wo o bewa kotsing ke, magareng a tše dingwe, go agwa ga ditora tša go fapana, go swana le ditora tša diselefounu, mo bodulong bja wona.
Professor Clarke Scholtz

Exceptional Young Researchers Uitnemende Jong Navorsers
Banyakišiši ba baswa bao ba Atleilego Kudu
This award is given to exceptional young achievers in the field of research, as seen against the University’s strategic goals of achieving academic excellence, international competitiveness and local relevance. Any person who has been evaluated by the NRF as a P-rated researcher automatically enjoys Exceptional Young Researcher status.
Hierdie toekenning word op grond van uitnemende prestasie aan jong akademici op die gebied van navorsing gemaak, gesien in die lig van die Universiteit se strategiese doelwitte van akademiese uitnemendheid, internasionale mededingendheid en plaaslike relevansie. Enige persoon wat deur die NNS as ‘n P-gegradeerde navorser geëvalueer word, verkry outomaties die status van ‘n Uitnemende Jong Navorser.
Banyakišiši ba baswa ba go Atlegilego go fetiša Sefoka se se abelwa baatlegi ba go tšwelela ka magetla lekaleng la dinyakišišo, bjalo ka ge go laeditšwe ka lenaneong la maano a Yunibesithi a go fihlelela bothakga, phenkgišano ya boditšhabatšhaba le maswanedi a selegae. Motho mang le mang yo a lekotšwego ke NRF bjalo ka monyakišiši wa maemo P o kgotsofatša dinyakwa tša gotsenela legoro la Monyakišiši o Moswa wa go atlega go fetiša.

Dr Barnes is a research fellow at the Forestry and Agricultural Biotechnology Institute (FABI) and the Department of Genetics in the Faculty of Natural and Agricultural Sciences, and is one of the research leaders in the Tree Protection Cooperative Programme (TPCP).
Her research interests include investigating the taxonomy, phylogenetics and population biology of fungal pathogens that infect forest trees. More specifically, her focus has been on developing novel molecular diagnostic tools to accurately and effectively identify fungal species in South Africa and globally, and to delineate cryptic species within fungal complexes. She has pioneered techniques to generate microsatellite markers used to study the population genetics of important tree pathogens such as species of Ceratocystis, Dothistroma and Teratosphaeria. These markers have been used to gain insight in the routes of invasion and pathways of movement that have led to the intercontinental spread of some of the world’s most detrimental forest pathogens.
Dr Barnes is actively involved in teaching and training postgraduate students and contributed to the establishment of the Postgraduate Student Association for Natural and Agricultural Sciences (PSANA) and the FABI mentorship programme. She has mentored 11 undergraduate students as part of this programme and has been involved in the supervision or co-supervision of seven BSc(Hons), six MSc and five PhD students. She has coordinated and presented international workshops on the identification and molecular characterisation of needle diseases, is a member of eight local and international scientific societies and has presented her research at national (21 presentations) and international (33 presentations) conferences. She has written 33 papers published in international peer-reviewed journals and has accumulated 589 citations.
Dr Barnes has been awarded the Merck Honours award, the S2A3 bronze medal for an outstanding MSc thesis, the Young Plant Pathologist award from the Southern African Society for Plant Pathology (three times), an Andrew W Mellon Foundation Scholarship and a Claude Leon Foundation postgraduate fellowship. Dr Barnes received an Y1 rating from the NRF.
Dr Barnes is ‘n navorsingsgenoot aan die Instituut vir Bosbou- en Landboubiotegnologie (FABI) en die Departement Genetika in die Fakulteit Natuur -en Landbouwetenskappe en een van die navorsingsleiers in die Boombeskermingsamewerkingsprogram (TPCP).
Haar navorsingsbelangstellings sluit in ‘n ondersoek na die taksonomie, filogenetika en bevolkingsbiologie van funguspatogene wat plantasies infekteer. Meer spesifiek val haar fokus op die ontwikkeling van nuwe molekulêre diagnostiese instrumente om fungusspesies in Suid-Afrika en wêreldwyd akkuraat en doeltreffend te identifiseer, en om kriptiese spesies binne funguskomplekse af te baken. Sy doen baanbrekerswerk om mikrosatellietmerkers te genereer wat gebruik word om die bevolkingsgenetika van belangrike boompatogene te bestudeer, soos spesies van Ceratocystis, Dothistroma en Teratosphaeria. Hierdie merkers word gebruik om insig te kry in die invals- en bewegingsroetes wat lei tot die interkontinentale verspreiding van party van die wêreld se skadelikste plantasie-patogene.
Dr Barnes is daadwerklik betrokke by die onderrig en opleiding van nagraadse studente en het bygedra tot die vestiging van die Nagraadse Studentevereniging vir Natuur- en Landbouwetenskappe (PSANA) en die FABI-mentorskapprogram. As deel van hierdie program het sy as mentor vir 11 voorgraadse studente opgetree; sy was ook betrokke by studieleiding of medestudieleiding van sewe BSc(Hons)-, ses MSc- en vyf PhD-studente. Sy het internasionale werkwinkels oor die identifisering en molekulêre karakterisering van siektes van naaldhoutbome gekoördineer en aangebied, is lid van agt plaaslike en internasionale wetenskaplike verenigings en het haar navorsing reeds op nasionale (21 aanbiedings) en internasionale (33 aanbiedings) konferensies aangebied. Sy het 33 referate in internasionale portuurbeoordeelde joernale gepubliseer en 589 sitasies gekry.
Dr Barnes het die Merck Honours-toekenning, die S2A3-bronsmedalje vir ‘n uitstaande MSc-verhandeling, die Jong Plantpatoloogtoekenning van die Suider-Afrikaanse Vereniging vir Plantpatologie (drie keer), ‘n beurs van die Andrew W Mellon-stigting en ‘n nagraadse studiebeurs van die Claude Leon-stigting ontvang. Dr Barnes het ‘n Y1-gradering van die NNS ontvang.
Ngaka Barnes ke Mogweramoleloko wa Dinyakišišo Institute ya Payotheknolotši le Kagodithokgwa ya Temo (FABI) le Kgoro ya Leabela, ebile ke yo mongwe wa baetapele ba dinyakišišo ba Lenaneo la Mokgatlo wa Tšhireletšo ya Mehlare.
Dikgahlego tša gagwe tša dinyakišišo di akaretša go nyakišiša theksonomi, leabela la matlakala le payolotši ya sehlopha ya dipatotšene tša fankase tšeo di fetelago mehlare ya sethokgwa. Go lebantšha thwii, nepišo ya gagwe e mo go tšweletšo ya didirišwa tša tshekatsheko ya molekhula ya moswananoši go hlaola mehuta ya fankase ka nepo le phethagalo ka Afrika Borwa le lefaseng ka bophara, le go hlaloša mehuta ye e širegilego ka gare ga dihlopha tša fankase. O bile ketapele ya dithekniki tša go tšweletša diswayi tša maekrosatelaete tše di šomišwago go ithuta leabela la dihlopha la dipatotšene tša bohlokwa tša mehlare go swana le mehuta ya Ceratocystis, Dothistroma le Teratosphaeria. Diswayi tše di be di dutše di šomišwa go fihlelela kwešišo ka mekgweng ya tlhaselo le ditseleng tša mosepelo woo o dirilego gore go be le phatlalalo ya go kgabaganya dikontinente ya tše dingwe tša dipatotšene tša sethokgwa tše di lego kotsi lefaseng.
Ngaka Barnes o ruta le go hlahla baithuti ba dialogadiglolwane tša godimo ka mafolofolo gape o kgathile tema tlhomong ya Mokgatlo wa Baithuti ba Dialogadigolwane ya Godimo ya Disaense tša Tlhago le Temo le go lenaneo la boeletši la FABI. O eleditše baithutelatikrii ba 11 bjalo ka karolo ya lenaneo le ebile o akareditšwe ka tlhahlong le tlhahlongmmogo ya baithuti ba šupa ba honase ya BSc, ba tshela ba MSc le ba bahlano ba PhD. O rulagantše le go bolela ditlhahlong tša ditšhabatšhaba ka ga tlhalošo ya molekhula le tlhaolomalwetši a matlakala a dimela (needle disease) ke moleloko wa mekgatlo ye seswai ya ditšhabatšhaba le ya ka nageng ya saense gape o boletše ka dinyakišišo tša gagwe dikhonferentsheng tša setšhaba (dipolelo tše 21) le tša ditšhabatšhaba (dipolelo tše 33). O ngwadile dipampiri tše 33 tše di gatišitšwego ka gare ga dijenale tše di sekasekilwego ke badirišane tša ditšhabatšhaba gape o kgobokeditše ditsopolwa tše 589.
Ngaka Barnes o filwe sefoka sa Tlhompho sa Merck, metale wa porontshe wa S2A3 wa thesese ya MSc ye kaone go fetiša, sefoka sa Rapatolotši wa Moswa wa Dimela go tšwa go Mokgatlo wa Afrika Borwa wa Patolotši ya Dimela (makga a mararo), Thekgo ya ditšhelete ya Mokgatlo wa Mellon le bodirišane bja dialagodiglolwane bja Mokgatlo wa Claude Leon. Ngaka Barnes o abetšwe maemo a Y1 go tšwa go NRF.
Dr Irene Barnes

Professor Emmambux is an associate professor in the Department of Food Science, Faculty of Natural and Agricultural Sciences. His research is broadly focused on African food biopolymers for nutrition and functional use. The main focus is on the chemistry of starch modification by using lipids for the ‘clean-label starches’ needed for the production of nano-materials; non-gelling high-viscosity starches for stabiliser and fat replacers; low glycaemic index foods; encapsulation of neutraceuticals; and biocomposites with other biopolymers. His main areas of interest are food chemistry, food rheology, spectroscopy, microscopy and nanotechnology. He is currently either supervising or co-supervising eight MSc and ten PhD students.
Professor Emmambux has published some 30 articles in peer-reviewed scientific journals, written two chapters that were included in a book and contributed to several conference proceedings and non-refereed journals. He also attended and presented posters and delivered oral presentations at several local and international workshops and conferences. During his PhD studies he received two awards for Best Poster Presentation at the International Cereal Science and Technology (ICC) conference. In 2009 he received a Young Scientist award from the International Union for Food Science and Technology (IUFoST). He also received the Dreosti award for the best oral presentation at the 2013 South African Association for Food Science and Technology International Conference (SAAFoST). The NRF awarded him a C2 rating.
Professor Emmambux is ‘n medeprofessor in die Departement Voedselwetenskap, Fakulteit Natuur- en Landbouwetenskappe. Sy navorsing is oor die algemeen toegespits op Afrika-voedselbiopolimere vir voeding en funksionele gebruik. Die hooffokus is op die chemie van styselmodifikasie deur die gebruik van lipiede vir die ‘skoonetiketstysels’ wat vir die produksie van nanomateriale nodig is; niejellende hoëviskositeitstysels vir stabiliseerder- en vetvervangers; voedsel met ʼn lae glisemiese indeks; enkapsulering van neutraseutiese stowwe; en biosamestellings met ander biopolimere. Sy vernaamste belangstellings is voedselchemie, voedselreologie, spektroskopie, mikroskopie en nanotegnologie. Hy is tans studieleier of medestudieleier vir agt MSc- en tien PhD-studente. Professor Emmambux het al sowat 30 artikels in portuurbeoordeelde wetenskaplike joernale gepubliseer, twee hoofstukke geskryf wat in ‘n boek opgeneem is en bygedra tot verskeie konferensieverrigtinge en niebeoordeelde joernale. Hy het ook verskeie plaaslike en internasionale werkwinkels en konferensies bygewoon en plakkate en mondelinge aanbiedings daar gelewer. Tydens sy PhD-studie het hy twee toekennings vir Beste Plakkaataanbieding op die Internasionale Graankunde en Tegnologie-konferensie ontvang. In 2009 het hy ‘n Jong Wetenskaplike-toekenning van die Internasionale Unie vir Voedselwetenskap en Tegnologie (IUFoST) ontvang. Hy het in 2013 ook die Dreosti-toekenning ontvang vir die beste mondelinge aanbieding tydens die Suid-Afrikaanse Genootskap vir Voedselwetenskap en Tegnologie (SAAFoST) se internasionale konferensie. Die NNS het ‘n C2-gradering aan hom toegeken.
Profesa Emmambux ke mothuša profesa ka Kgorong ya Disaense tša Dijo, Lefapha la Disaense tša Tlhago le Temo. Nyakišišo ya gagwe e nepišitše ka bophara go dipayopholamese tša dijo tša Seafrika tša tšhomišo ya phepo le mohola. Nepišo ye kgolo e go khemistri ya phetošo ya setatšhe ka go šomiša makhura a ‘clean-label starches’ ao a hlokegago go tšweletša dimateriale tša nano; ditatšhe tša go se kgomagane tša tanyo ya godimo tša go tiiša le go bea bakeng ga makhura; dijo tšeo di nago le leswao la fase la klaekhamiki; kakaretšo ya dijo tša phepo le kalafo; le payokhomphosaete le dipayopholamese. Kgahlego ya gagwe ye kgolo e go khemistri ya dijo, reolotši ya dijo, spektroskopi, maekroskopi le nanotheknolotši. Ga bjale o lekola goba go lekola mmogo baithuti ba seswai ba MSc le baithuti ba lesome ba PhD.
Profesa Emmambux o phatlaladitše diathekele tše 30 ka ditšenaleng tša saense tšeo di lekotšwego ke badirišane, o ngwadile dikarolo tše pedi tšeo di akareditšwego pukung gomme o tšere karolo mo ditshepedišong tše mmalwa tša dikhonferense le ditšenale tšeo di se a lekolwago. O tsenetše gape le go aba diphoustara le go fa dikabo tša molomo mo ditlhahlong le dikhonferenseng tša gae le tša ditšhabatšhaba. Nakong ya dithuto tša gagwe tša PhD o amogetše difoka tše pedi tša Kabo ye Kaone ya Diphoustara mo khonferenseng ya Disaense tša Diderele tša Ditšhabatšhaba le Theknolotši. Ka 2009 o amogetše sefoka sa Ramahlale yo Monyane go tšwa Mokgatlong wa Ditšhabatšhaba wa Saense ya Dijo le Theknolotši. O amogetše gape sefoka sa Dreosti sa kabo ye kaone ya molomo mo Khonferense ya Ditšhabatšhaba ya Mokgatlo wa Afrika Borwa wa Disaense tša Dijo le Theknolotši. NRF e mo abetše tekanyo ya C2.
Professor Naushad Emmambux

Teaching Excellence and Innovation
Laureate Awards
Laureaattoekennings vir Uitnemendheid in Onderrig en Innovasie
Difoka tša Bahlomphegi tša Bokgoni bja Thuto
le Tšwetšopele Difoka tša Laureate tša Bokgoni
bja go Ruta le Botšo
The Laureates are awarded to nominated projects that display teaching practices with clear purpose and intent, with strong alignment between the different elements in the broader context, that address identified needs or gaps with the aim of innovation to optimise teaching and learning. These nominations show significant evidence of impact on student learning, are sustainable and can be replicated in other contexts. These projects contribute to best practice in teaching and display significant evidence of innovation that addresses the identified challenges.
Die Laureaattoekennings word gemaak aan genomineerde projekte wat bewys lewer van onderrigpraktyke met duidelike doelwitte en goeie belyning tussen die verskillende elemente in die breër konteks, wat spesifieke behoeftes of gapings aanspreek en innovasie ten doel het om onderrig en leer te optimaliseer. Hierdie nominasies lewer betekenisvolle bewys van impak op studente-leer, is volhoubaar en kan in ander kontekste herhaal word. Die projekte dra by tot beste praktyk in onderrig en toon innovasie wat geïdentifiseerde uitdagings aanspreek.
Ba Laureates ba abetšwe go kgetho ya diprotšeke tšeo di bontšhago ditirišo tša go ruta ka maikemišetšo ao a bonagalago le go ikemišetša, ka peakanyo ya go tia gare ga dikokwane tša go fapana ditikologong ka bophara, tšeo di šoganago le dinyakwa tše di lemogilwego goba dikgoba ka maikemišetšo a botšo a go kaonafatša go ruta le go ithuta. Dikgetho tše di bontšha bohlatse bjo bohlokwa bja khuetšo mo go ithuteng ga baithuti, e a thekgwa gomme e ka dirišwa ditikologong tše dingwe. Protšeke tše di kgatha tema go tirišo ye botse ya go ruta gomme di bontšha bohlatsebjo bohlokwa go botšo bjo šoganago le ditlhotlo tše di lemogilwego.

From dread to delight with undergraduate module Microcontrollers EMK310
Professor Tania Hanekom joined the Department of Electrical, Electronic and Computer Engineering, in the Faculty of Engineering, Built Environment and Information Technology in 1999. Her research in biomedical engineering is focused on the computational modelling of the electrode–neural interface in cochlear implants.
In 2005 she was assigned to the undergraduate module, Microcontrollers EMK310, which covered aspects of microcontroller system design. Owing to the exploding digital device market it has become essential to equip more engineering graduates with embedded design skills. The module had to be redesigned to address this need while empowering students to excel in the embedded design industry. The main innovations in the module support effective teaching and learning in microcontroller systems within the context of large classes.
Since embedded design includes almost every available technological innovation, the scope of the module was restructured to cover microcontroller architecture and programming, as well as the real-world interface with microcontroller systems. The lecturing style and assessment strategy were redesigned to support a hands-on approach that requires students to integrate and apply engineering skill sets to solve technical problems.
To accommodate large student numbers, automatic grading software (AGS) was developed to grade students’ code answers. The AGS is based on the Microchip MPLAB X SDK test bench and is, to our knowledge, the only automatic grading system in the world that is based on this technology.
Finally, because of the high standards that are maintained, students started to dread the module. To change their perception and to create excitement and anticipation, the practical component of the module was redesigned to enable them to develop autonomous line-following robots that compete at the end-of-semester Race Day (http://www.ee.up.ac.za/main/emk310/index). This created a positive change as it generated an opportunity to complete a comprehensive engineering project from first principles and to involve industry through sponsorship and attendance of the event.
Omsetting tot geesdrif vir die voorgraadse module, Mikrobeheerders EMK310
Professor Tania Hanekom het in 1999 by die Departement Elektriese, Elektroniese en Rekenaaringenieurswese, in die Fakulteit Ingenieurswese, Bou-omgewing en Inligtingtegnologie aangesluit. Haar navorsing in biomediese ingenieurswese is toegespits op die rekenaarmodellering van die elektrode–neurale koppelvlak in kogleêre inplantings.
In 2005 is sy in beheer geplaas van die voorgraadse module, Mikrobeheerders EMK310 wat aspekte van mikrobeheerstelselontwerp gedek het. Vanweë die ontploffing in digitale toestelle het dit noodsaaklik geword om meer ingenieursgraduandi met vasgelegde ontwerpvaardighede toe te rus. Die module moes herontwerp word om hierdie behoefte aan te spreek en terselfdertyd studente toe te rus om in die vasgelegde ontwerpnywerheid uit te blink. Die belangrikste innovasies in die module, het ten doel om doeltreffende onderrig en leer in mikrobeheerstelsels in die konteks van groot klasse te ondersteun.
Aangesien vasgelegde ontwerp feitlik elke beskikbare tegnologiese innovasie insluit, is die omvang van die module geherstruktureer om naas mikrobeheerderargitektuur en -programmering, ook die werklike koppelvlak met mikrobeheerstelsels in te sluit. Die wyse waarop lesings aangebied is en assesseringstrategie herontwerp is, steun ’n praktiese benadering wat vereis dat studente tegniese probleme oplos deur hul ingenieursvaardighede te integreer en toe te pas.
Ten einde groot studentetalle te kan akkommodeer, is outomatiese graderingsagteware (OGS) ontwikkel om studente se kodeantwoorde te gradeer. Die OGS is gebaseer op die Microchip MPLAB X SDK-toetsbank en is, so ver ons weet, die enigste outomatiese graderingstelsel ter wêreld wat op dié tegnologie berus.
Uiteindelik het die hoë standaarde wat gehandhaaf word, veroorsaak dat studente teen die module begin opsien het. Om hul persepsie te verander en om opwinding en verwagting te skep, is die praktiese komponent van die module hersien om hulle in staat te stel om outonome robotte te ontwikkel wat ’n lyn kan volg en aan die einde van die semester op Resiesdag kan kompeteer (http://www.ee.up.ac.za/main/emk310/index). Dit het ’n positiewe verandering teweeggebring, aangesien dit ’n geleentheid geskep het om vanaf eerste beginsels in ’n omvattende ingenieursprojek mee te ding en om die nywerheid deur middel van borgskappe en bywoning te betrek.
Moprofesa Tania Hanekom o thomile go šoma ka Kgorong ya Mohlagase, Boentšenere bja Elektroniki le Khomphutha ka 1999. Nyakišišo ya gagwe ka boentšenere bja kalafo le payolotši e lebišitše go go mmotlola wa khomphutha wa mollwane wa elekrote–nyurale ka gare ga diimpolante tša khotlea (karolo ya ka gare ya tsebe).
Ka 2005 o ile a abelwa motšule wo e sego wa dialoga, Microcontrollers EMK310, woo o bego o akaretša dintlha tša tlhamo tša mokgwa wa maekrokontrolara. Go ya ka mmaraka wa didirišwa tša ditšitale wo o golago ka lebelo go bile bohlokwa go tlamela dialoga tše ntši tša boenetšenere ka mabokgoni a tlhamo ao a akareditšwego. Motšule o ile wa swanela ke go hlangwaleswa go šogana le nyakego ye mola o matlafatša baithuti gore ba be le bokgoni ka intastering ya tlhamego ye e akareditšwego. Dikaonafatšo tše kgolo ka gare ga motšule di thekga go ithuta le go ruta wo botse ka mekgwa ya maekrokontrolara ka gare ga maemo a magoro a magolo.
Ka ge tlhamo ye e akareditšwego e akaretša kaonafatšo ya theknolotši ye nngwe le ye nngwe ye e lego gona, skoupu sa motšule se beakantšweleswa go akaretša tlhamo ya maekrokontrolara le tlhamo ya softewere, le mollwane wa mmakgonthe wa go ba le disesteme tša maekrokontrolara. Mohuta wa bofahloši le leano la kelo di hlamilweleswa go thekga mokgwa wa go dira ka noši woo o nyakago gore baithuti ba kopanye le go šomiša sete ya bokgoni bja boentšenere go rarolla mathata a sethekniki.
Go akaretša palo ye kgolo ya baithuti, softwere ya peo go ya ka maemo ya go itiriša (AGS) e tšweleditšwe go bea ka maemo dikarabo tša khouto tša baithuti. AGS e theilwe godimo ga bodirela teko bja Maekrotšhipi MPLAB X SDK gomme go ya ka tsebo ya rena, ke mokgwa o le noši wa go bea ka maemo wa go itiriša mo lefaseng woo o theilwego godimo ga theknolotši ye.
Sa mafelelo, ka lebaka la maemo a godimo ao a sa fetolwego, baithuti ba thomile go tšhoga motšule. Go fetola kgopolo ya bona le go hlohleletša kgahlego le tetelo, karolo ya tirišo ya motšule e hlamilweleswa go kgontšha go tšweletšwa ga diroboto tše dilatelago mothaladi tše di ikemetšego tšeo di phadišanago mafelelong a Letšatši la Tšhiano la semestara (http://www.ee.up.ac.za/main/emk310/ index). Se se tlišitše phetogo ye botse ka ge e tšweleditše monyetla wa go feleletša protšeke ya boentšenere ya kakaretšo go tšwa go melawana ya mathomo le go akaretša intasteri ka thekgo ya ditšhelete le tsenelo ya tiragalo.
Professor Tania Hanekom | Individual winner | Individuele wenner | Mofenyi yo motee

Mamelodi merits: not only stepping stones, but a cornerstone for independent learning
Thea Corbett and Christine Kraamwinkel teach statistics to students in the BSc Extended Programme on the Mamelodi Campus. This programme provides access to science and science-based study programmes by setting lower entrance requirements and offering intensive support in order to prepare students for further studies in mainstream programmes.
Thea and Christine present subject content by applying a variety of methods designed to remedy possible gaps, focus on understanding and develop critical thinking and practical skills. Progress is continuously assessed to meet the required levels of academic performance. In the first phase of this programme, content is presented at a slower pace to provide ample opportunities for improvisation and innovation, thereby allowing for an assessment model that specifically targets students’ approach to learning. This is achieved by the appropriate structuring of a variety of assessment opportunities and constructive alignment to desired learning outcomes, based on a balanced mixture of ideas, connections and extension levels of learning and thinking. It is their belief that this model has the potential to positively influence students’ approach to learning towards adopting deep learning, which is the key to high levels of statistical literacy, reasoning and thinking, and produces quality graduates. Inquiry-based project work is at the centre of this innovation. This activity culminates in predominantly higher-level responses, such as connections and extensions, through constructively focused input from flipped classroom large-group lectures, student-driven small-group tutorials and computer-based practical blended learning sessions. Extremely satisfactory student results, overwhelmingly positive student feedback and healthy retention rates bear testimony to the first important steps taken in instigating independent learning and a research culture in line with UP’s status as a researchintensive university.
Thea said that she considers it a privilege to lead this reflective practice which is informed, through scholarly research, by teaching and learning theories. She acknowledges the role of Bettie Basson, now retired, as instrumental in the launch of a revised curriculum in 2012 and commends Christine Kraamwinkel for her passion in promoting the innovation and its sustained application. The team enjoys the unwavering and enthusiastic support of Professor Andriette Bekker, Head of the Department of Statistics, and Dr Quenton Kritzinger, Director of the four-year programme on the Mamelodi Campus.
Mamelodi-meriete: nie net trapklippe nie, maar ’n hoeksteen vir onafhanklike leer
Thea Corbett en Christine Kraamwinkel onderrig studente in statistiek as deel van die Uitgebreide BSc-program op die Mamelodikampus. Hierdie program bied toegang tot wetenskap en wetenskapgebaseerde programme deur laer toelatingsvereistes te stel en intensiewe ondersteuning te bied om studente op verdere studie in hoofstroomprogramme voor te berei.
Thea en Christine bied vakinhoud aan deur ’n verskeidenheid metodes toe te pas wat ontwerp is om moontlike leemtes aan te vul, op begrip te fokus en kritiese denke en praktiese vaardighede te ontwikkel. Vordering word aaneenlopend geassesseer om die vereiste akademiese prestasievlakke te bereik. In die eerste fase van die program word die inhoud teen ’n stadiger tempo aangebied om baie geleenthede vir improvisasie en innovasie te bied en sodoende ruimte te laat vir ’n assesseringsmodel wat spesifiek op studente se benadering tot leer ingestel is. Dit word gedoen deur die toepaslike strukturering van ’n verskeidenheid assesseringsgeleenthede en konstruktiewe belyning met gewenste leeruitkomste wat op ’n gebalanseerde vermenging van idees, verbindings en uitbreidingsvlakke van leer en dink berus. Hulle glo dat hierdie model die potensiaal het om studente se benadering tot leer positief te beïnvloed en hulle sal aanspoor om diepleer te aanvaar, wat die sleutel is tot hoë vlakke van statistiese geletterdheid, redenasie en denke, en graduandi van ’n goeie gehalte lewer. Ondersoekgebaseerde projekwerk is die kern van hierdie innovasie. Hierdie aktiwiteit lei uiteindelik tot oorwegend hoëvlakresponse, soos verbindings en uitbreidings, deur konstruktief gefokusde insette van omgekeerde klaskamer-grootgroeplesings, studentgedrewe kleingroepstudieklasse en rekenaargebaseerde praktiese gemengde leersessies. Studente se uiters bevredigende resultate, oorweldigend positiewe terugvoer en gesonde retensiesyfers getuig daarvan dat die eerste belangrike stappe gedoen is om onafhanklike leer en ’n navorsingskultuur aan te moedig, wat ooreenstem met UP se status as ’n navorsingsintensiewe universiteit.
Thea sê sy beskou dit as ’n voorreg om hierdie reflektiewe praktyk te lei wat deur deskundige navorsing oor onderrig- en leerteorieë beïnvloed word. Sy gee erkenning aan Bettie Basson, wat reeds afgetree het, vir haar deurslaggewende rol in die bekendstelling van ’n hersiene kurrikulum in 2012, en loof Christine Kraamwinkel vir die geesdrif waarmee sy die innovasie en die volgehoue toepassing daarvan bevorder. Die span geniet die onwrikbare en geesdriftige steun van professor Andriette Bekker, Hoof van die Departement Statistiek, en dr Quenton Kritzinger, Direkteur van die vierjaarprogram op die Mamelodikampus.
Mabokgoni a Mamelodi: ga se fela manamelo, eupša motheo wa go ithuta wo o ikemetšego
Thea Corbett le Christine Kraamwinkel ba ruta baithuti dipalopalo ka go Lenaneo la BSC le le Katološitšwego Khamphaseng ya Mamelodi. Lenaneo le le fa phihlelelo go mananeo a thuto ao a theilwego go saense ka go bea dinyakwa tša fase tša kamogelo le go fa thekgo ye e tseneletšego go lokišetša baithuti go tšwela pele ka dithuto tša mananeo a tlwaelo.
Thea le Christine ba ruta dikagare tša thuto ka go šomiša mekgwa ya go fapana ye e diretšwego go tswalela dikgoba tše di kago ba gona, go lebantšha go kwešišo le go hlabolla kgopodišišo le mabokgoni a tirišo. Tšwelopele e tšwela pele go sekasekwa go fihlelela maemo ao a nyakwago. Mo kgatong ya mathomo ya lenaneo le, dikagare di rutwa ka go nanya go fa sebaka se se lekanego sa tlhamo le kaonafatšo, ka gona go dumelela tshekatsheko ya mmotlolo woo o lebantšhago thwii go mokgwa wa baithuti wa go ithuta. Se se fihlelelwa ka peakanyo ya maleba ya dibaka tša tshekatsheko le peakanyo ye e holago ya go fapana go dipoelo tša go ithuta tše di nyakwago, go ya ka motswako wo o lekantšwego wa dikgopolo, maemo a dikopantšho le dikoketšo tša go ithuta le go nagana. Ke tumelo ya bona gore mmotlolo wo o na le bokgoni bja go huetša mokgwa wa baithuti go go ithuta gabotse go ya go kamogelo ya go ithuta wo go tseneletšego, woo o lego bohlokwa go ya go maemo a go thewa godimo ga bokgoni bja go bala le go ngwala bja dipalopalo, go fahlela le go nagana, le go tšweletša dialoga tša boleng. Mošomo wa protšeke wo o theilwego godimo ga nyakišišo o bohlokwa go kaonafatšo ye. Mošomo wo o felela gagolo ka diphetolo tša maemo a godimo, go swana le dikopantšho le dikoketšo, ka phetolo ye botse ye e lebantšwego go tšwa go dithuto tša dihlopha tše kgolo tša phapošiborutelo ye e fetotšwego ka lebelo, dithuto tša dihlopha tše nnyane tše di etwago pele ke baithuti le dikopano tša go ithuta tše di kopantšwego le tirišo ye e theilwego godimo ga khomphutha. Dipoelo tša baithuti tše di kgotsofatšago go fetiša, dipoelo tša baithuti tše di botse go fetiša le kelo ye botse ya tshwaro e bea bohlatse go dikgato tše bohlokwa tša mathomo tše di tšerwego tlhohleletšong ya go ithuta wo o ikemetšego le setšo sa dinyakišišo sa go sepetšana le maemo a UP bjalo ka yunibesithi ya dinyakišišo tše di tsenelelago. Thea o boletše gore o bona e le tokelo ya go eta pele setlwaedi sa go gopodišiša seo se sedimošwago, ka nyakišišo ya thuto, ke diteori tša go ruta le go ithuta. O amogela karolo ya Bettie Basson, yo bjale a rotšego modiro, bjalo ka ye bohlokwa thakgolong ya kharikhulamo ye e fetotšwego ka 2012 gape leboga Christine Kraamwinkel ka lerato la gagwe la go godiša tšwetšopele le tirišo ya yona ye e swarelelago. Sehlopha se ipshina ka thekgo ye e sa fokolego le mafolofolo tša Profesa Andriette Bekker, Hlogo ya Kgoro ya Dipalopalo, le Dr Quenton Kritzinger, Molaodimogolo wa lenaneo la mengwaga ye mene Khamphaseng ya Mamelodi.
Ms Thea Corbett | Ms Christine Kraamwinkel Team winners | Spanwenners | Bafenyi ba sehlopha

Ms Thea Corbett | Ms Christine Kraamwinkel Faculty of Natural and Agricultural Sciences
Fakulteit Natuur- en Landbouwetenskappe
Lefapha la Disaense tša Tlhago le Temo
Community Engagement Award
Toekenning vir Gemeenskapsbetrokkenheid
Sefoka sa Tlemagano ya Setšhaba
The Community Engagement Award was instituted for 2014 and will be awarded annually to one individual to recognise community engagement as a long-standing and valued tradition in higher education and an extensive, high-impact practice in teaching at the University of Pretoria. The criteria for the award are aligned to those for the MacJannet Award, which is administered by the international Talloires Network. The Vice-Chancellor and Principal, Professor Cheryl de la Rey is vice-chairperson of the Talloires Network executive committee.
Die Toekenning vir Gemeenskapsbetrokkenheid, wat jaarliks aan een persoon toegeken sal word, is vir 2014 ingestel om erkenning te gee aan gemeenskapsbetrokkenheid as ’n ou en gewaardeerde tradisie in hoër onderwys en ’n uitgebreide, hoë-impakpraktyk in onderrig by die Universiteit van Pretoria. Die kriteria vir die toekenning is belyn met dié vir die MacJannet-toekenning, wat deur die internasionale Talloires-netwerk geadministreer word. Die Visekanselier en Rektor, professor Cheryl de la Rey, is ondervoorsitter van die uitvoerende komitee van dié netwerk.
Sefoka sa Go tšea Karolo Setšhabeng se thometšwe ngwaga wa 2014 gomme se tla abja ngwaga ka ngwaga go motho o tee go lemoga go tšea karolo setšhabeng ga gagwe bjalo ka setlwaedi sa lebaka le le telele le seo se nago le mohola mo thutong ya godimo le mokgwa wa khuetšo ya godimo, ye e nabilego tirišong ya go ruta mo Yunibesithing ya Pretoria. Mabaka a sefoka a amantšhwa le a Sefoka sa MacJannet, seo se laolwago ke Talloires Network. Motlatšamokhanseliri le Hlogo, Profesa Cheryl de la Rey ke motlatšamodulasetulo wa leloko la komitiphethiši ya Talloires Network.

The Community-based Project Module in the Faculty Engineering, Built Environment and Information Technology
The Community-based Project (JCP) module is a flagship module of the Faculty of Engineering, Built Environment and Information Technology and was accredited by the Engineering Council of South Africa (ECSA) in 2006 and 2012. It was, and still is, the first of its kind in the disciplines of engineering, the built environment and information technology in South Africa and provides all undergraduate students with a structured, educationally sound experience in community engagement.
The JPC module received recognition via an Education Innovation Award (2006), was a finalist for the MacJannet Prize (2010) of the international Tailloires Network and won the Marketing Advancement and Communication in Education (MACE) Excellence Award in the category Integrated Campaigns/Projects and the subcategory Social Responsibility and Citizenship Development (2014). The module was used as an example of a blended learning approach for a service-learning module for non-service-related courses in a textbook about service learning in South Africa. The success of the module is reflected in the positive feedback from communities and students. Between 2005 and 2007, when the project was still in its pilot phase, more than 13 160 students were involved in 4 260 projects. In 2014, 1 687 students worked on 556 projects with 394 campus–community partners. The YouTube videos produced by the students were viewed by thousands of people in 2013 and 2014 and provided the University with international exposure. Although the scale of the module makes it a challenging endeavour, it is managed very professionally by the lecturer, Dr Martina Jordaan.
Dr Martina Jordaan
Dr Jordaan completed her BPrimEd (Senior Primary), BA(Hons) (History), MA (History) and DPhil (History) degrees at the University of Pretoria before obtaining a Higher Education Diploma (Pre-primary) at the South African College for Teacher Education and a master’s degree in Development Studies at the University of the Free State. She is a senior lecturer in the Community-based Project module and is solely responsible for curriculum development, lecturing, student assessment and managing the module. She is assisted by an administrative clerk who manages the project funds received by individual students and the CEMS (Global Alliance in Management Education) programme.
Die Gemeenskapsgebaseerde Projekmodule in die Fakulteit Ingenieurswese, Bou-omgewing en Inligtingtegnologie
Die Gemeenskapsgebaseerde Projek (JPC)-module is ’n vlagskipmodule van die Fakulteit Ingenieurswese, Bou-omgewing en Inligtingtegnologie en is in 2006 en 2012 deur die Suid-Afrikaanse Raad vir Ingenieurswese (ECSA) geakkrediteer. Dit was, en is steeds, die eerste van sy soort in die dissiplines ingenieurswese, die bou-omgewing en inligtingtegnologie in Suid-Afrika en verskaf aan alle voorgraadse studente ’n gestruktureerde en opvoedkundig sterk ervaring in gemeenskapsbetrokkenheid.
Die JPC-module is bekroon met ’n Onderwysinnovasietoekenning (2006), was ’n finalis vir die MacJannet-prys (2010) van die internasionale Tailloires Netwerk en was die wenner van die Toekenning vir Uitnemendheid in Bemarkingsbevordering- en Kommunikasie in Onderwys (MACE) in die kategorie Geïntegreerde Veldtogte/Projekte en die subkategorie Maatskaplike Verantwoordelikheid en Burgerskapontwikkeling (2014). Die module is in ’n handboek oor diensleer in Suid-Afrika gebruik as voorbeeld van ’n gemengde-leerbenadering vir niediensverwante kursusse. Die sukses van die module blyk uit die positiewe terugvoer van studente en gemeenskappe. Tussen 2005 en 2007, toe die projek nog in sy loodsfase was, was meer as 13 160 studente in 4 260 projekte daarby betrokke. In 2014 het 1 687 studente saam met 394 kampusgemeenskapsvennote aan 556 projekte gewerk. Die YouTube video’s wat deur die studente gemaak is, is in 2013 en 2014 deur duisende mense besigtig en het aan die Universiteit internasionale blootstelling besorg. Hoewel die skaal van die module dit ’n uitdagende onderneming maak, word dit baie professioneel deur die dosent, Dr Martina Jordaan, bestuur.
Dr Martina Jordaan
Dr Jordaan het die grade BPrimEd (Senior Primêr), BA(Hons) (Geskiedenis), MA (Geskiedenis) en DPhil (Geskiedenis) aan die Universiteit van Pretoria verwerf voordat sy ’n Hoër-Onderwysdiploma (Pre-primêr) by die Suid-Afrikaanse Onderwyskollege en ’n meestersgraad in Ontwikkelingstudies by die Universiteit van die Vrystaat voltooi het. Sy is ’n senior dosent in die Gemeenskapsgebaseerde Projekmodule en is alleen verantwoordelik vir kurrikulumontwikkeling, die aanbied van lesings, die assessering van studente en die bestuur van die module. Sy word bygestaan deur ’n administratiewe klerk wat die projekfondse wat deur individuele studente en die CEMS (Global Alliance in Management Education)-program ontvang word, bestuur.
Motšule wa Protšeke ye e theilwego Setšhabeng ka gare ga Lefapha la Boentšenere, Tikologokago le Theknolotši ya Tshedimošo
Motšule wa Protšeke ye e theilwego Setšhabeng(JCP) ke motšule wa ketapele wa Lefapha la Boentšenere, Tikologokago le Theknolotši ya Tshedimošo gomme o dumeletšwe ke Lekgotla la Boentšenere la Afrika Borwa (ECSA) ka 2006 le 2012. Ke wa, ebile e sa le, wa mathomo wa mohuta wa wona ka makaleng a boentšenere, tikologokago le theknolotši ya tshedimošo ka Afrika Borwa gomme o fa baithuti ka moka ba ba sešogo ba aloga boitemogelo bjo bo kwešišegago thutong, bjo bo hlophilwego ka tlemagano ya setšhaba.
Motšule wa JPC o amogetše kamogelo ka Sefoka sa Tšwetšopele sa Thuto (2006), o bile go makgaolakgang a Sefoka sa MacJannet (2010) gomme o fentše Sefoka sa Bokgoni bja Tšwetšopele ya Papatšo le Kgokagano ka Thuto (MACE) ka legorong la Masolo/Diprotšeke le le Kopantšwego le ka legorwaneng la Tlhabollo ya Bodudi bja Maikarabelo a Leago (2014). Motšule o šomišitšwe bjalo ka mohlala wa mokgwa wa go ithuta wo o kopantšwego wa motšulo wa dikhoso tše di sa amanego le tirelo ka gare ga puku ya go bala ka ga go ithuta tirelong ka Afrika Borwa. Katlego ya motšule e laeditšwe ka gare ga dipoelo tše di botse go tšwa ditšhabeng le baithuting. Gare ga 2005 le 2007, ge protšeke e be e sa le maemong a teko ya yona, baithuti ba go feta ba 13 160 ba kgathile tema ka diprotšekeng tše 4 260. Ka 2014, baithuti ba 1 687 ba šomile go diprotšeke tše 556 le bašomišani ba go fapana ba setšhaba sa khamphase ba 394. Dibideo tša YouTube tše di tšweleditšwego ke baithuti di bonwe ke diketekete tša batho ka 2013 le 2014 gomme di file Yunibesithi sebaka sa gore e tsebege maemong a boditšhatšhaba. Le ge sekala sa motšule se o dira gore e be kgato ye e nago le tlhohlo, o sepetšwa seprofešenale kudu ke mofahloši, Dr Martina Jordaan.
Dr Martina Jordaan
Dr Jordaan o phethile mangwalo a gagwe a thuto a BPrimEd (Poraemari ye Kgolo), BA(Hons) (Histori), MA (Histori) le DPhil (Histori) Yunibesithing ya Pretoria pele a amogela Diploma ya Thuto ya Godingwana (Pele ga Poraemari) Kholešeng ya Afrika Borwa ya Thuto ya Borutiši le le lengwalo la mastase ka Dithuto tša Tlhabollo Yunibesithi ya Freistata. Ke mofahlošimogolo wa motšule wa Protšeke ye theilwego Setšhabeng gomme ke yena fela a rwelego maikarabelo a go tšweletša kharikhulamo, go ruta, go leka baithuti le go laola motšule. O thušwa ke mohlankedi wa tshepedišo yoo a sepetšago matlotlo a protšeke ao a amogelwago ke baithuti mongwe le mongwe le lenaneo la CEMS (Mokgatlo wa Lefase ka Thuto ya Taolo).
Dr Martina Jordaan

2015 NRF-rated Researchers
2015 NNS-gegradeerde Navorsers
Banyakišiši ba 2015 bao ba lekaneditšwego ke Motheo wa Dinyakišišo wa Setšhaba
New A-rated Researchers
Nuwe A-gegradeerde Navorsers
Banyakišiši ba baswa ba 2015 bao ba lekaneditšwego maemong a A

Professor Engelbrecht is a professor in and Head of the Department Computer Science in the Faculty of Engineering, Built Environment and Information Technology. He is the current incumbent of the South African Research Chairs Initiative (SARChI) Chair in Artificial Intelligence.
His research focuses mainly on computational intelligence and his particular areas of interest are computational swarm intelligence, evolutionary computation, artificial neural networks, artificial immune systems, and learning from zero-knowledge using competitive coevolution. Algorithmic models of these phenomena from nature are applied to solve complex optimisation problems, including problems where the search landscape dynamically changes over time, where multiple conflicting objectives have to be optimised simultaneously, and where multiple solutions have to be found and tracked in dynamically changing environments.
His work on particle swarm optimisation (PSO), which was based on models of bird-flocking behaviour, has received significant recognition. Ground-breaking work was done with the development of PSO algorithms to solve binary-valued optimisation problems in continuous-valued space with a fixed small dimension. The first efficient PSO algorithms were developed to solve optimisation problems where solutions are represented using mathematical sets instead of vectors. New PSO algorithms have also been developed to solve dynamic multi-objective optimisation problems, cluster non-stationary data, predict the secondary structure of RNA and perform multiple-sequence alignments. Professor Engelbrecht is well recognised for his work on cooperative and competitive coevolutionary PSO algorithms. His research also provided some of the first theoretical analyses of PSO and its convergence properties. Recent research produced new PSO algorithms to train neural networks in the presence of concept drift and combine evolutionary operators from evolutionary algorithms with PSO.
Professor Engelbrecht recently worked in the field of swarm robotics, developing approaches to control a swarm of simple stimulus–response robots to perform a very complex task. These approaches are based on the foraging behaviour of honey bees and desert ants. His recent work on fitness landscape analysis and its application in determining the complexity of optimisation problems and predicting the level of success of optimisation algorithms is rapidly gaining recognition. Prof Engelbrecht received an A2 rating from the NRF.
Professor Engelbrecht is professor in en Hoof van die Departement Rekenaarwetenskap in die Fakulteit Ingenieurswese, Bouomgewing en Inligtingtegnologie. Hy is die huidige bekleër van die Suid-Afrikaanse Navorsingsleerstoelinisiatief (SARChI)-leerstoel in Kunsmatige Intelligensie.
Sy navorsing fokus hoofsaaklik op die volgende: “computational intelligence and his particular areas of interest are computational swarm intelligence, evolutionary computation, artificial neural networks, artificial immune systems, and learning from zero-knowledge using competitive coevolution. Algorithmic models of these phenomena from nature are applied to solve complex optimisation problems, including problems where the search landscape dynamically changes over time, where multiple conflicting objectives have to be optimised simultaneously, and where multiple solutions have to be found and tracked in dynamically changing environments.”
Sy werk oor partikelswermoptimering (PSO), wat op modelle van die gedrag van voëlswerms gebaseer is, ontvang beduidende erkenning. Baanbrekerswerk is gedoen met die ontwikkeling van PSO-algoritmes om optimeringsprobleme met binêre veranderlikes op te los in ‘n wisselpunt getalle ruimte met ‘n vaste klein dimensie. Die eerste doeltreffende PSO-algoritmes is ontwikkel om optimeringsprobleme op te los waar oplossings deur wiskundige versamelings voorgestel word in plaas van vektore. Nuwe PSOalgoritmes is ook ontwikkel om dinamiese veeldoelige optimeringsprobleme op te los, niestasionêre data te groepeer, die sekondêre struktuur van RNS te voorspel en veelvuldige reeksbelynings te doen. Professor Engelbrecht word wyd erken vir sy werk oor samewerkende en mededingende mede-evolusionêre PSO-algoritmes. Sy navorsing het ook van die eerste teoretiese analise van PSO en die konvergensie-eienskappe daarvan opgelewer. Onlangse navorsing het nuwe PSO-algoritmes opgelewer om neurale netwerke in die teenwoordigheid van konsepverskuiwing op te lei en kombineer evolusionêre operatore van evolusionêre algoritmes met PSO.
Professor Engelbrecht het onlangs op die gebied van swermrobotika gewerk en het benaderings ontwikkel om ‘n swerm eenvoudige stimulus–reaksie-robotte te beheer om ‘n baie ingewikkelde taak te verrig. Hierdie benaderings is op die kossoekgedrag van heuningbye en woestynmiere gebaseer. Sy onlangse werk oor soekruimte analise en die toepassing daarvan in die bepaling van die kompleksiteit van optimeringsprobleme en die voorspelling van die vlak van sukses van optimeringsalgoritmes is besig om vinnig veld te wen. Prof Engelbrecht het ‘n A2-gradering van die NNS ontvang.
Moprofesa Engelbrecht ke profesa le hlogo ya Kgoro ya Saense ya Dikhomphutha ka Lefapheng la Boentšenere, Tikologo ya Kago le Theknolotši ya Tshedimošo. Ke mohlankedi wa bjale wa Protšeke ya Ditulo tša Dinyakišišo tša Afrika Borwa ka ga Bohlodi bja Maitirelo. Dinyakišišo tša gagwe di nepišitše kudu mathateng a sekhomphutha gomme makala a gagwe a itšeng ao a nago le kgahlego go wona ke sehlopha sa mathata a sekhomphutha, mathata a phetogo, dineteweke tša nyurale tša maitirelo, mekgwa ye e sontilego ya maitirelo, le go ithuta go tšwa go tsebo ya lefela ka go šomiša phetogommogo ye e kgonago. Dimmotlolo tša alekoriteme tša diponagalo tše di tšwago tlhagong di a šomišwa go rarolla mathata a koketšo ya bothata, go akaretšwa mathata fao ponagalo ya go nyaka e fetogago ka maatla ge nako e ntše e sepela, fao maikemišetšo a a thulanago ka bontši a swanelago go oketšwa sammaletee, le fao ditharollo tše ntši di swanelago go hwetšwa le go lotwa mohlala ka ditikologong tše di fetogago ka maatla.
Mošomo wa gagwe go koketšo ya karolo ya bothata (PSO), woo o theilwego godimo ga dimmotlolo tša mekgwa ya kgobokano ya dinonyana, o amogetšwe ka tlhompho ye kgolo. Mošomo wa ketapele o dirilwe le tšweletšo ya dialekoriteme tša PSO go rarolla mathata a koketšo ya mehola ye mebedi ka sekgobeng se se tšwelago pele sa go ba le kelo ye nnyane ye e sa fetogego. Dialekoriteme tša mathomo tša PSO ye e šomago botse di tšweleditšwe go rarolla mathata a koketšo fao ditharollo di hlagišwago ka go šomiša dihlopha tša mmetse sebakeng sa divekthara. Dialekoriteme tše diswa tša PSO le tšona di tšweleditšwe go rarolla mathata a koketšo ya maikemišetšontši ao a fetogago, datha ye e sa fetogego ya sehlopha, go akanya sebopego sa sekontari sa RNA le go dira dipeakanyo tša tatelanontši. Profesa Engelbrecht o hlomphega kudu ka lebaka la mošomo wa gagwe wa dialekoriteme tša PSO tša phetogommogo ye e bapetšegago le ye e thušago. Nyakišišo ya gagwe gape e tšweleditše tše dingwe tša ditshekatsheko tša mathomo tša teori tša PSO le dibopego tša kopantšho ya yona. Nyakišišo ya bjale e tšweleditše dialekoriteme tše diswa tša PSO go hlahla dineteweke tša nyurale ka gobeng gona ga kgopolo ya diophareitha tša phetogo tša kopantšho le kgaogantšho go tšwa go dialekoriteme tša phetogo le PSO.
Malobanyana Moprofesa Engelbrecht o šomile ka lekaleng la dirobotike tša sehlopha, a tšweletša mekgwa ya go laola sehlopha sa diroboto tša karabo ya setimulase ye bonolo go dira mošomo wo boima kudu. Mekgwa ye e theilwe godimo ga mekgwa ya go tsoma dijo a dinoši tša mamapo le ditšhošane tša leganata. Mošomo wa gagwe wa bjale ka ga tshekatsheko ya ponagalo ya go tia le phethagatšo ya yona taetšong ya go thatafa ga mathata a koketšo le go akanya maemo a katlego ya dialekoriteme tša koketšo o amogelwa ka lebelo. Moprofesa Engelbrecht o abetšwe maemo a A2 go tšwa NRF.
Professor Andries Engelbrecht

Professor Van de Peer is a part-time professor in the Department of Genetics in the Faculty of Natural and Agricultural Sciences. He is also a professor at Ghent University in Belgium and an adjunct professor at Western University in Ontario, Canada.
Professor Van de Peer is widely regarded as a world leader in bioinformatics, with unique expertise in algal and plant genomics. His research group is regarded as a centre of excellence for gene prediction and genome annotation, comparative and evolutionary genomics, and evolutionary systems biology. The group has been involved in the study and annotation of the genomes of several algae, including Micromonas, Ostreococcus, Ectocarpus and Emiliana, and of land plants such as the poplar, apple, grape, eucalyptus, tomato, and the orchid Phalaenopsis. His group was also the first to publish the genome sequence and analysis of a chelicerate, in particular the two-spotted spider mite Tetranychus urticae. Currently Professor Van de Peer’s research focuses on two major themes, namely plant and algal genomes and evolutionary analyses, with the emphasis on gene and genome duplication. A substantial amount of work is devoted to the development of novel gene-prediction and modelling tools, on improving machine learning algorithms and comparative approaches using sequence information from other genomes. His team also has extensive expertise in the development of (online) resources in the fields of both genome annotation and comparative evolutionary genomics.
Professor Van de Peer was the first to suggest a correlation between whole genome duplication events in different plant lineages and the Cretaceous–Paleogene boundary, caused by the Cretaceous–Paleogene extinction event that wiped out about 70% of all organisms, including dinosaurs. Although whole genome duplications are usually an evolutionary dead end, research in Professor Van de Peer’s laboratory suggested that, during periods of environmental upheaval, entire genome duplications can provide organisms with a selective advantage so that polyploids can outcompete their diploid progenitors. Professor Van de Peer co-authored more than 330 publications in peer-reviewed journals. He is currently the second most cited plant scientist in Europe and an associate editor for eight peer-reviewed journals. He is a member of the Belgian Royal Flemish Academy for Science and the Arts and recently received a prestigious Advanced Grant from the European Research Council (ERC), which he hopes to use to study the significance of whole genome duplications for the evolution of natural and artificial organism populations. Professor Van de Peer received an A1 rating from the NRF.
Professor van de Peer is ‘n deeltydse professor in die Departement Genetika in die Fakulteit Natuur- en Landbouwetenskappe. Hy is ook ‘n professor aan Gent-universiteit in België en ‘n medeprofessor aan Western-universiteit in Ontario, Kanada.
Professor van de Peer word wyd beskou as ‘n wêreldleier in bio-informatika, met unieke kundigheid in alg- en plantgenomika. Sy navorsingsgroep word beskou as ‘n sentrum van uitnemendheid vir geenvoorspelling en genoomannotasie, vergelykende en evolusionêre genomika en evolusionêre stelselsbiologie. Die groep is betrokke by die bestudering en annotasie van die genome van verskeie alge, waaronder Micromonas, Ostreococcus, Ectocarpus en Emiliana, en ook van plante soos die populier, appel, druif, bloekom, tamatie en die orgidee Phalaenopsis. Sy groep was ook die eerste wat die genoomopeenvolging en ontleding van ‘n cheliseraat, in die besonder die tweekolspinmyt Tetranychus urticae, gepubliseer het. Tans fokus professor van de Peer se navorsing op twee hooftemas, naamlik plant- en alggenome en evolusionêre ontledings, met die klem op geen- en genoomduplisering. ’n Aansienlike hoeveelheid werk word gedoen ter ontwikkeling van nuwe geenvoorspellings- en modelleringsinstrumente, en ter verbetering van masjienleeralgoritmes en vergelykende benaderings deur die gebruik van opeenvolgingsinligting van ander genome. Sy span het ook uitgebreide kundigheid in die ontwikkeling van (aanlyn) hulpbronne vir genoomannotasie as vergelykende evolusionêre genomika.
Professor van de Peer was die eerste wat ‘n korrelasie voorgestel het tussen heelgenoomdupliseringsinsidente in verskillende plantafstammings en die Kryt–Paleogeen-grens, wat veroorsaak is deur die Kryt–Paleogeen-uitsterwingsinsident wat nagenoeg 70% van alle organismes uitgewis het, met inbegrip van dinosourusse. Ofskoon heelgenoomdupliserings gewoonlik ‘n evolusionêre doodloopstraat is, dui navorsing in professor van de Peer se laboratorium daarop dat heelgenoomdupliserings in tye van omgewingsomwenteling organismes met ‘n selektiewe voordeel kan oplewer sodat poliploïede hul diploïede voorgangers deur kompetisie kan verdryf. Professor van de Peer is medeskrywer van meer as 330 publikasies in portuurbeoordeelde joernale. Hy is tans die plantwetenskaplike in Europa met die tweede meeste sitasies en is ‘n mederedakteur vir agt portuurbeoordeelde joernale. Hy is lid van die Belgiese Koninklike Vlaamse Akademie vir Wetenskap en die Kunste en het onlangs ‘n gesogte Gevorderde Toekenning van die Europese Navorsingsraad ontvang. Hy wil die toekenning gebruik om die betekenis van heelgenoomduplikasies vir die evolusie van natuurlike en kunsmatige organismebevolkings na te vors. Professor van de Peer het ‘n A1-graderiung van die NNS ontvang.
Profesa Van de Peer ke profesa wa nakwana ka Kgorong ya Leabela ka Lefapheng la Disaense tša Tlhago le Temo. Gape ke profesa kua Yunibesithing ya Ghent go la Belgium ebile ke mothuša profesa Yunibesithing ya Western go la Ontario, Canada.
Profesa Van de Peer o tsebega kudu bjalo ka moetapele wa lefase ka lekaleng la payoinfomathikse, le tsebo ya moswananoši ka ditšenomiki tša fankase le dimela. Sehlopha sa gagwe sa dinyakišišo se tšewa bjalo ka senthara ya bokgoni bja kakanyo ya tšini le tlaleletšo ya tšenome, ditšenomiki tša phetogo le papetšo, le payolotši ya mekgwa ya phetogo. Sehlopha se be se akareditšwe ka go thuto le tlaleletšo ya ditšenome tša dimelameetseng tše mmalwa, go akaretšwa Micromonas, Ostreococcus, Ectocarpus le Emiliana, le tša dimela tša naga go swana le mopopoliri, moapole, moterebe, mopulokomo, motamati, le mootšhiti Phalaenopsis. Sehlopha sa gagwe gape ebile sa mathomo go gatiša tatelano ya tšenome le tshekatsheko ya khunkhwane ya sekalegokolodi, kudu sekgwa sa tshwedi sa go ba le dikodi tše pedi Tetranychus urticae. Ka se sebaka nyakišišo ya Profesa Van de Peer e nepišitše go merero ya mebediye megolo, ebang ditšenome tša dimela le dimelameetseng le ditshekatsheko tša phetogo, ka kgatelelo godimo ga tšenome le tšini tše di menaganego gabedi. Palo ye kgolo ya mošomo e gafetšwe tlhabollong ya dithulusi tša go mmotlola le kakanyo ya tšini ya moswanananoši, le go kaonafatšo ya dialekoriteme tša go ithuta le mekgwa ya papetšo ka go šomiša tshedimošo ya tatelano go ditšenome tše dingwe. Sehlopha sa gagwe gape se na le bokgoni bjo bo tseneletšego ka hlabollong ya methopo ya inthanete (online) ka lekaleng la bobedi la tlaleletšo ya tšenome le ditšenomiki tša phetogo ye e bapatšegago.
Profesa Van de Peer ke wa mathomo wa go šišinya tswalano gare ga ditiragalo tša go menagana ga bedi ga tšenome ka botlalo ka melokong ye ya go fapana ya dimela le magomo a Khwelelo ka bontši (Cretaceous–Paleogene), ya go hlolwa ke tiragalo ya Khwelelo ka bontši yeo e bolailego 70% ya diphedinyana ka moka, go akaretšwa ditaenosoro. Le ge go menagana gabedi ga tšenome ka botlalo gantši e le mafelelo a phetogo, nyakišišo ka laporatoring ya Profesa Van de Peer e šišinya gore, nakong ya mabaka a khuduego ya tikologo, go menagana gabedi ga tšenome ka botlalo go ka abela diphedinyana mohola wo o kgethago gore dipholipoloite di kgone go fenya batswadi ba tšona ba taepoloite. Profesa Van de Peer o ngwadile mmogo dikgatišo tša go feta tše 330 ka gare ga dijenale tše di sekasekilwego ke badirišane. Ka se sebaka ke rasaense wa dimela wa bobedi wa go tsopolwa kudu go la Yuropa ebile ke mothušamorulaganyi wa dijenale tše seswai tše di sekasekilwego ke badirišane. Ke moleloko wa Akademi ya Belgium ya Bogoši bja Flemish ya Saense le tša Bokgabo gape kgauswinyane o amogetše Thušo ya Maemo a Godimo ye e Kaone go tšwa go Lekgotla ya Yuropa la Dinyakišišo, yeo a holofelago go e šomiša go nyakišiša bohlokwa bja go menagana gabedi ga tšenome ka botlalo ya phetogo ya diphedinyana tša tlhago le tša maitirelo. Profesa Van de Peer o abetšwe maemo a A1 go tšwa NRF.
Professor Yves van de Peer

Other 2015 NRF-rated Researchers
Ander 2015 NNS-gegradeerde Navorsers
Ditekanetšo tše dingwe tša 2015 tša Motheo wa
Dinyakišišo wa Setšhaba




Professor Abbas is as an associate professor in the Department of Mathematics and Applied Mathematics in the Faculty of Natural and Agricultural Sciences. He was awarded a PhD with distinction by the University of Valencia in Spain and subsequently completed postdoctoral fellowships at Indiana University Bloomington, USA and the University of Birmingham in the UK, where he is an honorary senior research fellow. His area of research is fixed-point theory, fuzzy logic and optimisation theory, on which he has published several papers in leading journals.
Professor Abbas is the author of two books and has been cited 2 995 times since 2010. He is an editor of The Scientific World Journal and the Journal of Advanced Topology and has been a guest editor for Journal of Function Spaces. He received the Research Productivity Award 2014 (Category A) from the Pakistan Council of Science and Technology and a gold medal from the Pakistan Academy of Sciences. Professor Abbas works as a research consultant on different research projects undertaken by King Fahd University of Petroleum and Minerals in Saudi Arabia. He has attended many international conferences as a keynote or invited speaker. He received a C2 rating from the NRF.
Dr Appadu is a senior lecturer in the Department of Mathematics and Applied Mathematics in the Faculty of Natural and Agricultural Sciences. His research areas are computational fluid dynamics, computational aero-acoustics and numerical optimisation.
His research is focused mainly on the numerical solution of partial differential equations: the construction of efficient methods for hyperbolic conservation laws; advection-diffusion-reaction equations and dispersive equations; the construction of high-order schemes with low dispersion and low dissipation properties in computational aero-acoustics; and applications. Dr Appadu received a Y2 rating from the NRF.
Professor Bansal, who has more than 25 years’ experience in teaching, research and industry, is a professor and Group Head (Power) in the Department of Electrical, Electronic and Computer Engineering in the School of Engineering. Prior to his appointment at UP he was employed by the University of Queensland in Australia, the University of the South Pacific in Fiji, the Birla Institute of Technology and Science in Pilani, India, and the Civil Construction Wing of All-India Radio. He has worked with Powerlink, an Australian government-owned corporation responsible for Queensland’s high-voltage electricity transmission network.
Professor Bansal has published more than 220 journal articles, presented papers at conferences, and has contributed to books and chapters in books. He has supervised 11 PhD students and currently oversees the studies of 13 more PhD students. His diversified research interests in the areas of renewable energy and conventional power systems include wind, photovoltaics (PV), hybrid power systems, distributed generation, grid integration of renewable energy, power systems analysis (reactive power/voltage control, stability, faults and protection), smart grid, flexible alternating current transmission systems (FACTS) and power quality. Professor Bansal is an editor of the highly regarded journals, IETRenewable Power Generation (regional editor for Africa) and Electric Power Components and Systems. He is a fellow and a chartered engineer of the Institution of Engineering and Technology, UK; a fellow of Engineers Australia; a fellow of the Institution of Engineers (India) and a senior member of the Institute of Electrical and Electronics Engineers (IEEE). Professor Bansal received a C1 rating from the NRF.
Professor Mujahid Abbas
Dr Rao Appadu
Professor Ramesh Bansal
Professor Barac is Head of the Department of Auditing in the Faculty of Economic and Management Sciences and one of only three NRF-rated researchers who are qualified chartered accountants.
Her research focuses on education in and the development of skill and competency requirements for auditors (both internal and external), and governance from an internal auditing perspective. In a field where the focus is primarily on professional examinations and is influenced by these, she has produced quality research at regular intervals and received various research and best publication awards.
Professor Barac played an instrumental role in the iKUTU research group, the members of which have been collaborating in research on internal auditing since 2006 and have published three reports and 19 accredited articles. She is the leader of an international research team that was awarded a research grant by the Institute of Chartered Accountants of Scotland and the UK Financial Reporting Council. The findings of their study on skill and competency requirements for auditors in today’s complex global business environment will be presented during a dedicated session at the BAFA Audit and Assurance Conference to be held in Edinburgh, Scotland in April 2015. She received a C3 rating from the NRF.

Professor Best, who retired officially in 2005, is an extraordinary professor in the Mammal Research Institute in the Faculty of Natural and Agricultural Sciences.
His particular area of interest is the natural history of cetaceans, especially the population dynamics of large whales recovering from over-exploitation. This explains his involvement in the annual aerial survey of southern right whales, one of the lengthiest continuous marine monitoring programmes in South Africa, which has just completed its 44th year. This time series provides a very important baseline for studying the effects of environmental fluctuations on a marine mammal population.
Professor Best has been a member of the Scientific Committee of the International Whaling Commission since 1971 and an Invited Participant since 1984. He served as a member of the editorial advisory board of the African Journal of Marine Science from April 2010 until December 2011. At present he is an honorary associate at the Iziko South African Museum in Cape Town. At the international level he has been an honorary member (only the second selected from the southern hemisphere) of the Society for Marine Mammalogy since 2008. He is an invited keynote speaker at the first Humpback Whale World Conference to be held in Madagascar in June 2015. Professor Best received a B2 rating from the NRF.
Professor Bester is an emeritus professor and senior research fellow in the Department of Zoology and Entomology in the Faculty of Natural and Agricultural Sciences. His research focuses mainly on the population biology and ecology of marine mammals in the Southern Ocean, which include the fur seals and elephant seals of the South African Prince Edward Islands, and Weddell and Ross seals in Antarctica.
Professor Bester (Pr Sci Nat), who has been an UP Academic Achiever since 2005, is a member of the Society for Marine Mammalogy (SMM)’s ad hoc Committee on International Relations, the Tristan da Cunha Biodiversity Advisory Group (TBAG) and the Scientific Committee for Antarctic Research (SCAR) Action Group on Antarctic Fuel Spills (AGAFS). He serves on the editorial boards of The Scientific World Journal and Polar Biology and is a review editor for the Marine Ecology Progress Series (MEPS). Since 2010 he has published 51 peer-reviewed articles in scientific journals and has contributed nine chapters to books. He also supervised eight MSc and four PhD graduates. A fellowship offered to him at the Hanse-Wissenschaftskolleg (HWK) Institute for Advanced Study in Delmenhorst, Germany will enable him to continue his research on seals in the Weddell Sea, Antarctica. Prof Bester received a B3 rating from the NRF.


Professor Karin Barac
Professor Peter Best
Professor Marthán Bester

Professor Bidwell is an extraordinary professor in the Department of Informatics in the Faculty of Engineering, Built Environment and Information Technology. As a leader in human–computer interaction (HCI) she designs technologies to suit the values, livelihoods and knowledge systems of people who are marginalised by urban and Western-centred design. Since 2002, Professor Bidwell has focused on interaction with mobile devices, information systems and simulated 3D environments that are better suited to inhabitants of rural and often impoverished and/or isolated places, such as regions of Mozambique, Namibia, South Africa and Australia.
Most of her 100 peer-reviewed publications relate to the communication and knowledge practices of rural and indigenous groups. They apply third paradigm HCI and reflect a located accountability, participatory ethnographic methods and innovation over 20 different ICT prototypes. In recent work she involved Xhosa communities from the Eastern Cape in designing mobile applications suited to their oral practices and economic circumstances, which broke considerable new theoretical ground and had a tangible social impact through deployment that enabled even print-illiterate people to use ICTs. In 2013, Professor Bidwell received the International Federation for Information Processing Technical Committee’s award for the Best Contribution to Interaction Design for International Development.
Her efforts to decolonise HCI include being the Technical Programme Chair of AfriCHI, a pan-African conference to be inaugurated in Kenya, co-founding the Indigenous Knowledge Technology Conference in Namibia and creating the first panel on Indigenous-led Digital Enterprise at an international HCI conference. She holds a position in Namibia and is affiliated with the Digital Ethnography Group at the Royal Melbourne Institute of Technology in Australia. She received a B3 rating from the NRF.

Professor Birkholtz is an associate professor in the Department of Biochemistry in the Faculty of Natural and Agricultural Sciences. She is the Director of the South African Research Chair in Sustainable Malaria Control of the Department of Science and Technology (DST)/NRF.
She is a UP alumna whose PhD (cum laude) studies on biochemical aspects of malaria in 2003 led to collaborative post-doctoral study in Germany. Her research interest is the physiology, biochemistry and pharmacology of malaria parasites. Biochemical distinctions between the malaria parasite and the human host are investigated with a view to designing novel antimalarial chemotherapeuticals and is bringing to the fore new knowledge on less explored aspects of malaria parasite biology.
Professor Birkholtz is the lead investigator of UP’s Centre for Sustainable Malaria Control Parasite Cluster and has supervised the research of more than 40 MSc and PhD students in the Malaria Parasite Molecular Laboratory. She is a member of the European Virtual Institute for Malaria Research (EviMalar, EU FP7) and the Gauteng Transmission Blocking Platform, and collaborates with many researchers in South Africa, Europe and the USA.
She has received numerous international scientific awards, authored many scientific publications, been an invited speaker at national and international conferences and presented her research at international seminars. She is an invited board member of various publications and is a member or board member of numerous societies, committees and centres. She acts as a peer reviewer for numerous international journals and as a scientific advisor in the reviewing of research grants for national and international councils and foundations. She received a B3 rating from the NRF.
Professor Nicola Bidwell
Professor Lyn-Marie Birkholz
Professor Boezaart is professor in and Head of the Department of Private Law in the Faculty of Law. She founded the Centre for Child Law at the University of Pretoria in 1998 and was its director until 2008, which was also the year that she acted as a judge in the North Gauteng High Court. She still serves on the board of the Centre for Child Law and is the deputy chairperson of the Board of the Centre for Education Law and Policy (CELP).
She specialises in Child Law and the Law of Persons and her publications include textbooks such as Law of Persons (fifth edition 2010), various chapters in books, the most recent being on the position of minor and dependent children of divorcing and divorced spouses or civil union partners in The Law of Divorce Dissolution of Life Partnerships (Juta 2014), and articles in peer-reviewed journals. She is the editor of Child Law in South Africa (2009), to which she contributed a chapter, and the co-editor of and contributor to Commentary on the Children’s Act (2007). Professor Boezaart received a B2 rating from the NRF.

Professor Bornman is a senior research professor in the Dean’s Office and the School of Health Systems and Public Health in the Faculty of Health Sciences. Her research focuses on the human and environmental reproductive health effects that result from exposure to endocrine disrupter chemicals (EDC).
She reported the first cases of intersex in sharptooth catfish. Her research further revealed that intratesticular calcifications and malignant changes in eland testes are similar to those found in humans with testicular dysgenesis syndrome, and that diseases of sexual development in newborn boys are associated with in utero 1,1,1-trichloro-2,2-bis (4-chlorophenyl) ethane (DDT) exposure in a malaria area. The high prevalence of disorders of sexual development (DSD) in boys born to stay-at-home mothers living in houses sprayed with DDT added to the international concern about the long-term health effects of DDT. She further studied possible preventative interventions to limit and reduce exposure inside the home. Currently she is the adjunct-principal investigator for a study on neurodevelopmental defects in children living in areas sprayed with DDT, which is being conducted by the National Institute of Environmental Health Sciences (NIEHS). Professor Bornman received a C1 rating from the NRF.

Professor Bothma is a professor in and Head of the Department of Information Science and chairperson of the School of Information Technology. His teaching and research focus on information organisation and retrieval (including information literacy), web development and electronic publishing, and curriculum development. He is the author or co-author of numerous publications and has presented many papers at local and international conferences. In terms of current international research collaboration, he is a member of the Scientific e-Lexicography for Africa (SeLA) research initiative undertaken with the University of Hildesheim, funded by the German Academic Exchange Service (Deutscher Akademischer Austausch Dienst (DAAD)), collaborates with CentLex (the Centre for Lexicography) at Aarhus University in Denmark and with the International Centre for Lexicography at the University of Valladolid in Spain, and is an expert resource person for the Freedom of Access to Information and Freedom of Expression (FAIFE) Committee of the International Federation of Library Associations and Institutions (IFLA).
In 2010, 2012 and 2014 Professor Bothma received substantial grants from the Carnegie Corporation of New York for the development and presentation of a master’s programme in information technology (IT) and the development and presentation of a continuing professional development programme in IT for academic librarians. In 2009 and 2012 he was recognised by the University of Pretoria as an exceptional academic achiever. He received a C1 rating from the NRF.

Professor Riana Bornman
Professor Theo Bothma
Professor Trynie Boezaart


Professor Carstens is a part-time associate professor in the Department of Companion Animal Clinical Studies in the Faculty of Veterinary Science, where she has been employed full time for 26 years. Although she started out as a specialist surgeon, she has been working in the Diagnostic Imaging Unit for the past 16 years. She specialises in the use of imaging in the evaluation of causes of poor performance in horses, in particular causes that involve the musculoskeletal and respiratory systems. Her recent research involved the use of magnetic resonance imaging (MRI) to detect early arthrosis, specifically by using delayed Gadoliniumenhanced MRI of the joint cartilage. In this work, reported in published articles, she established the foundation of the technique for further studies on arthritic joints. Her research in respiratory systems centred on the radiology of the thorax and trachea, detailing the effect of the respiratory phase on radiographic biometrics. During the past five years she has presented the findings of these studies at several international congresses.
In 1992, Professor Carstens and the ‘colic team’ were the joint recipients of the South African Veterinary Association’s clinical prize; in 1999 she was the individual winner of the same prize. She is a diplomate of the European College of Veterinary Diagnostic Imaging and is serving on the college’s examination committee for the period 2011–2016. She received a C2 rating from the NRF.
Professor Casey, who retired in 2012, is an animal scientist whose research is focused on livestock production physiology. During his successful career at UP he was a professor and Head of Department and served the University in many exciting, challenging ways. While researching livestock production physiology, he supervised 52 successful master’s and 18 doctoral students. His research led to publications in science journals, books and specialist reports for science agencies, including the Water Research Commission. His work is widely cited and applied. His research output during the current period under review was particularly interesting and contained a combination of hypothesis-driven experiments, mainly on the responses of livestock to inorganic constituents in groundwater and physiological factors that advance or limit livestock production. He also presented an interesting, thought-provoking paper on ‘Integrated higher learning as an investment in intellectual capital for livestock production’. As professor emeritus, he continues to conduct research on livestock physiology and water quality and envisages the publication of revised water quality standards for livestock and wildlife to replace the 1996 standards of which he was a co-author. Professor Casey received an C3 rating from the NRF.

Professor Chimimba is a professor and Head of the Department of Zoology and Entomology at the University of Pretoria, a research associate of the Mammal Research Institute (MRI), and a core team member of the DST/NRF Centre of Excellence for Invasion Biology (CIB). He is a specialist in biosystematics and applies morphometrics, DNA sequencing, cytogenetic, ecological, epidemiological, and GIS techniques on taxa of medical, veterinary, agricultural, economic and nature conservation importance.
He serves on the advisory board of the Research Committee of the South African National Biodiversity Institute (SANBI), and is a Trustee of the Green Trust and Vice-Chair of the adjudication panel of the National Science and Technology Forum (NSTF). Prof Chimimba has acted as supervisor or co-supervisor for ten PhD and 14 MSc graduates, and has mentored three post-doctoral Fellows. He has authored or co-authored 66 papers published in international peer-reviewed scientific journals and 15 chapters in books, co-revised the third edition of the Mammals of the southern African subregion, published by Cambridge University Press, and served as an associate editor for the Journal of Mammalogy (USA) and Biodiversity and Conservation (The Netherlands). His research has been presented at national and international scientific conferences. He was a recipient of an NSTF award for his contribution to science, engineering and technology. Professor Chimimba received a C1 rating from the NRF.
Professor Norman Casey
Professor Chris Chimimba
Professor Ann Carstens
Dr Coetzee is a lecturer in the Department of Genetics in the Faculty of Natural and Agricultural Sciences and specialises in facial perception, specifically the facial features associated with health and disease.
She has been invited to present her research findings at various national and international conferences and science festivals, including the Tagung Experimentell Arbeitender Psychologen (TEAP) conference in Giessen, Germany and Scifest Africa in Grahamstown. Numerous news and science programmes, such as SAfm’s Science Matters and Radio 702’s Believe it or not, have reported on her research and it featured prominently on international news websites such as Times Live and CNN International.
Dr Coetzee has received several grants, including Technology Innovation Agency seed funding, postdoctoral fellowships, for example the University of Pretoria’s five-year research fellowship, and travel grants, as well as awards from the International Human Behaviour and Evolution Society, the Experimental Psychology Society Grindley Grant and the Association for the Study of Animal Behaviour. She has published 21 papers in international peer-reviewed scientific journals and has been cited more than 400 times. She received an Y1 rating from the NRF.

Dr De Beer is a senior lecturer in the Department of Microbiology and Plant Pathology in the Faculty of Natural and Agricultural Sciences and a research leader in the DST-NRF Centre of Excellence in Tree Health Biotechnology (CTHB) and the Tree Protection Co-operative Programme (TPCP) in the Forestry and Agricultural Biotechnology Institute (FABI).
As a mycologist his research is focused on the taxonomy, phylogeny and evolution of ophiostomatoid fungi and their symbiotic interactions with insects, mites and bacteria. Some of these fungi, together with their insect vectors, play important roles in forestry ecosystems and can cause severe losses in disturbed environments. Dr De Beer serves on several international bodies that govern the taxonomy and nomenclature of fungi. He received a B2 rating from the NRF.

Dr De Bruyn is a senior lecturer in the Department of Zoology and Entomology in the Faculty of Natural and Agricultural Sciences. He is a research associate and executive member of the Mammal Research Institute (MRI), where he is the principal investigator and field operations manager of the Marion Island Marine Mammal Programme (MIMMP).
His research focus is the population ecology of large mammals, both aquatic and terrestrial, with specific interest in the fundamental drivers of the population regulation of top marine predators. A central interest is the improvement of field methodology to facilitate the assessment of certain life-history characteristics. He has a keen interest in photogrammetry as used in measuring animal morphometrics and body size. His research output includes peer-reviewed opinion correspondence on a range of ecological topics.
He is an associate editor of African Zoology and a regular reviewer for top international journals, and has published more than 55 articles in international journals such as Nature. He has participated in several expeditions on sub-Antarctic islands and is a member of the Scientific Committee of Antarctic Research (SCAR)’s expert group on birds and marine mammals (EGBAMM). He is an active member of several professional societies, including the Society for Marine Mammalogy (USA) and the Zoological Society of Southern Africa. He received a Y1 rating from the NRF.

Dr Wilhelm de Beer
Dr Vinet Coetzee
Dr Nico de Bruyn



Professor De Kock is an associate professor in the Department of Food Science in the Faculty of Natural and Agricultural Sciences. Her research focuses on the sensory properties of food and drink that contribute to the nutrition and wellbeing of consumers in sub-Saharan Africa. Her research priorities include food product development to meet the demands of a growing and more urbanised African population in transition, the exploration of the richness of sensory experiences in foods from Africa’s bio-diverse food sources and the tailoring of sensory properties of foods to make them not only nutritionally adequate, but also appealing and appetising.
Professor De Kock has supervised or co-supervised the research of two postdoctoral fellows, eight PhD and 16 master’s students, and has contributed to 32 papers published in international journals.
She is the incumbent of the Research Chair of the European Sensory Network. She was a keynote speaker at the International Union for Food Science and Technology (IUFOST) 2014 World Congress held in Canada and an invited speaker at the 2012 Institute of Food Technologists (IFT) Symposium, where she spoke on the topic ‘An African sensory adventure: how sensory science can contribute to food security, diversity, health and nutrition in Africa’. She received a C2 rating from the NRF.
Professor De Villiers is a professor of Accounting in the Faculty of Economic and Management Sciences, where he teaches Sustainability Accounting and provides research mentorship. He is also a professor of Accounting at the Auckland University of Technology (AUT) in New Zealand, adjunct professor at the Cape Peninsula University of Technology (CPUT), extraordinary professor at the University of the Western Cape (UWC), and a research fellow at the Centre for Sustainability Management at Leuphana University in Lüneburg, Germany. Professor De Villiers’ main research focus is on sustainability reporting and integrated reporting, as well as other aspects of corporate social and environmental disclosure choice. His more than 200 research-based publications and presentations include more than 50 articles published in refereed journals such as Accounting, Organizations and Society; Journal of Management; Accounting, Auditing & Accountability Journal; Journal of Accounting and Public Policy; and British Accounting Review.
In 2011 he received best paper awards from the Accounting and Finance Association of Australia and New Zealand (AFAANZ) and the Southern African Accounting Association (SAAA). He is the editor of Meditari Accountancy Research and serves on several editorial boards, including those of the Accounting, Auditing & Accountability Journal; Accounting and Business Research and Issues in Accounting Education. He was also a co-editor of special issues of the Accounting, Auditing & Accountability Journal (on integrated reporting) and the Pacific Accounting Review (on sustainability accounting), both of which were published in 2014. Professor De Villiers received a C1 rating from the NRF.
Professor De Villiers is an emeritus professor in the Department of Dogmatics and Christian Ethics in the Faculty of Theology and acting Head of the Department of Philosophy. He taught Christian Ethics and Professional Ethics for Engineers and was the founder and, until his retirement in 2010, the Director of the Centre for Public Theology. The two major themes of his research as a Christian ethicist have been the engagement of Christian ethics with the challenges of modernity and the contribution of Christian ethics and the church to broader society. During the past two decades he increasingly turned his attention to the former because he was convinced that a new ethical approach was needed in late-modernity to meet these challenges. Much of his recent research has been devoted to the development of the responsibility ethics approach.
Professor De Villiers received an Alexander von Humboldt stipend in 1984. His last research visit to Germany was in 2011. In 2011 he was invited to act as guest editor of a special issue of the International Journal of Public Theology and the University of Pretoria hosted a seminar on aspects of his research in recognition of his contribution to the field of Christian ethics. In 2012 a special edition of the accredited theological journal Verbum et Ecclesia (vol 33, no 2) was dedicated to him as a Festschrift. He received a C2 rating from the NRF.
Professor Riëtte de Kock
Professor Charl de Villiers
Professor Etienne de Villiers
Dr Diale is a senior lecturer in the Department of Physics in the Faculty of Natural and Agricultural Sciences. Her research interests cover the synthesis of materials for the conversion of solar energy. She founded the Solar Energy Research Group that specialises in hybrid organic–inorganic solar cells using c-Si, CZTS and Perovskites. Haematite is also explored for the fabrication of photo-electrochemical cells with various dopends used to improve the photo-current. Since artificial photosynthesis and photovoltaic phenomena are similar processes, Dr Diale has extended her knowledge of electrical characterisation of materials to proteins as current conductors and the exploration of the influence of algae and proteins on semiconductors current transport mechanisms. She is supervising and co-supervising research students at both MSc and PhD levels. Her research has contributed 51 publications in accredited journals.
She is part of a vast network of collaborators, which includes the Ernest Orlando Lawrence Berkeley National Laboratory (USA), National Renewable Energy Laboratory (USA), Laboratories for Ceramic Materials - EMPA (Switzerland), the University of Hong Kong, the University of Zambia, the University of Botswana, the University of Venda, the Council for Scientific and Industrial Research (CSIR) and the NRF’s iThemba Laboratory for Accelerator-based Sciences. These collaborations allow Dr Diale’s students to have international experience during their PhD studies. Dr Diale plays an active role as a catalyst for transformation and is involved in discussions on ways in which the number of black scientists and engineers can be increased with an aim of narrowing the skills gap. She received a C3 rating from the NRF.

Professor Dirker is a senior lecturer in the Department of Mechanical and Aeronautical Engineering in the Faculty of Engineering, Built Environment and Information Technology. He leads a research team of postgraduate students whose work includes experimental and numerical investigations of heat transfer and thermo-fluid optimisation.
His experimental work is focused on the production of fundamental convective heat transfer and fluid-flow data from which behavioural correlations are developed for geometrics and components commonly found in industry. In his numerical work, he focuses on the development of simulation models that can be used to supplement experimentally obtained data. In his optimisation work, thermodynamic and topology optimisation techniques are considered with a view to improving thermal and operational efficiencies at component and energy systems levels. He received a C3 rating from the NRF.

Professor Du Toit is an associate professor in the Department of Humanities Education in the Faculty of Education and the Programme Coordinator for the Postgraduate Certificate in Higher Education (PGCHE).
His field of specialisation is learning and teaching in higher education, with a specific focus on the educational and professional development of academic staff. Professor Du Toit participated in exchange programmes with Iowa State University and the University of Oklahoma, which were partly sponsored by the United States Agency for International Development (USAID). He was also involved in an exchange programme with the Catholic University of Leuven and holds a postdoctoral fellowship at the University of Antwerp, Belgium. Both the exchange programme and the fellowship were sponsored by the Flemish government. He collaborates with the Eduardo Mondlane University in Mozambique on professional development programmes.
He received an Education Innovation Award from the University of Pretoria in 2014 and was nominated for the Education Research in Africa Award (ERAA) for mentoring in 2013. His collaboration with the Ned Herrmann Group in the USA led to the publication of a significant co-authored work titled Whole brain® thinking in higher education: practice-based evidence, which reports on 14 years of research. Professor Du Toit received a C3 rating from the NRF.

Dr Mmantsae Diale
Professor Jaco Dirker
Professor Pieter du Toit



Professor Ebersöhn is a professor in the Department of Educational Psychology and the Director of the Centre for the Study of Resilience in the Faculty of Education. She studies resilience and education within postcolonial contexts of high risk, high need and resource constraints with the aim of positioning Global South scholarship within mainstream resilience and education discourses. She is a member of the Academy of Science of South Africa (ASSAF) and the Secretary General of the World Education Research Association. She is the editor of the South African Journal of Education which, under her leadership, has been ranked by Thomas-Reuters as number 120 out of 219 journals on education and educational research. She was a runner-up in the Distinguished Researcher category of the Department of Science and Technology’s Women in Science awards and is a principal investigator in several current multinational studies on education and resilience. Professor Ebersöhn received a C1 rating from the NRF.
Professor Eloff is the Dean of the Faculty of Education and her research focuses on positive psychology, resilience, HIV and vulnerable children within the broad fields of education and educational psychology. She has led large-scale research projects in these fields. Her research investigates strength-based approaches within vulnerable populations, where she interrogates how humans find ways to respond positively to circumstances of severe adversity.
In July 2014 she received the international Prize for Excellence in HIV Research Related to Children from the International Aids Society (IAS) and the Coalition for Children Affected by Aids in Melbourne. She was chosen as one of the top three Most Influential Women in Business and Government in South Africa in the Education category in 2012, and in January 2015 she received the Education Association of South Africa’s Medal of Honour. Professor Eloff received a C1 rating from the NRF.
Professor Eloff is the founder of the interdisciplinary Phytomedicine Programme in the Faculty of Veterinary Science, which concentrates on using plants selected either by focused screening or the ethnoveterinary use of plants to treat infections and infestations by microorganisms and parasites in production animals. He has successfully supervised or co-supervised 47 MSc and 38 PhD students. He is the editor of the South African Journal of Botany, the SuidAfrikaanse Tydskrif vir Natuurwetenskap en Tegnologie and the International Journal for Phytomedicine, BMC Complementary and Alternative Medicine, and has reviewed manuscripts for 211 different scientific journals. He has delivered more than 190 international presentations (including 54 invited/plenary presentations) and has written 235 peer-evaluated scientific publications. With 6 300 citations he is the sixth most cited African scientist in all fields (Thomson Reuters, ISI). Professor Eloff managed the project that gave rise to the African Herbal Pharmacopoeia. His research led to the registration of several patents and products licensed to industrial companies. He fulfils a leadership role in several national and international professional societies and has been awarded the South African Association of Botanists gold medal, the Havenga and gold medals from the SA Akademie vir Wetenskap en Kuns, the National Science and Technology Forum Eskom Prize for capacity development and the Academy for Science of South Africa (ASSAf) gold medal. He received a continued B3 rating from the NRF.
Professor Liesel Ebersöhn
Professor Irma Eloff
Professor Kobus Eloff
Professor Etter is an extraordinary professor in the Epidemiology Section of the Department of Production Animal Studies in the Faculty of Veterinary Science and enjoys international recognition as an expert in risk analysis. His research is focused on different animal diseases, including vector-borne diseases such as blue-tongue, West Nile virus, African horse sickness and African swine fever, and zoonotic diseases such as bovine tuberculosis, brucellosis and Rift Valley Fever. He also does research on diseases with major economic consequences such as swine fever and foot-and-mouth disease which, owing to the risk of importation bans, have an impact not only on farmers, but also on entire countries. He assesses classical and innovative methods to determine risk factors in order to propose the best and most cost-effective strategies for controlling these diseases. He has developed skills in multivariable models (including factorial analysis, logistic regression and social network analysis) and tested the strategies using stochastic risk assessment. His research involves the application of social science approaches to understanding the surveillance and control of notifiable diseases. This transdisciplinary approach should promote an understanding of the real flow of information and factors that influence the acceptability of surveillance systems in order to optimise the disease control.
He has published more than 30 articles in international peer-reviewed journals. Two PhD and 12 MSc candidates have graduated under his supervision or co-supervision and he is currently supervising or co-supervising one PhD and five MSc students. Professor Etter received a C3 rating from the NRF.

Dr Fasina completed his PhD degree at the University of Pretoria in 2013 and is currently studying towards a PhD in Epidemiology at Utrecht University in the Netherlands. As a senior lecturer in the Department of Production Animal Studies in the Faculty of Veterinary Science he teaches Porcine Health and Production and supervises professional and research-based postgraduate students. His primary areas of research are the viral epidemiology of transboundary animal and zoonotic diseases, animal disease economics and ecology, and disease modelling. He continues to conduct research on the highly pathogenic avian influenza virus H5N1, African swine fever and other important zoonotic diseases. He has led or actively participated in a number of national and international research and surveillance programmes and has a network of research collaborators in Africa, the USA, Europe and South America. He serves on the expert panel of the European Food Safety Authority (EFSA) and recently was a leading contributor to a well-received publication on the transmission dynamics of Ebola in Nigeria. He has published significant numbers of peer-reviewed articles in top-rated academic journals and has to date received more than 21 grants and achievement awards. He was awarded the University of Pretoria’s Exceptional Young Researcher Award in 2013. He has so far had 336 citations and his Scopus h index is 9. Dr Fasina received a C3 rating from the NRF.

Professor Fourie is a professor in the Department of Information Science in the Faculty of Engineering, Built Environment and Information Technology. Her main research focus areas are information behaviour and information literacy, with specific reference to health care, current awareness services and library and information services.
She has conducted research on the information behaviour of cancer patients and their families in palliative care, oncology nurses and social workers; compassion fatigue; affect and emotion; cervical cancer; HIV/Aids; and a collaborative auto-ethnographic approach to information-related experiences of caregivers in the context of palliative care. Her research also includes current awareness services (staying abreast of developments) that are offered to various target groups in different contexts and include nursing and social work in cases of cancer, palliative care and compassion fatigue. Her research collaborators include academics and practitioners from the USA, the Netherlands, Australia and, more recently, New Zealand. Professor Fourie received a C1 rating from the NRF.

Dr Dayo Fasina
Professor Ina Fourie
Professor Eric Etter



Professor Guthrie is a professor and Director of the Equine Research Centre at the Faculty of Veterinary Science.
His major research area is equine infectious diseases with a particular emphasis on diseases affecting international trade in South African horses. The majority of his research is on the epidemiology, diagnosis and control of African horse sickness. Other research areas include equine sports medicine and equine management and welfare.
In 2012 he was invited to serve on the World Organization of Animal Health’s Working Group on the official recognition of member countries African horse sickness status and in 2013 he was nominated as member of the World Organization of Animal Health’s Ad Hoc Working Group on International Movement of elite performance horses. He is also a member of the International Committee of the Conference on Equine Infectious Diseases. He received the B2 rating from the NRF.
Dr Hassen is a senior lecturer in Ruminant Nutrition and Pasture Science in the Department of Animal and Wildlife Sciences in the Faculty of Natural and Agricultural Sciences. His research is focused mainly on sustainable forage and feed resource utilisation for livestock production in a changing environment (with more emphasis on the impact of climate change). In particular, it is directed at the use of drought-tolerant legumes, fodder trees and shrub species, and dietary manipulation to improve poor quality forage utilisation by ruminants while reducing the net greenhouse gas emissions from livestock systems under semi-intensive and extensive management conditions.
Dr Hassen has received numerous research grants from various bodies including the NRF, the Gauteng Department of Agriculture and Rural Development, the Department of Science and Technology, the International Foundation for Science, the International Atomic Energy Agency and the European Union (under FP7 programmes). One PhD and five MSc candidates have graduated under his supervision or co-supervision and he currently is the chief supervisor for six PhD and seven MSc students affiliated with the abovementioned research projects. He received a C3 rating from the NRF.
Dr Haussmann is a senior lecturer in the Department of Geography, Geoinformatics and Meteorology in the Faculty of Natural and Agricultural Sciences.
Over the years her research interests have been wide ranging and often interdisciplinary, but nevertheless retained a geographical perspective. She has always shown a keen interest in the interactions between biota and their abiotic surroundings. Broadly speaking, her research falls in the category physical geography and, more specifically, biogeomorphology. To date most of her research and publications have focused on plant-landform interactions, predominantly on sub-Antarctic Marion Island. However, she recently expanded her biogeomorphological interests to include animal-landscape interactions and has published articles on the implications that the increasing number of fur seals in the sub-Antarctic hold for plant species compositions, and specifically for the spread of alien invasive plant species.
Dr Haussmann received three years’ research funding from the University of Pretoria via the Research Development Programme. Recently she also received a Thuthuka grant from the National Research Foundation to start a collaborative project on the geomorphological and ecological consequences of burrowing and trampling animals. It is envisaged that this project will integrate the knowledge and expertise of both ecologists and geomorphologists, as well the involvement of students from diverse fields, including ecology, geomorphology, botany and zoology. She received a Y2 rating from the NRF.
Dr Abubeker Hassen
Dr Natalie Haussmann
Professor Alan Guthrie
Dr Holmner holds a DPhil degree in Information Science and is a senior lecturer in the Department of Information Science in the School of Information Technology. Her research interests are information ethics, indigenous knowledge, information and communications technology (ICT) for development, the information and knowledge society, institutional repositories, digitisation, mobile technologies and curriculum development.
Her work has been published in various academic journals, including the South African Journal of Libraries and Information Science, Information Development and Mousaion. She has presented papers and led panel discussions at conferences such as the Progress in Library and Information Science in Southern Africa (ProLISSA) Conference, the Standing Conference of the Eastern, Central and Southern African Library Associations (SCECSAL), the Pre-Conference on Information Systems (ECIS), and workshops of the Association for Information Systems Special Interest Group on ICT and Global Development (AMCIS SIG GlobDev). She has also acted as programme chair and co-chair at SIG GlobDev workshops and mini-tracks.
Dr Holmner teaches courses related, but not limited to, these fields at undergraduate and postgraduate level and acts as study leader and supervisor for several master’s students. She coordinates the master’s programme in Information Technology for faculty and academic librarians from sub-Saharan Africa, sponsored by the Carnegie Foundation, where she specialises in network and mobile technologies, and is the academic coordinator of the continuing professional development programme, Enhancing librarians’ ICT skills for the purpose of enabling research in African Universities, which is also sponsored by the Carnegie Foundation. She received an Y2 rating from the NRF.
Dr Hurley is a research leader in the Forestry and Agricultural Biotechnology Institute (FABI) and a senior lecturer in the Department of Zoology and Entomology in the Faculty of Natural and Agricultural Sciences. His research is focused on the management of insect pests in plantation forests, specifically by means of biological control. His work also encompasses other areas relevant to tree health, such as the genetic diversity of pest populations, microbe-insect associations, pathway management of invasive species and risk analysis. He is a core team member of the Tree Protection Cooperative Programme (TPCP) and the Centre of Excellence in Tree Health Biotechnology (CTHB). He serves on national and international committees on tree health and biological control and is the Deputy Coordinator of the International Union of Forest Research Organizations (IUFRO) Working Group on Biological Control. Dr Hurley received a Y1 rating from the NRF.


Professor Ker was an associate professor in the Department of Physiology from 2002 until the end of 2014. He completed his MBChB and an MMED in Internal Medicine (both cum laude) at the University of Pretoria. His qualifications include Member of the Royal College of Physicians of Edinburgh (MRCP, Edinburgh), an MSc in Internal Medicine (University of Edinburgh) and a PhD in Cardiac Physiology (UP). He is a Fellow of the Royal College of Physicians of Edinburgh (FRCP, Edinburgh).
His research focus is cardiomyopathy, ie diseases that affect the myocardium or heart muscle. He has published 50 peer-reviewed articles and two chapters in textbooks on this topic. Professor Ker received a C2 rating from the NRF.

Dr Brett Hurley
Professor James Ker
Dr Marlene Holmner



Professor Landman is an associate professor in the Department of Chemistry in the Faculty of Natural and Agricultural Sciences. Her research focuses on synthetic organometallic chemistry and, more specifically, on the study of Fischer carbene and N-heterocyclic carbene complexes of transition metals. Her experimental work, including work on the catalytic, electrochemical and structural properties of the novel carbene complexes, is complemented by chemical modelling studies to explain and verify experimental results. She received a C3 rating from the NRF.
Dr Le Roux is a senior lecturer in the Department of Plant Science in the Faculty of Natural and Agricultural Sciences. As an ecologist his research is aimed at developing an understanding of how biotic interactions and abiotic environmental conditions affect the performance and distribution of individual species, and how these effects scale up to determine community-level properties. Dr Le Roux’s research focuses in particular on the interactions between plant species in stressful environments, and on how such interactions will be affected by (and even potentially mediate the impacts of) climate change. Some of his recent papers were published in the Journal of Ecology, Global Change Biology and New Phytologist. Dr Le Roux received a Y1 rating from the NRF.
Professor Lotz is an emeritus professor in Inorganic Chemistry in the Department of Chemistry in the Faculty of Natural and Agricultural Sciences. He retired at the end of 2013. He specialises in the chemistry of the metal-carbon double bond and holds a three-year research contract in the Department of Chemistry. He is currently the President of the South African Chemical Institute. He received a B2 rating from the NRF.
Dr Peter le Roux
Professor Simon Lotz
Professor Marilé Landman
Professor Maharaj is a professor in the Department of Chemistry in the Faculty of Natural and Agricultural Sciences. He is trained in the discovery of new drug leads, nutraceuticals, cosmeceuticals and herbal medicines based on biodiversity samples. He is one of the leading bioprospectors in South Africa and his major research areas include the chemistry of natural products, the biological evaluation of extracts and natural ingredients, and the isolation and elucidation of the structure of natural compounds. He has been involved in collaborative programmes with individuals such as traditional health practitioners, who hold indigenous knowledge.
He participated in the negotiations that led to the benefit-sharing agreement with the San people on the Hoodia plant. He is one of the main inventors of the patent based on the discovery of a novel appetite suppressant that is present in this plant and participated in negotiations with the international pharmaceutical and food industry partners, Pfizer and Unilever, on its commercialisation. Furthermore, he was instrumental in developing the technology for the identification of an artificial sweetener and negotiating a licensing agreement with a multinational company. Recently he developed and commercialised a novel mosquito repellent in South Africa and established a community-owned business for the cultivation, processing and manufacturing of the product from the indigenous plant. He received a C3 rating from the NRF.

Dr Mahmood is a senior lecturer in the Department of Mechanical and Aeronautical Engineering in the Faculty of Engineering, Built Environment and Information Technology and his research interests are in thermo-fluid sciences. He started his research career upon completion of his PhD in 2001 and is involved in experimental and computational research related to gas turbine passage aerodynamics and heat transfer, burner and combustor liner aerothermodynamics, unmanned aerial vehicle (UAV) wing aerodynamics, design and performance measurements of energy exchangers for heating, ventilating and air-conditioning (HVAC) systems, and the enhancement of the thermo-hydraulic performance of heat exchangers and cooling channels.
His latest research has been on the solar heat exchangers and micro gas turbines for manufacturing technology and mining automation. He has done extensive research in wind tunnel design, test set-up, instrumentation and measurement techniques related to his research. A project on an energy recovery system for HVAC applications in which he became involved as a research engineer at the University of Saskatchewan (Canada, 2009–2012) was jointly patented by the University of Saskatchewan and Venmar CES Inc (Canada). He is a reviewer for the ASME International Journal of Heat Mass Transfer. He received a C2 rating from the NRF.
Emeritus Professor Malherbe is a senior research fellow in the Centre for the Advancement of Scholarship. He has an office in the Department of Physics and is Head of the Laboratory for Microscopy and Microanalysis. In recent years, his main research area has been new materials used in energy production, in particular in the nuclear industry. This research is focused on developing materials to coat the fuel or fuel containers with protective layers to contain the radioactive fission products within the fuel, thereby preventing radioactivity from escaping into the environment during accident conditions, such as those that occurred at Fukushima and Chernobyl. This means that the research he and his students conduct is aimed specifically at the diffusion barrier properties of the coating layers and the chemical and physical interaction between the layers and fission products. They also investigate the radiation hardness of the layers. Recently his group started growing new materials and investigating their adhesion properties.
A review paper that was written by Professor Malherbe on diffusion and radiation damage in silicon carbide was published in the Journal of Physics D: Applied Physics and was chosen as one of the ten best papers published in that journal in 2013. He received a B2 rating from the NRF.


Dr Gazi Mahmood
Professor Johan Malherbe
Professor Vinesh Maharaj



Dr Mans is a senior lecturer in the Department of Medical Virology in the Faculty of Health Sciences. She conducted her doctoral studies in the Laboratory of Immunology, the National Institute of Allergy and Infectious Diseases and the National Institutes of Health in the USA and was awarded a PhD degree by the University of the Witwatersrand in 2008.
Her research interests include virus epidemiology, virus-host interactions, enteric viruses and environmental virology. Her postdoctoral research involved the establishment of a programme on human noroviruses at UP to generate data on the diversity of noroviruses in the clinical setting and environment in South Africa. Since 2010 she has published nine papers in ISI-rated journals, and in 2014 she reported the characterisation of novel norovirus recombinants in South African children with severe gastroenteritis. She participates in national and international norovirus surveillance initiatives and is involved in postgraduate student supervision. Dr Mans received a Y2 rating from the NRF.
Professor Medlen is a research mentor in the Faculty of Health Sciences. The research she conducted in the departments of Immunology and Pharmacology was focused mainly on drug development. From 1999 until 2010 she led a research consortium supported by the Cancer Association of South Africa (CANSA), the Technology and Human Resources for Industry Programme (THRIP) and the Biotechnology Partnership and Development (BioPAD). This research consortium included five South African universities and identified various lead compounds that were patented.
Professor Medlen developed two drugs that are currently on the market. One of these was patented and is used for the topical treatment of wounds, whereas the second is used systemically for the treatment of inflammatory conditions such as rheumatoid arthritis and osteoarthritis. Her consortium received Best Project awards from THRIP in 2002 and 2010. She received a C2 rating from the NRF.
Dr Morar-Leather has been a researcher in the Department of Veterinary Tropical Diseases in the Faculty of Veterinary Science since 2003. In 2014 she was appointed as a senior lecturer.
Her research interests include the development of diagnostic tools for the early detection of Mycobacterium bovis and M. tuberculosis infections in wildlife species. To date this work has led to the development of assays for diagnosing TB in rhinoceros, elephant and lion. These assays can be applied during surveillance and offer the potential for commercialisation.
Dr Morar-Leather presented her research findings at a number of international conferences and published two papers as first author in international peerreviewed journals in the past five years. One of her recent achievements is a study that determined the cut-off value for a negative test result by sampling 52 clinically healthy rhinoceros from two different areas in South Africa. At Faculty Day 2014, she received the Best Scientific Poster award for her work titled ‘Generation of white rhinoceros (Ceratotherium simum) IFN-γ specific recombinant chicken antibodies and their use in the rhinoceros IFN-γ assay for diagnosis of Mycobacterium bovis infection’. Dr Morar-Leather received a Y2 rating from the NRF.
Professor Connie Medlen
Dr Darshana Morar-Leather
Dr Janet Mans
Dr Naidoo is a senior lecturer in the Department of Genetics in the Faculty of Natural and Agricultural Sciences and the programme leader of the research group on Eucalyptus and pine pathogen interactions (EPPI) in the Forestry and Agricultural Biotechnology Institute (FABI). Her research focus in the Forest Molecular Genetics Programme is on determining the defence response of Eucalyptus and Pinus spp to pests and pathogens such as Leptocybe invasa, Chrysoporthe austroafricana, Phytophthora cinnamomi, Puccinia psidii and Fusarium circinatum, which is achieved via insight gained from genomic resources for Eucalyptus grandis and Pinus patula. These resources, coupled with reliable pathosystems, provide the platform for uncovering broad-spectrum and novel defence mechanisms for the development of genotypes with enhanced resistance by way of breeding programmes or future genetic manipulation.
Dr Naidoo, who receives funding via the NRF Thuthuka Women in Science Programme, was recently awarded a Forestry Sector Innovation Fund for research on Eucalyptus tree defence strategies, and is a co-investigator in the Department of Science and Technology’s project, ‘The Eucalyptus genomics platform: tree genomics and biotechnology for wood fibre, bioenergy and biomaterials’. She was elected secretary of the South African Genetics Society for the period 2015–2016. Dr Naidoo received a Y2 rating from the NRF.

Professor Nel is a professor in the Department of Marketing Management in the Faculty of Economic and Management Sciences. Through his research he aims to find the answer to the question: ‘What affects the long-term growth of global brands?’ Global brands contribute to corporate profitability by growing the brands’ financial value. The purpose of the research is to investigate how varying industry and firm effects explain the performance of global brand value growth across global regions. Multilevel modelling makes it possible to capture brand value performance at defined time periods (random intercepts) and rate of change over multiple years (random slopes). The research uses resourcebased theory to explain the impact of region on global brand value.
His research further investigates the influence of social media on brands. Brands are viewed as conversations in social media, where favourable comments improve the visibility of the brand and lead to eventual gains in brand value. Chernoff faces are used to portray multidimensional data to track the brand’s performance in a social media context. This research was acknowledged at the Australia and New Zealand Academy of Marketing Conference, where he was the recipient of a Best Paper award on the social media track in December 2012. Professor Nel received a C3 rating from the NRF.
Professor Nel is an extraordinary professor in the Department of Practical Theology in the Faculty of Theology.
During his academic career of 34 years, he specialised in Youth Ministry, Christian Education, Congregational Studies and Evangelism. More recently his research has been focused on developing missional congregations and discipleship in youth ministry that can be linked directly. He made a pioneering contribution in the field of continued theological training for pastors and founded (in 1992) the Centre for Contextual Ministry, which is central to the Faculty of Theology’s community and academic services.
In 2012 and 2013 Professor Nel spent seven months as a visiting scholar in Tübingen, Germany and Princeton, NJ, USA. He subsequently revised two of his academic books, namely Gemeentebou (Building the congregation) and Jeugbediening (Youth ministry) which were both translated into English. The revised English translation of Gemeentebou, titled Identity-driven churches: who are we and where are we going? was published in 2015. At a meeting of the International Association for the Study of Youth Ministry (of which he was co-founder and is currently an honorary president), In January 2015 Professor Nel presented a lecture titled, ‘Imagine making disciples in youth ministry … who will make disciples!’ He is the local organiser of the International Academy of Practical Theology, that will meet in Pretoria in July 2015. Professor Nel received a C3 rating from the NRF.


Professor Deon Nel
Professor Malan Nel
Dr Sanushka Naidoo



Professor Nicol is a professor in the Department of Chemical Engineering in the Faculty of Engineering, Built Environment and Information Technology. He joined the University in 2001 and established the Reaction Engineering Group within the Department of Chemical Engineering. The group developed into an internationally recognised facility for their work on multiphase reactor hydrodynamics. After a decade of active research the group was transformed into the Bioreaction Engineering Group, which focuses primarily on the fermentation of industrial bulk chemicals.
Professor Nicol is author of more than 50 international peer reviewed publications with a Scopus H-factor of 10. In 2012 he received the South African Institute of Chemical Engineers Innovation Award for his work on trickle-bed hydrodynamics. He is passionate about teaching, especially when it relates to the role of micro-organisms in the chemical industry of tomorrow. He received a B3 rating from the NRF.
Professor Nicolson is attached to the Department of Zoology and Entomology in the Faculty of Natural and Agricultural Sciences, where she researches the physiological aspects of pollination biology with a focus on sunbirds and honeybees. Her recent and current research includes an investigation of the nutritional value of nectar and pollen, the regulation of honeybee nutrient intake during stress, the osmotic and energy challenges faced by birds drinking diluted nectars, and the effect of plant toxins in nectar and pollen on pollinators. Professor Nicolson has published two books and more than 150 papers in peer-reviewed journals, mainly in association with postgraduate students and postdoctoral fellows. The first book, Chown & Nicolson (2004) Insect physiological ecology: mechanisms and patterns, won the Bill Venter/Altron Book Award. The second, of which she was the co-editor, is titled Nectaries and nectar (2007). She received a gold medal from the Zoological Society of Southern Africa in 2010, and the Chancellor’s Award for Research from the University of Pretoria in 2013. She received a B1 rating from the NRF.
Dr Nolte is a lecturer in the Department of Physiology (Division: Biokinetics and Sport Science) in the Faculty of Health Sciences. Her specific research areas include exercise therapy in the treatment of rheumatic conditions, applied biomechanics and how it relates to biokinetics and sport science, and prohibited substances in sport.
In 2012 she received a research grant from the World Anti-doping Agency (WADA) for her research on the relationship in South African athletes between mindfulness, psychological well-being, goal orientation and the propensity to use ergogenic aids (both legal and illegal). In the same year she received funding from the University Research Development Programme (RDP) to investigate the efficacy of exercise therapy in the treatment of ankylosing spondylitis (AS) and the biomechanical consequences of this disease. The research that she conducted for her doctorate led to a request to contribute to a Routledge textbook on ergonomics in sport and exercise, titled Three dimensional musculoskeletal modelling of resistance training exercises, which was published in 2013. Dr Nolte received a Y2 rating from the NRF.
Professor Sue Nicolson
Dr Kim Nolte
Professor Willie Nicol
Professor Olivier is a professor of Computer Science in the Department of Computer Science in the Faculty of Engineering, Built Environment and Information Technology. His qualifications include MSc and PhD degrees in Computer Science, a BSc(Hons) degree in Philosophy and an MPhil in Workplace Ethics. He is also a certified cyber forensic practitioner (CCFP) of the International Information Systems Security Certification Consortium (ISC)2. His current research is focused exclusively on digital forensics and is aimed more specifically at providing a suitable scientific basis for digital forensics and promoting greater scientific accountability in the forensic sciences. At a systems level he is particularly interested in database forensics.
The contexts in which these roles are fulfilled include membership of the initial task team that designed the (ISC)2 CCFP curriculum in South Korea (and subsequently developed it in the USA). He is an associate member of the Digital and Multimedia Evidence section of the American Academy of Forensic Sciences, has been an active member of the International Federation for Information Processing (IFIP) Working Group (WG) 11.9 (the IFIP TC 11 group focused on digital forensics) since its establishment in 2005 and acted as programme co-chair for their second meeting in 2006, and is a member of the Association for Computing Machinery (ACM) and the Suid-Afrikaanse Akademie vir Wetenskap en Kuns. Professor Olivier received a C1 rating from the NRF.

Professor Penzhorn, who has been an NRF-rated researcher since 1985, is a senior research fellow in the Centre for the Advancement of Scholarship. Being primarily interested in tick-transmitted blood parasites of dogs, cats and wildlife, he is a member of a well-focused, productive research group in the Department of Veterinary Tropical Diseases (DVTD) in the Faculty of Veterinary Science. The research group has many collaborators locally and abroad. Since 2011 he has been invited annually to participate in the Canine Vector-borne Diseases World Forum. He was appointed a research associate at the National Zoological Gardens in 2014. He received a B3 rating from the NRF.

Professor Petzer is a professor in the Department of Marketing Management in the Faculty of Economic and Management Sciences. The areas in which his research is focused include services marketing, more specifically the building, maintaining and restoring of relationships with customers in the service sector, and consumer behaviour, with an emphasis on consumers’ attitudes towards marketing phenomena, trends and developments.
Professor Petzer is the author or co-author of a number of articles published in international journals, such as the Journal of Services Marketing and the International Journal of Quality and Services Sciences. He has published articles in several local journals, including Management Dynamics and the South African Journal of Economic and Management Sciences, and has made numerous contributions to textbooks. He is a section editor for the South African Journal of Economic and Management Sciences and the associate editor for Africa on the topic of service management for the European Business Review. He regularly presents papers at national and international conferences and has supervised several master’s and doctoral candidates who conducted research in the field of marketing management. Professor Petzer received a C2 rating from the NRF.

Professor Banie Penzhorn
Professor Danie Petzer
Professor Martin Olivier



Professor Pietersen, an extraordinary professor in the Department of Microbiology and Plant Pathology in the Faculty of Natural and Agricultural Sciences, is on secondment from the Agricultural Research Council’s Plant Protection Research Institute in terms of a memorandum of understanding. He is a plant virologist with extensive experience in the diagnosis and control of viruses. His research programme focuses primarily on controlling grapevine leafroll disease, the most important virus disease affecting grapevines, and the most important viral and bacterial diseases affecting citrus, namely the citrus tristeza virus and citrus greening disease.
His studies on the spatial spread of grapevine leafroll disease in South Africa resulted in the development of control strategies to mitigate spread mechanisms. These were incorporated and implemented in the South African Grapevine Improvement Scheme over the past eight years. An implementation model was established at the Vergelegen Wine Estate to demonstrate the success achieved in controlling grapevine leafroll. The programme has been adopted by the New Zealand Winegrowers (NZW) in collaboration with Professor Pietersen. Citrus greening disease is a problem in the cooler citrus-production areas of South Africa. Professor Pietersen’s laboratory conducts studies on indigenous members of the citrus family to find the source of infection. In this process the entire genome of Candidatus liberibacter africanus (Laf) was determined in collaboration with researchers from the Agricultural Research Service (ARS) of the United States Department of Agriculture (USDA). He received a C1 rating from the NRF.
Professor Pillay is a professor in and Head of the Department of Chemical Pathology at UP and the National Health Laboratory Service at Steve Biko Academic Hospital, and Director of the Section of Clinical Pathology in the Faculty of Health Sciences. Prof Pillay graduated with a MBChB degree cum laude from the University of Natal. He also holds a PhD in biochemistry from Cambridge University as well as being a Fellow of the Royal College of Pathologists, London. He completed postdoctoral training at the University of California, San Diego. Professor Pillay’s research covers both basic and clinical science. In terms of basic research, he has focused on the molecular cell biology of insulin signalling, the cell biology of insulin resistance and molecular modelling of drug-receptor complexes, whereas his clinical research interests are in the domain of clinical chemistry.
In 2013 he received the Senior Researcher award from the South African Association for Clinical Biochemistry for his work on mechanisms of insulin resistance induced by protease inhibitors. He is the discipline editor for the Journal of Clinical Pathology and in 2013 he was elected to the corporate executive committee of the publication division of the International Federation of Clinical Chemistry and Laboratory medicine (IFCC). He also serves as editor of the IFCC’s eNews. During a worldwide selection process in 2013 he was elected to the international committee of the Royal College of Pathologists, London. He produced the first digital interactive textbook for the Apple platform from South Africa in 2014. He received a C2 rating from the NRF.
Professor Pirk is a professor in the Department of Zoology and Entomology in the Faculty of Natural and Agricultural Sciences. His research focuses on the behavioural and chemical ecology of social insects, in particular honeybees. He is involved in international networks with an interest in pollinator and honeybee health and collaborates with colleagues in Europe, Asia, America and Africa.
He has written more than 75 peer-reviewed articles published in journals such as Proceedings of the National Academy of Sciences (PNAS), Ecology Letters and Nature Genetics. In 2014 he collaborated with two colleagues to publish a book on honeybee hives and wax. He provides a base for students interested in behaviour, chemical ecology, mathematical modelling, nutrition and social insects. He currently supervises eight PhD, four MSc and three honours students. His h-index is 19. Professor Pirk received a C1 rating from the NRF.
Professor Tahir Pillay
Professor Christian Pirk
Professor Gerhard Pietersen
Professor Potgieter is an associate professor in the Department of Chemistry and the Deputy Dean responsible for teaching and learning in the Faculty of Natural and Agricultural Sciences. Her research interests include effective instruction in tertiary science, academic development and student success. She is recognised for her contribution to assessing and describing entry-level proficiencies of chemistry students, learning gain and the early identification of students at risk of failing.
She has studied factors influencing student performance, such as under-preparedness, overconfidence and adjustment issues. Her current work focuses on metacognition and self-regulation, two non-cognitive attributes that are key drivers for academic success.
Her achievements were recognised nationally when she was awarded the South African Chemical Institute’s Chemical Education medal in 2008 and a HELTASA award for Excellence in Teaching and Learning in 2011. She received a C2 rating from the NRF.

Professor Pouris is the director of the Institute for Technological Innovation in the Faculty of Engineering, Built Environment and Information Technology. He directs his research on issues of quantitative studies of science and technology, scientometrics, evaluations and international benchmarking. He has more than 80 publications indexed in the citation indices of Thomson Reuters. He has been nominated for the Derek de Solla Price Award 2015. The medal is the premier international award of excellence in scientometrics and related fields. Prof Pouris received the C2-rating from the NRF.

Dr Ramond is a Research Fellow in the Department of Genetics in the Faculty of Natural and Agricultural Sciences. A trained microbial ecologist, he graduated with a PhD from the Université de Rouen in France in 2008, after which he gained postdoctoral experience on microbial adaptation to various biotic and/or abiotic stresses and the potential use of microbial communities in bioremediation processes at the University of the Western Cape. Since joining UP, he has continued his research at the Centre for Microbial Ecology and Genomics, where he currently leads/coordinates the Namib Desert Microbial Ecology Research Programme. To date he has published more than 20 peer-reviewed research articles, as well as chapters in books. He received a Y2 rating from the NRF.

Professor Anastassios Pouris
Dr Jean-Baptiste Ramond
Professor Marietjie Potgieter



Professor Rautenbach is an associate professor in the Meteorology Unit of the Department of Geography, Geoinformatics and Meteorology (GGM) in the Faculty of Natural and Agricultural Sciences and currently oversees the Laboratory for Atmospheric Studies (LAS) at UP. His area of research is meteorology, with the emphasis on the modelling of short-term prognoses in the atmospheric system and the influence of fine-resolution surface forcing on atmospheric circulation and associated processes.
He is the coordinator of the Meteorology Unit, which is the only unit in southern Africa that offers degree programmes in meteorology. He was the Head of the Department of GGM from 2008 to 2014, and Director of the UP Water Institute from 2013 to 2015. With support received from industry (Eskom and Sasol) and the South African Weather Service (SAWS), he recently established a Laboratory for Atmospheric Studies (LAS), which will function as a national facility for research on atmospheric circulation, atmospheric processes and sustainable air quality. Over the past five years he has been collaborating with various international scientists to conduct research using some of the world’s most sophisticated atmospheric models. Professor Rautenbach received a C2 rating from the NRF.
Professor Reva is an associate professor in the Bioinformatics and Computational Biology Unit in the Department of Biochemistry, Faculty of Natural and Agricultural Sciences and the Vice-President of the Bioinformatics Society of South Africa (SASBi). His research interests are the development of new biostatistical algorithms and computer programmes for functional genomics, next-generation-sequencing (NGS) data analysis, metagenomics, genome linguistics, genetic barcoding, metabarcoding and biotechnology. A number of computational tools and databases were developed under Professor Reva’s supervision. He gives lectures on bioinformatics to postgraduate students and also organises lectures and training workshops on general bioinformatics and phylogenetics for South African and international students under the auspices of CE at UP.
He has published 77 papers and has been cited 1 220 times. He supervised or co-supervised eight PhD and six MSc students and is involved in joint research on biotechnology with German and Tanzanian colleagues. Their latest research project involves the use of NGS-based genetic barcoding of bacterial species and specific biological activities of micro-organisms that are important for biotechnology. Extended collaboration resulting in multiple joint publications was established with Rhodes University, the University of the Free State, Bielefeld University in Germany, the Institute of Catalysis in Madrid, the German private biotechnological company ABiTEP in Berlin, the Institute of Microbiology and Virology in Kiev, Ukraine, and the Institute of Anti-infectious Drugs in Almaty, Kazakhstan. He holds a C2 rating from the NRF.
Professor Robertson is an associate professor in the Department of Zoology and Entomology in the Faculty of Natural and Agricultural Sciences. One of his main interests is research on the factors that limit species distribution and the prediction of potential distributions of species by using species distribution models. These models, which utilise distribution records and environmental predictor variables to derive species–environment relationships that are used to predict the potential distribution of individual species, are particularly useful in understanding biological invasions.
Another of his research interests involves assessing the impacts of invasive organisms on biodiversity. He is interested in insect diversity and how this changes across environmental gradients. He is currently investigating ant diversity patterns across an elevational gradient in the Maloti-Drakensberg mountains. He is an associate editor for the journal Diversity and Distributions. He received a C2 rating from the NRF.
Professor Oleg Reva
Professor Mark Robertson
Professor Hannes Rautenbach
Professor Roduner is a visiting professor in the Department of Chemistry in the Faculty of Natural and Agricultural Sciences. His broad research interests in physical chemistry include studies of the structure, size-effects and magnetism of platinum nano-clusters, mechanisms of elementary steps in catalysis, kinetic isotope effects, degradation and the proton conductivity of fuel cell polymer membranes. His present focus is on alternative chemical energy research, in particular on the use of solar energy to convert CO2 to liquid fuels. He has written more than 250 scientific papers and an advanced textbook, titled Nanoscopic materials: size-dependent phenomena and growth principles (Royal Society of Chemistry, 2014). Professor Roduner received a B1 rating from the NRF.

Professor Rohwer is the Head of the Department of Chemistry and leads its Mass Spectrometry and Chromatography Laboratory. His research focuses on the use of chromatography, mass spectrometry and laser spectroscopy to establish the chemical composition of complex mixtures. This is done to address research problems in fields ranging from engineering, biology, geology and archaeology to forensic, environmental and food sciences. He recently initiated a long-term project aimed at converting sunlight and carbon dioxide (CO2) into liquid fuels. For him the greatest challenge is to design new instrumentation and develop customised analytical methods to research pheromone communication in insects, environmental pollution, wine aroma and natural gas composition. The last-mentioned contributed to a new hypothesis on the origin of the so-called fairy circles of Namibia.
The Mass Spectrometry and Chromatography Laboratory is supported by Sasol as a strategic national asset. Professor Rohwer is the South African representative in the International Mass Spectrometry Foundation (IMSF) and served on the South African team that negotiated the detailed terms of the international Stockholm Convention on Persistent Organic Pollutants (POPs), which focused on man-made toxic compounds in the environment. He is the recipient of two UP Exceptional Academic Achiever awards. He received a B2 rating from the NRF.
Professor Roux is an emeritus professor and senior research fellow in the Department of Genetics in the Faculty of Natural and Agricultural Sciences.
He obtained his BSc(Agric) and MSc degrees in Genetics at Stellenbosch University and completed his PhD in Animal Breeding and Statistics at Iowa State University, USA in 1969. His PhD thesis led to a paper in ‘Theoretical population biology’ in 1974 and was described as ‘elegant, very powerful and a notable contribution’ to the topic of selection across many gene loci.
He was employed as a researcher at the former Animal and Dairy Science Research Institute in Irene from 1969 to 1990, and the theoretical research on animal growth and efficiency that he conducted during that period had considerable applications in nutritional research. He served as a professor in the Department of Genetics at the University of Pretoria from 1991 to 2002, after which he was an extraordinary professor until 2012.
In the course of his career he was invited to various international congresses, was a member of several committees and associations, and served on both local and international editorial boards in his field of expertise. He is an honorary member of the South African Society for Animal Science and in 2014 he was awarded the Society’s gold medal in acknowledgement of ‘exceptional services rendered in furtherance of animal science’. Professor Roux received a C2 rating from the NRF.


Professor Egmont Rohwer
Professor Carl Roux
Professor Emil Roduner



Professor Sauer joined the University of Pretoria in 1974. He is an (emeritus) extraoardinary professor in the Department of Mathematics and Applied Mathematics in the Faculty of Natural and Agricultural Sciences and Senior Research Fellow in the Centre for the Advancement of Scholarship.
His main research achievements are the establishment of a mathematical theory of intertwined evolution processes, the introduction of the basic notions of interactions between fluids and non-fluid interfaces and finally, at the ripe old age of 76, a revision of the theory of sound. For all these innovative research ventures he established a number of new mathematical notions and ideas. He has been an NRF-rated researcher since 1986 and his latest NRF rating is C3.
Professor Selyshchev teaches in the Department of Physics in the Faculty of Natural and Agricultural Sciences, where he specialises in theoretical physics, specifically complex non-linear systems and their evolution, with a focus on kinetic non-linear processes in materials under irradiation. He has developed a theoretical approach to the self-organisation phenomena in irradiated materials. His research, which is focused on the temporal and spatial self-organisation of defect density under irradiation, dimensional changes in irradiated materials as dissipative structures and different kinds of interaction as mechanisms of dissipative structure formation, is aimed at the renovation of structural characteristics of materials, taking into account non-linear feedbacks between elements of microstructure and selecting suitable irradiation conditions. This allows for the selection of optimal conditions for the minimisation of radiation damage and the limitation of the negative effects of irradiation.
He has published more than 250 scientific papers and several monographs. Professor Selyshchev received a C3 rating from the NRF.
Professor Skelton is a professor in the Faculty of Law and the Director of the Centre for Child Law, which is a specialised law clinic. She is also the incumbent of the United Nations Educational, Scientific and Cultural Organization (UNESCO) Chair in Education Law in Africa. She has published widely in the fields of child law, family law, education law, constitutional law, criminal justice and restorative justice. Prof Skelton was at the forefront of child law reform through her work on the SA Law Reform Commission, which culminated in the Child Justice Act 75 of 2008 and the Children’s Act 38 of 2005. She is an advocate who argues children’s rights issues in the superior courts in a wide range of public interest legal matters. Professor Skelton regularly attends expert meetings of United Nations bodies and speaks at international conferences. She was awarded the Honorary Worlds’s Childrens’ Prize in 2012. She received a B2 rating from the NRF.
Professor Pavel Selyshchev
Professor Ann Skelton
Professor Niko Sauer
Professor Slippers is a professor in Genetics and one of the research leaders of the Tree Protection Co-operative Programme and Centre of Excellence in Tree Health Biotechnology at the Forestry and Agricultural Biotechnology Institute (FABI).
His study of the ecology, evolution and management of insects and microorganisms that affect tree health includes systematics, invasion genetics, chemical ecology and biological control. He has published more than 160 papers, served as the editor of a book, written a number of chapters in books, and regularly contributes popular scientific articles. He has an h-index of 29 (ISI Web of Knowledge). Professor Slippers has acted as supervisor or co-supervisor for, and is currently supervising or co-supervising a number of postdoctoral researchers and 45 PhD and MSc students. He is a regular contributor to national and international congresses and an editor of Plant Pathology. He does broad reviews of papers for key journals in his field and serves on advisory teams in forestry pests and diseases in South Africa and abroad.
Being passionate about science development and the impact of science on society, he has been actively involved in the global Young Academy movement. He also leads the Future Africa initiative at the University of Pretoria, which recently launched the Africa Science Leadership Programme. Professor Slippers received a B1 rating from the NRF.

Dr Sole is a senior lecturer in the Department of Zoology and Entomology in the Faculty of Natural and Agricultural Sciences. Her research focuses on invertebrate biosystematics, conservation and southern African biogeography, in particular on dung beetles, lacewings and baboon spiders. She provides a basis for students interested in molecular systematics and phylogeographic studies thereby aiming to create an increased interest in and passion for invertebrates, systematics and, on a broader scale, the effects on southern Africa of past and present changes in climate and landscape. She collaborates extensively with researchers from North America, Asia and Europe, has published a number of articles in her field and contributed to two monographs. She currently acts as supervisor/co-supervisor to eight postgraduate students. She received a C2 rating from the NRF.

Professor Steenkamp is an associate professor in the Department of Microbiology and Plant Pathology and the Deputy Director of the DST-NRF Centre of Excellence in Tree Health Biotechnology at the University of Pretoria. She is a specialist in the field of the biology and evolution of the Gibberella fujikuroi species complex and her research on these fungi has culminated in more than 50 publications in international peer-reviewed journals.
Five PhD and 18 MSc students have graduated under her supervision or cosupervision. She has written or contributed to 65 peer-reviewed journal articles, has showcased her research as a keynote speaker at national conferences and has been invited to do presentations at international scientific meetings. In 2011 she received UP’s Exceptional Young Scientist award in recognition of her contributions to research and postgraduate education.
She currently serves on the management committee of UP’s Forestry and Agricultural Biotechnology Institute (FABI), which is the premier institute of its kind in the world, and on the councils of the Southern African Society for Systematic Biology and the South African Society for Microbiology. She is an associate editor of the ISI journal European Journal of Plant Pathology. Professor Steenkamp received a B3 rating from the NRF.

Dr Catherine Sole
Professor Emma Steenkamp
Professor Bernard Slippers



Professor Steenkamp is an associate professor in the Department of Pharmacology in the Faculty of Health Sciences, where she heads the Phytopharmacology Unit. In this unit, new therapies are sought from traditional plants as a biosource for pharmaceutical leads. The in vitro biological activity of plants as possible treatments for specific diseases is assessed. Bioassay-guided fractions of plants containing promising activity are followed by in vitro mechanistic and toxicological studies, which include screening for potential drug-herb interactions.
Over the past five years Professor Steenkamp has supervised 21 honours, eight master’s and three doctoral students. A total of 16 awards were bestowed on the Phytopharmacology Unit for best publications or presentations, including the Innovative Pharmaceutical Association South Africa (IPASA) award received at the World Congress of Basic and Clinical Pharmacology in 2014. Nationally Professor Steenkamp holds eminent positions as President of the Federation of South African Societies of Pathology, Vice-President of the Toxicology Society of South Africa and Vice-President of the South African Association of Basic and Clinical Pharmacology. Internationally she is the Director of Education of the International Association of Therapeutic Drug Monitoring and Clinical Toxicology, a member of the executive council of the International Federation of Clinical Chemistry and a former president of the African Federation of Clinical Chemistry. Professor Steenkamp received a C1 rating from the NRF.
Professor Steyn is associate professor in the Department of Plant Production and Soil Science in the Faculty of Natural and Agricultural Sciences.
He has a background in crop science and specialises in the agronomy and water requirements of field crops and medicinal plants. He is particularly interested in potatoes, about which he has developed specialised knowledge over the past 28 years. Collaboration has been established with several national and international research organisations and in the recent past formal links were established with scientists at Wageningen in the Netherlands. His current research is focused on the improvement of effective irrigation water management, more sustainable crop production practices and potato production in a changing climate.
Professor Steyn served as the president and is a fellow of the South African Society of Crop Production. He is a recognised irrigation expert and has presented irrigation management training in Egypt, India and Russia to agronomists from across the globe who are employed by a multinational processing company. He will attend the 2015 World Potato Congress in China as an invited speaker and will address delegates on the current status and future prospects of potato water productivity. Professor Steyn received a C1 rating from the NRF.
Professor Thompson is a professor of veterinary epidemiology in the Department of Production Animal Studies in the Faculty of Veterinary Science. His main area of research is the epidemiology of infectious diseases, in particular zoonotic diseases, at livestock–human and livestock–wildlife interfaces. These include important transboundary animal diseases such as Rift Valley fever, foot-and-mouth disease, Newcastle disease and brucellosis, and pathogens of food safety concern such as E coli and Salmonella
His background in production animal medicine explains his other field of interest, which is the application of epidemiology in commercial livestock production. He also collaborates in numerous other studies on a diverse range of species and assists with study design and data analysis. His publications have earned him the Faculty’s Researcher of the Year award three times in the past ten years. He received a C2 rating from the NRF.
Professor Martin Steyn
Professor Peter Thompson
Professor Vanessa Steenkamp
Dr Tshikalange is a senior lecturer and honours programme co-ordinator in the Department of Plant Science in the Faculty of Natural and Agricultural Sciences. His current areas of interest include research on selected ethno-botanical medicinal plants used traditionally in the treatment of sexually transmitted diseases (including HIV/Aids), oral pathogens and wild, edible plants.
He has published articles in peer-reviewed national and international journals, such as the South African Journal of Botany and the Journal of Ethnopharmacology and Evidence-based Complementary and Alternative Medicine, and has co-authored chapters in the book Medicinal plant research in Africa: pharmacology and chemistry. Several postgraduate students have completed their studies under his supervision. He received a Y2 rating from the NRF.

Professor Van der Merwe is an associate professor and Head of the Department of Informatics in the School of Information Technology. Informatics is a diverse and young discipline in which much of the research done still uses grounded theory to establish frameworks and methods to understand the discipline and to investigate the complexity of the use of technology in different domains. Informatics is also the field in which technology and people ‘meet’. In this unique field she focuses on the design of socio-technical solutions by researching enterprise architecture, data science and different theories that support the successful use of technology in organisations.
Her research interests include the design of systems using innovative and new approaches, such as crowd sourcing and content awareness. She is the founder and a former chair of the South African Institute of Electrical and Electronics Engineers (IEEE)’s Systems, Man and Cybernetics Society (SMCS) Chapter, a specialist editor of the South African Institute of Electrical Engineers (SAIEE) journal, Software Engineering track, and co-founder and past chair of the Enterprise Architecture Research Forum (EARF). Internationally she was involved in the proposal and acceptance of the IEEE Enterprise Engineering and Enterprise Architecture Technical Committee, where she still acts as co-chair. She received a C1 rating from the NRF.
Professor Van Eck heads the Department of Mercantile Law in the Faculty of Law. He specialises in the field of labour law and his research is focused mainly on labour dispute resolution mechanisms and the right of vulnerable worker categories to have their labour disputes resolved in specialised dispute-resolution forums. He is a prolific author of national and international peer-reviewed publications. Professor Van Eck received a C2 rating from the NRF.


Professor Alta van der Merwe
Professor Stefan van Eck
Dr Emmanuel Tshikalange



Professor Van Heerden is a professor in the Department of Economics in the Faculty of Economic and Management Sciences. He was head of the department from 1997 until the end of 2009.
Professor Van Heerden uses computable general equilibrium (CGE) models of the South African economy to simulate economic policy in order to determine how the various role players in the economy will be affected. He focuses mainly on environmental and energy policies and cooperates closely with the Centre of Policy Studies in Melbourne, Australia, which specialises in the modelling technique. He was part of a team that built a model for the Ugandan government to enable them to simulate the effect that the discovery of oil in that country would have on the national economy.
During the past year Professor Van Heerden undertook two major research projects for Eskom and the National Treasury. For Eskom he has for some time been measuring the effect of different electricity tariffs on households and business enterprises, as well as the changes that occur in the demand for various types of electricity when tariffs change. The work he undertook for the Treasury involved measuring the effects of the proposed carbon tax on the South African economy. He received a C2 rating from the NRF.
Professor Van Niekerk is an associate professor in the Department of Animal and Wildlife Sciences in the Faculty of Natural and Agricultural Sciences. His research is focused on the effect of ruminant supplementation on rumen productivity and animal performance, and the effect of various feed options for ruminants on the production of greenhouse gasses.
For his contribution to animal production in China, he received a medal from the Foreign Experts Bureau of the People’s Republic of China, which was awarded to him by the Chinese premier. The South African Society for Animal Science acknowledged his ‘exceptional meritorious and original research or extension work in furtherance of Animal Science’ in South Africa by awarding him a silver medal. He received a C2 rating from the NRF.
Professor Van Onselen is a research professor based in the Centre for the Advancement of Scholarship and linked to Faculty of Humanities. He works in the field of global social history. Currently his particular interest lies in the phenomena of crime-as-politics, as exemplified by issues of social banditry, and politics-as-crime, as manifested in the ways in which members of the political elite engage in criminal activities in order to facilitate the accumulation of corporate personal wealth as enabled through the processes of systemic corruption. Although these historically rooted problems occur in many parts of the world, they are particularly prominent themes in modern South African history.
Professor Van Onselen has been an A1-rated historian for the past fifteen years. Among the books he authored and published during this period are The fox & the flies (London, 2008), the biography of Joseph Silver, an international whiteslave trafficker, and Masked Raiders: Irish banditry in Southern Africa, 1880–1899 (Cape Town, 2011). His most recent book is Showdown at the Red Lion: the life and times of Jack McLoughlin, 1859–1910 (Cape Town, 2015). He is currently researching and writing a book on the Jameson Raid of 1895-1896. Professor van Onselen received an A1 rating from the NRF (2015–2020).
Professor Willem van Niekerk
Professor Charles van Onselen
Professor Jan van Heerden
Professor Van Oort is an extraordinary professor in the Department of Church History in the Faculty of Theology. His areas of research are the rise of Christianity in the Jewish, Greek and Roman contexts; the history of the Early Church, with particular emphasis on Gnostic movements; and the theology, sources and influence of Augustine of Hippo.
Professor Van Oort authored some 25 books and numerous articles. He is editor of the UNESCO-funded project Corpus Fontium Manichaeorum, the Nag Hammadi and Manichaean Studies and the patristic journal Vigiliae Christianae, among others. Professor Van Oort received an A2 rating from the NRF.

Professor Van Vuuren is a professor in Entrepreneurship in the Faculty of Economic and Management Sciences. Apart from entrepreneurship, his broad field of specialisation is small business management. In his research, he specialises in the fields of entrepreneurship training, small business management, small business mentorship and entrepreneurship in established corporations and corporate entrepreneurship.
He has supervised 15 PhD candidates and numerous master’s students. His articles have been published widely in several journals and he has presented conference papers at entrepreneurship conferences all over the world. He has lectured in the Netherlands, New Zealand and USA. Since 1990 he has been actively involved in the development of small businesses across South Africa. In 2014 he was the course leader for a training programme in which 10 000 cooperatives participated. Professor Van Vuuren received a C2 rating from the NRF.

Professor Van Vuuren is a professor in and Acting Head of the Department of Veterinary Tropical Diseases in the Faculty of Veterinary Science. He is a veterinarian by profession and is registered with the South African Veterinary Council as a specialist in veterinary microbiology. His areas of research include viral diseases of importance in the livestock–wildlife interface and resistance to antimicrobial drugs.
With regard to interface diseases, he has a particular interest in malignant catarrhal fever and is currently collaborating with research partners in the United Kingdom on the safety and efficacy of a vaccine for use in cattle. He supervises several postgraduate students who are involved in research projects on various aspects of bacterial resistance to antimicrobial drugs in both animal bacteria and bacteria of importance in the human–animal interface. He received the Researcher of Year award from the Faculty of Veterinary Science in 2012, and has been an NRF-rated researcher since 2003. Professor Van Vuuren received a C3 rating from the NRF.

Professor Jurie van Vuuren
Professor Moritz van Vuuren
Professor Johannes van Oort



Professor Verschoor is a professor in the Department of Biochemistry in the Faculty of Natural and Agricultural Sciences. Since 1994 his research, which is focused on understanding the immunochemistry of mycobacterial cell wall mycolic acids in tuberculosis (TB), has led to 18 scientific research papers and seven peer-reviewed international patent applications related to the diagnosis, prevention and treatment of TB. He was awarded the first prize in on The Innovation Hub GAP Biosciences 2013 business plan competition and subsequently established a university start-up company, MARTI TB Diagnostics. He also won The Gauteng Biosciences Innovation Hub 2014 Biotech Fundi Lifetime Contribution award. His work aims to provide the means to diagnose extrapulmonary TB, and TB in human immunodeficiency virus (HIV) co-infected patients and children. It has also shown application potential for targeted anti-TB drug delivery, which may contribute to alleviating the threat posed by drug-resistant TB. He received a C2 rating from the NRF.
Professor Walwyn is a professor in Engineering and Technology Management in the Graduate School of Technology Management in the Faculty of Engineering, Built Environment and Information Technology. He completed a BSc degree in chemical engineering at the University of Cape Town and a PhD at Cambridge University, UK. His research interests cover science policy, research management, performance management in research and technology organisations, renewable energy and health economics. He currently teaches Research Methodology, but has also presented courses in innovation management, which covered the concept and application of national systems of innovation (NSI), funding and performance, the measurement of research and development, and the role/functions of actors within the NSI.
In the University of Pretoria’s Technology Management Programme he supervises at least ten master’s students each year, and is currently supervising two PhD students. He has published widely in research management, health sciences, performance indicators for research organisations and biotechnology. Professor Walwyn’s work has yielded one patent, 25 articles in peer-reviewed journals, three chapters in books and 30 conference papers and presentations.
He has worked as both an academic and a research manager in the private sector. His most significant contribution over the past ten years has been his work on research management and the pharmaceutical industry. Professor Walwyn received a C3 rating from the NRF.
Dr Wichmann, a senior lecturer in the School of Health Systems and Public Health in the Faculty of Health Sciences, is an environmental epidemiologist with a specific interest in the health effects of air pollution and climate change indicators. She gained international research experience at the Institute for Risk Assessment Sciences at Utrecht University in the Netherlands, the Karolinska Institute in Stockholm, Sweden, the International Agency for Cancer Research in Lyon, France, the University of Copenhagen, Denmark and the University of Gothenburg, Sweden. She received a C3 rating from the NRF.
Professor David Walwyn
Dr Janine Wichmann
Professor Jan Verschoor
Professor Wolff is a professor in the Department of Philosophy in the Faculty of Humanities. His current research is devoted to the development of an integrated theory on the technicity of human action. This theory is conceived as a hermeneutic anthropology of human capabilities and incapabilities. It is an ‘integrated’ theory in the sense that the theme of technicity is examined through all dimensions of human action (individual, interpersonal, organised and institutionalised) and in all spheres of human action (work, communication, recreation, politics, etc).
His current project, which is inspired by practical applicability, is characterised by the style and concerns of the broader phenomenological and hermeneutic movements, but also by the ambition to integrate insights from Social Theory. Professor Wolff received a research scholarship for advanced researchers from the Alexander von Humboldt Foundation for the period 2013–2014 and subsequently became an affiliate researcher at the Centre d’études de mouvements sociaux of the École des Hautes Etudes en Sciences Sociales (EHESS), Paris. Professor Wolff received a B3 rating from the NRF.

Professor Yadavalli is a professor and Head of the Department of Industrial and Systems Engineering in the Faculty of Engineering, Built Environment and Information Technology. He received his PhD degree from the Indian Institute of Technology in Chennai in 1983.
He has published more than 130 research papers on topics including reliability (both soft- and hardware), queuing, inventory and manpower planning in various international journals, such as IEEE Transactions on Reliability, International Journal of Production Economics, International Journal of Production Research, International Journal of Systems Science, Stochastic Analysis & Applications, International Journal of Reliability, Quality and Safety Engineering, Applied Mathematics & Computation, Annals of Operations Research and Computers & Industrial Engineering. He served on the editorial boards of various international journals and acted as supervisor to several master’s and doctoral students locally and abroad.
He is a past president of the Operations Research Society of South Africa and a fellow of the South African Statistical Association. He received a Distinguished Educator award from the Industrial Engineering and Operations Management Society in 2015. Professor Yadavalli received a C1 rating from the NRF.

Professor Sarma Yadavalli
Professor Ernst Wolff

tša Bao
Atlegilego
The evaluation and rating of individuals is based primarily on the quality of the research outputs of the past eight years (2007-2014) and is undertaken by national and international peers/reviewers.


Atlegilego